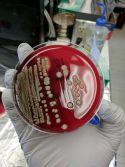

WHO’S WHO 2020

Pg 12
Ontario: Josh Mailloux p.14
Manitoba: Sandra Dyck p.24
Quebec: David Phaneuf p.36
Bev Whitta, Poultry in Motion
THAT’S JUST GOOD CHICKEN MATH
It’s simple arithmechick, whether you raise 4,000 chicks or 4 million. Victrio® is a preservative-free, antibiotic-free way to jump-start your chicks’ immune systems, preparing them to fight E. coli the natural way. Administered in-ovo at the hatchery, Victrio significantly reduces post-hatch mortality due to E. coli infection and supports your RWA production goals.
Ask your hatchery for Victrio chicks today. Learn more at Victrio.ca.






LISTINGS FOR: Health monitored hatcheries, registered egg stations, egg product stations, feed manufacturers, feed supplements, drugs, vaccines, etc., registered poultry stations, provincial associations, Department of Agriculutre and university officials, consulting veterinarians and agriculture representatives for banks.
listed in their respective provinces:

by Brett Ruffell
Poultry’s strongest enthusiasts
Many people in poultry are crediting supply
management with enabling the industry to quickly adapt to the sudden changes brought on by the pandemic.
While some hatching eggs had to be destroyed, at the time of going to print producers have still avoided having to conduct mass depopulations. This is because the system allows for a coordinated national response.
Another common theme I’ve heard is that the industry’s experience with the pandemic underscores the need for poultry to promote and protect supply management. And who better to take up that mantle than producers themselves?
Add to that the growing focus on educating more Canadians about their food and where it comes from and there’s never been a better time for poultry producers to raise their advocacy game. For inspiration, this year’s Who’s Who issue features some of poultry’s strongest proponents.
As is the case each year, this edition includes a collection of profiles of producers in the broiler, egg, hatching egg and turkey sectors from coast to coast. However, this time we’ve placed a special emphasis on advocacy.
Each of the producers fea-
tured in the pages ahead goes above and beyond to educate the public, share farmers’ concerns to government and, ultimately, support their industry. And they do so in unique ways.
For instance, B.C. chicken farmer Bev Whitta, featured on this year’s cover and profiled on page 12, takes an educational trailer around to schools and fairs to talk about chicken farming. Dubbed Poultry in Motion, the trailer displays live day-old chicks, broilers and breeders to teach people about the lifecycle.
“Consumers are the pillar of our industry and we want them to know the respectful, caring way chicken is raised in Canada, and that farmers are accountable and responsible for following all the regulations,” Whitta says.
There’s never been a better time for poultry producers to raise their advocacy game.
Then there’s Sandra Dyck, featured on page 24. The Manitoba egg farmer works with different organizations to host inner city youth, new Canadians and other groups on her farm. She explains the impact of these efforts: “They come to understand our farming practices and then they’re also advocates for us too.”
On the turkey side, there’s Alberta’s Darren Ference, who’s profiled on page 30. Apart from his important role as chair of Turkey Farmers of Canada, the producer lent his handyman skills to the cause. He built a miniature turkey farm for a nearby school’s Ag Learning Centre to help educate students. It comes complete with live birds and a feeding and drinking system.
“People need to see our passion and respect for the land and the animals,” Ference says. “We just have to be able to show people.”
Egg farmer Clinton Monchuk, who’s profiled on page 32, shares that sentiment. “What has to come across is showing that you care,” says Monchuk, who through his other role as executive director of Food & Farm Care Saskatchewan brings consumers closer to the farm. “I’ve never met a farmer who doesn’t care about their animals.”
I hope you’re inspired by the stories ahead, whether you’re a seasoned advocate or looking for ways to get involved for the first time. And if you’ve taken part in interesting efforts to educate the public and government, I’d love to hear about them.
I’m also eager to hear from you about next year’s Who’s Who issue, the theme of which is innovators. Are you aware of a producer who’s known for adopting cutting-edge technologies or management practices? Send me an email at bruffell@ annexbusinessmedia.com.
canadianpoultrymag.com
Editor Brett Ruffell bruffell@annexbusinessmedia.com 226-971-2133
Associate Publisher Catherine McDonald cmcdonald@annexbusinessmedia.com Cell: 289-921-6520
Account Coordinator
Alice Chen achen@annexbusinessmedia.com 416-510-5217
Media Designer Alison Keba
Circulation Manager
Anita Madden amadden@annexbusinessmedia.com 416-510-5183
VP Production/Group Publisher Diane Kleer dkleer@annexbusinessmedia.com
COO
Scott Jamieson sjamieson@annexbusinessmedia.com
PUBLICATION MAIL AGREEMENT #40065710
Printed in Canada ISSN 1703-2911
Circulation
email: rthava@annexbusinessmedia.com Tel: 416-442-5600 ext 3555 Fax: 416-510-6875 or 416-442-2191
Mail: 111 Gordon Baker Rd., Suite 400, Toronto, ON M2H 3R1
Subscription Rates
Canada – 1 Year $32.50 (plus applicable taxes)
USA – 1 Year $91.50 CDN
Foreign – 1 Year $103.50 CDN
GST - #867172652RT0001
Occasionally, Canadian Poultry Magazine will mail information on behalf of industry-related groups whose products and services we believe may be of interest to you. If you prefer not to receive this information, please contact our circulation department in any of the four ways listed above.
Annex Privacy Officer privacy@annexbusinessmedia.com Tel: 800-668-2374
No part of the editorial content of this publication may be reprinted without the publisher’s written permission. ©2020 Annex Publishing & Printing Inc. All rights reserved. Opinions expressed in this magazine are not necessarily those of the editor or the publisher. No liability is assumed for errors or omissions. All advertising is subject to the publisher’s approval. Such approval does not imply any endorsement of the products or services advertised. Publisher reserves the right to refuse advertising that does not meet the standards of the publication.









Build it and we will come.

























212 years of combined knowledge working for you.
As a global leader in the poultry industry, Lubing has been at the forefront of innovation since its inception in 1949. With more than 3 billion birds drinking from a Lubing system around the world, we have established a solid reputation for quality and reliability with products that give producers the advantage in production to maximize profits.
Let our experienced team work with you in designing the best system for your specific needs to gain the most out of your production.
Got Lubing? You can’t afford not to. Contact us to find out how we can help improve your bottom line.
Glass-Pac Canada
St. Jacobs, Ontario
Tel: (519) 664.3811
Fax: (519) 664.3003
Carstairs, Alberta
Tel: (403) 337-3767
Fax: (403) 337-3590
Les Equipments Avipor
Cowansville, Quebec
Tel: (450) 263.6222
Fax: (450) 263.9021
www.lubingusa.com info@lubingusa.com (423) 709-1000
www.lubingusa.com info@lubingusa.com (423) 709-1000




Specht-Canada Inc.
Stony Plain, Alberta
Tel: (780) 963.4795
Fax: (780) 963.5034



What’s Hatching
CUSMA trade deal comes into force
North America’s new trade agreement finally became the law of the land in early July, complete with a celebratory warning from the Trump administration that the U.S. intends to make sure Canada and Mexico live up to their end of the bargain. As part of the deal, the U.S. gets tariff-free access to Canada for 57,000 tonnes of chicken by the sixth year of the deal, and access for 10 million dozen U.S. eggs and egg equivalents. Poultry groups are still waiting for details of an industry investment fund to compensate their sectors for concessions made in this and other free trade agreements.
Dalhousie researchers using poultry for COVID-19 study
The Atlantic Poultry Research Centre on the Dalhousie Agricultural Campus has partnered with AffinityImmuno Inc, in Prince Edward Island, one of the first laboratories to manufacture antibodies against COVID-19. Following successful production of antibodies in chickens to COVID-19 spike proteins, a partner was needed who had the capacity to increase the number of chickens involved in the process in order to scale-up production. This is where Dalhousie’s Faculty of Agriculture stepped in.
B.C. broiler producers win Outstanding Young Farmers award
Due to COVID 19, the BC/YK Outstanding Young Farmers regional event was cancelled in March. But, the alumni recently announced the region’s 2020 winners, Raymond and Tracey Bredenhof, owners of R & T Poultry and Bredenhof Hop Farms located in Abbotsford, B.C. The farmers and their sons run a commercial broiler farm, R& T Poultry,.

Reusing chicken litter shows benefits, study finds
A new study shows that the environment in reused poultry litter can deter growth of pathogens like Salmonella.

from
“When you read or hear that broiler litter is reused to raise multiple flocks of chickens, the typical reaction is that it must be bad for food safety,” says Adelumola Oladeinde, a co-author of the recent study. “Our study demonstrates the exact opposite.”
Oladeinde is a researcher at the United States Department of Agriculture’s National Poultry Research Center in Athens, Ga. He and his colleagues found that ‘good’ bacteria in used poultry litter can hinder Salmonella growth.
“It may be worthwhile to invest time and resources to characterize the bacteria in reused litter,” he says. “We can develop the promising ones into beneficial microbes for better gut health.”
The study also explored litter characteristics, such as moisture
and ammonia levels. These characteristics can dramatically affect the litter microbiome – the mix of bacteria, fungi and viruses in litter.
“Our findings provide new information on the relationship between the physical environment of broiler litter and its microbiome,” Oladeinde says. “Management techniques that account for both factors may help reduce Salmonella in chickens.”
Chicken litter plays a big role in determining broiler health. After a broiler chick gets to a farm, it usually spends the next several weeks pecking and living on litter.
In fact, chicks begin to eat litter even before eating from feeding troughs or drinking. The microbiome present in the litter likely become the ‘first settlers’ in the guts of the chicks.
“These first microbes play a key role in determining gut health,” Oladeinde says.
Bacterial isolate from reused litter with competitive exclusion potential against Salmonella growing on sheep blood agar.
Eluate recovered
reused litter microcosm after extraction with glass beads and sieving through cheese cloth.
5 questions with Aviagen’s Marc de Beer
In April, Marc de Beer became Aviagen’s new president of North America. He’s charged with advancing the company’s longterm business strategy and strengthening service to customers throughout Canada and stateside. A poultry nutritionist by trade, he has extensive experience on both the breeder and nutrition sides of the industry. Canadian Poultry asked de Beer five questions.
Tell us about your background. I grew up in South Africa on the east coast in a sugar cane farming region. I studied animal science at Stellenbosch University, which is near Cape Town. And then I came to the U.S. about 17 years ago and went to the University of Arkansas, where I studied poultry science and became a nutritionist. That evolved into business roles through the years, starting at Aviagen and then DSM and onto Elanco. And then I came full circle back to Aviagen now.
How did you find working on the nutrition side and what brought you back?
Like I said, I’m a nutritionist by trade. I felt like, well, if I’m a nutritionist I should find out what it’s like working for a nutrition company. So, I spent a bit of time with DSM. It was nice having the technical background. That’s a bit of an advantage when you’re dealing in business when you have a good understanding of the underlying biological principles. But coming back, genetics plays such a central role. Just the relevance of it to our industry is really critical and that’s a nice place to be engaged in.
What is your first priority? Getting reengaged with all the people. Understanding exactly where everyone is and how they’re doing. I think the company plays an important role in the production system. So, I feel obligated to do a good job and make sure our products are of appropriate quality supplied when and where they’re needed. Aviagen has built an impressive organization. I just want to keep that going and keep developing.
Why did you choose poultry?
It kind of chose me over time. I chose animal science because I was fascinated with the natural world. I really wanted to be a game ranger. Once I got into it I realized there’s no lions, there’s no leopards, there’s no giraffes. This is chickens, pigs, cows and goats. Once I got into it and realized I was misguided in what I was getting into I turned my attention to deciding what was the best option from a career perspective. I chose poultry because of all the dynamics of global protein consumption. You think about all the restrictions you have on certain meats. Poultry doesn’t have that. This humble little chicken is doing incredible things to feed the world and at the time it seemed obvious to me that that would be the industry with the biggest opportunities for someone like me.
What is your proudest achievement thus far?
The things that have given me the most satisfaction is helping to build teams. Seeing teams perform better than they thought possible. Seeing individuals grow.
Coming Events
AUGUST
AUG. 12-13
MPF’s Virtual Trade Show & Convention midwestpoultry.com
AUG. 20
PIC’s Research Impacts, Webinar poultryindustrycouncil.ca
SEPTEMBER
SEPT. 2
PIC’s Annual Golf Tournament poultryindustrycouncil.ca
SEPT. 20

PIC’s Science in the Pub, Webinar poultryindustrycouncil.ca
OCTOBER
OCT. 15
PIC’s Poultry Health Day, Webinar poultryindustrycouncil.ca
OCT. 22
PIC’s Annual General Meeting poultryindustrycouncil.ca
NOVEMBER
NOV. 4-5
Canadian Poultry XPO poultryxpo.ca
NOV. 12
Eastern Ontario Poultry Conference, Webinar poultryindustrycouncil.ca
Marc de Beer is Aviagen’s president of North America.
What s Hatching

Ontario passes bill to protect farmers from trespassing animal rights activists
Ontario has passed legislation it says will protect farmers from animal rights activists who trespass on their property.
The controversial legislation – which the government introduced late last year – hikes fines for trespassing on farms and food-processing facilities and makes it illegal to obstruct trucks carrying farm animals.
Under the law, fines for trespassing will be set at a maximum of $15,000 for a first offence, compared to the previous maximum trespassing fines of $10,000.
Ontario’s agriculture minister Ernie Hardeman has said the bill will help ensure the security of the province’s food supply while also striking a balance that ensures the right to protest.
The bill has been applauded by farmers but roundly criticized by activists who say it targets them.
Activists say the new law will conceal animal cruelty at farms and slaughterhouses and interfere with lawful protests.
Before the bill was passed, the executive director of Animal
Justice told an all-party committee reviewing the legislation that it would be a step backwards for animal protection and was unconstitutional.
“We’ve seen this movie before and the lengthy court battle will waste taxpayer funds at a time when we’re going further into debt,” Camille Labchuk said.
Farmer groups, however, said livestock producers across all sectors are subject to strict rules and inspections in order to ensure animals are treated safely and humanely.
Ed Benjamins, chairman of the Chicken Farmers of Ontario, said his organization supports the measure and is concerned with what it sees as “disturbing trends” where activists trespass on farms.
“Existing laws have not been strong enough to protect our farms and our homes from the risk of invasion,” he said.
“Ontario chicken farmers expect that the same level of protection be afforded to their homes as are enforced for homes in urban and suburban Ontario.”
Turkey Farmers of Canada announces new charitable donation
Canada’s turkey farmers recently announced another $80,000 donation in the wake of COVID-19, which will support mental health initiatives across the country. The funds will be distributed to Kids Help Phone and 4-H Canada, two groups that each work to provide mental health-related resources and assistance to youth in rural communities. Since the pandemic started in mid-March, Kids Help Phone has experienced a continued increase in demand for service from young people all across Canada.

Ontario to spend $150M on rural broadband
The provincial government says it is working to help rural Ontarians get better connections in these unprecedented times. In early June, Premier Doug Ford announced a $150 million investment in cellular and broadband service, designed to improve cell phone and internet access in rural and remote areas of the province. This funding is part of Ontario’s $315 million “Up to Speed” initiative.
Two protesters get conditional discharge after Alberta turkey farm demonstration
Two of three people charged following a protest at a southern Alberta turkey farm have received conditional discharges in court. Maxwell Ming Mah of Edmonton and Claire Buchanan of Calgary were each facing one count of break and enter to commit mischief after the protest last September. Court records show they were sentenced in Lethbridge provincial court in early July.

Ernie Hardeman is Ontario’s minister of agriculture.


LRIC update
By Lilian Schaer, Livestock Research Innovation Corporation
Livestock
Advocacy key to advancing innovation

Advocacy is something most farm organizations are undertaking in some way, whether with government, consumers or other stakeholders. It can also be all of the above – or a combination of various target audiences, depending on the issue or the need.
When it comes to successful advocacy – also called lobbying when it involves working with government, or what is now commonly called government relations – by far one of the most important elements is the idea of building relationships with decision-makers.
That doesn’t just mean knowing who to call when there’s a crisis (although that’s helpful!) or only getting in touch to address a need in the sector. Rather, it involves a
thoughtful, sustained strategy that helps both sides get to know each other and build a level of trust and mutual respect.
Ontario’s poultry organizations are active advocates, both in speaking to consumers and cultivating and maintaining good government relations. For example, Egg Farmers of Ontario has long hosted an annual breakfast at Queen’s Park for MPPs and government staff, and Chicken Farmers of Ontario (CFO) holds an annual Chicken Day at Queen’s Park to highlight sector issues.
During last fall’s federal election, CFO ran an “I Support Local Chicken Farmers” campaign in various ridings across the province where farmers hosted on-farm tours for candidates. The goal was to help increase understand -
ing about chicken farming and raise awareness of the importance of the sector.
The poultry sector also has long-standing food bank donation programs and regularly steps up with additional support when needed, like during the current COVID-19 pandemic.
“These are all excellent ways to build understanding and help ensure that people know who we are and why we matter when we advocate for support on issues that affect the sector,” says LRIC CEO Mike McMorris.
Advocating for new poultry research facilities in Ontario is one such example. The aging structures currently being used by the University of Guelph at its research station in Arkell need to be replaced. Facilities need to reflect technological and manage -
ment advances in the sector, as well as accommodate new areas of research critical to the future success of poultry production, like automation, animal welfare and disease control and prevention.
“Good research is critical to be able to back up a specific position with facts and inform decision-making,” McMorris says. “Strong, local research infrastructure is a key component to support this kind of work.”
Another key element of successful advocacy is support from others along the supply chain. This includes building relationships with researchers, feed and animal health sectors, processors and even retail.
It’s important to hear other perspectives on key issues that matter to the sector, and sometimes there may need to be a bit of give and take to find a common “middle ground” that everyone can agree on or support.
According to McMorris, that’s where an organization like LRIC can play an important role. Due to its connections across the livestock and poultry sector and its supply chains, LRIC can identify areas of common interest and bring partners to the table to address cross-sectoral issues.
“Our key goal is driving innovation in the livestock and poultry sectors and one of the ways to do that is to be able to connect people, businesses and organizations who are facing a common problem or trying to solve a similar issue,” he says.

Industry advocates work booths at local fairs, present at schools, host open farm days, speak to media and more.


EDGE® gives you the freedom to be away from the farm while knowing you are only one touch or click away. Maintain complete control with EDGE®. The EDGE® Controller quickly identifies issues and responds with self-diagnostics, triple layer protection and instant notifications. Revolutionize your operation with the next generation of controls.
Bev Whitta
Promoting chicken with passion on Vancouver Island.
By Lilian Schaer
To tens of thousands of B.C. school children, fair goers and grocery shoppers, Bev Whitta is the face of chicken farming.
That’s thanks to the former educator’s role as coordinator of the industry’s Poultry in Motion program on Vancouver Island, as well as her ongoing willingness to talk about chicken farming to consumers at grocery stores and other events.
Whitta and her husband Brian have been chicken farmers near Nanoose Bay, just north of Nanaimo, since 1995. They first moved to their farm in 1979, when it was just land that needed clearing so it could be used for agriculture. Today, they farm with their son, raising feeder cattle in addition to broilers, and growing corn and forage crops.
Brian is a long-time director with the B.C. Chicken Growers Association and Bev devotes a lot of her time to outreach efforts on behalf of the industry.
It’s something she believes in very strongly to help Canadians get an accurate picture of where their food comes from.
“At one time, everybody knew a farmer and could do trips to the farm, but that has mostly changed. Now, they don’t have that way to learn about Canadian food production, and what’s on the internet is often not accurate or Canadian,” Whitta explains.
POULTRY IN MOTION
Poultry in Motion is an educational trailer developed by the B.C. Chicken Growers Association and B.C. Broiler Hatching Egg Producers’ Association that Whitta takes to schools and fairs to talk about chicken farming.
Three compartments on the trailer display live birds at different ages – day-old chicks, broilers and breeders – to demonstrate their life cycle. Each compartment is set up just as it is in a real barn with nesting boxes,

feed and water and a computer to control that inside environment. A separate table displays feed samples, a comparison of hatching eggs versus table eggs and printed materials for people to take home.
“When I go to schools, I talk about each compartment, the birds and the equipment – students love detail,” she says. “They’re focused and they listen to everything you say.”
During a school visit, students come out to the trailer by class throughout the day, but kids also come back at recess or lunch time with a clipboard to copy down information from her display. Some teachers also integrate the material into their classroom lessons.
“I get a lot of feedback from the teachers – that’s how I know the details are so important to the kids,” she says. “And when you’re talking to students, it’s like a mushrooming effect because they’re taking all this information home to their families so you’re also talking indirectly to their parents and grandparents.”
In addition to covering how birds are raised and
Bev Whitta is a chicken farmer and coordinator of the Poultry in Motion educational program on Vancouver Island.

what they eat, Whitta makes sure to highlight how chicken farmers practice respect in how they care for their birds and the rules that producers have to follow.
At the high school level, she also talks about supply management, the impact of trade agreements, career options in agriculture, food security and how to buy local. The use of antibiotics is a frequent topic that comes up too, so Whitta addresses different ways farmers keep barns clean to reduce germs, the science of feed and the role of good gut health.
Last year, Vancouver Island got its own Poultry in Motion trailer. Previously, Whitta just borrowed the trailer from Abbotsford. This has dramatically expanded the program’s reach. In 2019, Whitta visited 33 schools and spoke to more than 9,700 students.
“Bev has almost single handedly managed the Poultry in Motion educational program on Vancouver Island for years,” says Bill Vanderspek, executive director of the B.C. Chicken Marketing Board. “She has brought the story of the life cycle of the chicken to countless people at schools, country fairs and other events, and we are very fortunate to have such a passionate advocate for the B.C. chicken industry and Vancouver Island agriculture,”

IMPORTANT CONVERSATIONS
Another key part of her work is attending five island fairs with the exhibit. The largest is in Saanich and attracts about 50,000 visitors annually. People are naturally curious about the birds, but some also come with strong views about farming or eating meat, which makes it an ideal chance to have a conversation, Whitta believes.
“For me, that’s a must of a conversation, but it has to be done in a very gentle, respectful way by acknowledging what they say they know and being gentle and genuine. Most of the time you can move the conversation along to talk about our Canadian industry and you can see they’re listening to you and are taking it in –that’s very powerful,” she explains. “I don’t know if I convert anybody but as farmers, we can personalize that conversation to help people learn the true facts.”
The food service industry is keen to learn more about chicken production too, so when Cheryl Davie with the B.C. Chicken Marketing Board had a request from Sysco Victoria for a farm tour, she knew who to call. Forty chefs and restaurant owners visited the Whittas’ farm and the company reported a jump in new customers and a 10 per cent increase in sales after the tour.
“Bev is one of the strongest advocates for the broiler industry in B.C.,” Davie says. “When I need a farmer for an event, Bev is always there and gives 110 per cent.”
For Whitta, it comes down to making personal connections with consumers. She encourages fellow farmers to find ways to have those conversations too, like organizing a social event at a club or church if spending a day at a fair or going into a classroom isn’t something they’re comfortable doing.
“It doesn’t have to be a big thing; little things add up. Consumers are the pillar of our industry and we want them to know the respectful, caring way chicken is raised in Canada, and that farmers are accountable and responsible for following all the regulations.”
The Whittas produce broilers, raise feeder cattle, grow corn and forage crops.
Poultry in Motion is an educational trailer that Whitta takes to schools and fairs to talk about chicken farming.
Josh Mailloux
Turkey producer works to ensure the farmer’s voice is heard. By Lilian
Schaer
Josh Mailloux believes firmly that the farmer’s voice is a voice that deserves to be heard. That’s particularly true when it comes to taxation, land use and water issues – and it’s not always an easy task in a municipality dominated by a large urban centre nearby.
“Agriculture is important – we’ve seen empty shelves recently – and sometimes when you go to meetings, the people you speak to don’t realize what we do and how agriculture works,” Mailloux explains. “A lot of people who run government have little or no roots to the farm so you have to have a strong and consistent voice to properly convey things to them.”
Mailloux is vice president of the Essex County Federation of Agriculture (ECFA), as well as a representative on the Ontario Federation of Agriculture (OFA)’s Policy Advisory Council and a member of the local Grain Farmers of Ontario organization. He also sits on his municipality’s
committee of adjustments, which deals with land use and severance issues, a responsibility he’s had for the last 12 years.
“Land use is really important to me; there’s quite a divide between rural and urban and with urban areas spreading further out, planning is important,” he says. “They don’t make more land, so it’s good to have a voice at the table.”
Turkey farming legacy
Mailloux farms in partnership with his cousin Chad near Amherstburg, south of the border city of Windsor, where they raise turkeys, grow corn, soybeans and wheat on about 1,000 acres and also have a Pioneer seed business.
It’s a farm they took over from their fathers, cousins Bill and Leonard, seven years ago, who had also taken it over from their fathers a generation before.
And this year marks a big milestone for the family – 2020 is the 70th year since the Maillouxs first started raising turkeys on
their family farm, which has been in the family since the 1870s. Whether the next generation will continue the farming tradition is yet to be seen though – Josh’s daughter is 12 and his son is nine, and Chad’s son is only three.
The farm produces three flocks of heavy toms a year, birds that weigh 16 to 17 kilograms at market weight. They are destined for further processing, including turkey strips and deli meats for large chains like Subway and Tim Horton’s.
Needless to say, the COVID-19 pandemic has had a significant impact on demand, as restaurants across the country were reduced to take-out and delivery after being shuttered to in-store dining in March to reduce the spread of the disease.
The Maillouxs also raise one flock of small hens in the winter that grow to under five kilograms. That is to keep their brooder barn full of birds year-round instead of having it sit empty for periods of time.


Turkey producer Josh Mailloux (back row center), pictured here with cousin Chad and the next generation, voices farmers’ concerns to government through various organizations.
PHOTO: JOSH MAILLOUX
Chicken Farmers deliver on Public Trust

Canadians want Canadian chicken – They want it, because they know it stands for excellence in food safety, excellence in animal care, and a commitment to excellence in all aspects of sustainability.
As farmers, you deliver on this – you help to create and maintain public trust in our product.
The standards we uphold each day have an impact, and absolutely drive the credibility that chicken farmers have with consumers.
A family tradition
Mailloux comes by his involvement in farm organizations honestly. In fact, it’s become a bit of a family tradition.
His grandfather Eugene played a key role in establishing supply management for the turkey sector and served as chair of Turkey Farmers of Canada in 1976. His father Bill was on the board of Turkey Farmers of Ontario and spent almost a decade as vice chair of the national organization – roles he took on after many years as an executive member at OFA.
“When Dad went to OFA, I started to farm full-time when I was just over 20 and we essentially just farmed together on the weekends,” he says. “I started on the local board in my mid-20s It was following the tradition, but I had always read a lot about what they do too and how important it is.”
Essex County is quite a diverse area that includes the nearby city of Windsor and is home to Canada’s largest cluster of greenhouse production around Leamington. For farmers in the region, urban sprawl and rural land use, rising taxes and drainage are key issues. Mailloux brings those perspectives forward to the provincial level through his participation in the OFA’s Policy Advisory Council.
“Josh is a bright young guy with a strong legacy from his dad, but he’s also his own individual who is very thoughtful in dealing with issues,” says OFA president Keith Currie. “He’s very engaged in his own operation, but he also has a lot of experience and that’s very much needed.”
According to Currie, one of Mailloux’s additional assets for a lobby organization like OFA is that his seed business gives him an agricultural retail perspective and brings him into contact with many different farmers in the area.
“We work for all farmers so we need many different perspectives,” Currie adds. “It leads to a more balanced approach to the issues and that’s what Josh brings to the table.”
Mailloux also keeps busy with plenty of local advocacy activities in his role as vice president with ECFA.
Local issues
During the last federal and provincial elections, he was part of meetings with candidates to make them aware of agriculture’s importance in the region. The local federation also hosts an annual summer tour of local farms and greenhouses for municipal, provincial and federal politicians so they can experience local agriculture first hand and receive updates on the key issues facing the sector.
He’s also often called upon by local media for his insights on agricultural issues that make the news.
Currie, for one, would like to see Mailloux become more actively involved in the organization provincially. But so far, that’s not a time commitment he’s able to make. “Farms are getting bigger and busier. We used to farm with our dads and now there’s only two of us, so it’s hard to get away, especially when you have young kids,” Mailloux says. “But it’s good to have a voice at the table on these key issues that affect agriculture.”
Nicholas Budd
Chicken producer developed an early passion for educating people about farming and supply management.
By Treena Hein
Although he’s only been in the poultry sector for a few years, Nicholas Budd is passionate about helping his fellow Canadians understand food production and the related benefits that supply management provides to them and to farmers.
His broiler operation, which he runs with his wife Susan and help from their young son Zachary and daughters Annelise and Elisheva, is located on his family’s farm just a few kilometers from the state of Maine.
Katahdin View Farm, an hour west of Fredericton outside of Woodstock, was started in 1994 by Nicholas’ parents, Drs. Kevin and Patricia Budd, large and small animal veterinarians respectively. Kevin, in particular, had always wanted to farm, so he and Patricia bought the operation just a few years after graduating from the University of Guelph’s Ontario Veterinary College.
“They started with 350 acres, six beef cows and four young children,” Budd says. “That has grown to present cow-calf operation with close to 300 cow calf pairs, 1,700 acres of farm and woodland, a broiler barn, four more children and eight grandchildren and counting. We produce silage and grain for the cattle and have several full-time employees plus parttime/seasonal students.” Among those employed are Budd’s two younger siblings, Hannah and Matthew, who work

primarily with the cattle.
Kevin and Patricia believe in the benefits of education. They encouraged Budd to attend New Brunswick Community College for the Heavy Equipment Technician program. He uses that training extensively on the farm. Indeed, continued education and research into helpful practices and technologies is a core principle for the Budds, and various family members regularly attend conferences both in North America and the U.K.
In recent years, the family has implemented sustainable practices such as rotational grazing, no-till cropping and crop diversification. In addition, they’ve focused on business management and farm succession planning.
Community involvement was a big part of Budd’s childhood and that continues today. “Church participation, 4-H and Spring Show and Sale were regular events for me as a youngster and I now volunteer as opportunities arise,” he says. “We’ve
Nicholas Budd became a broiler producer through the New Entrant Chicken Farmer Program.

Empowering young advocates
Nicholas Budd was one of the first participants in Chicken Farmers of Canada’s (CFC) Young Farmers Program, which launched last year.
A crop of up-and-coming producers were selected to learn about the inner workings of the Canadian chicken industry.
Others participants included Ontario’s Jonathan Giret, Quebec’s Frédéric Emery Dufresne, Alberta’s Andre Poulin and Saskatchewan’s Tiffany Martinka.
Last spring, they attended the Canadian Young Farmer’s Forum in Toronto. This conference brought together young farmers from coast to coast for a weekend to learn about the different commodities in Canadian agriculture, learn about various ways to finance their farms, future planning and make connections with fellow young farmers.
Then in early May, the group came to Ottawa for three days to attend various workshops and events, including CFC’s Lobby Day.
The Young Farmers participated in an intensive orientation seminar that gave them an in-depth look at what CFC does on a day-to-day basis, how the board of directors functions and the various projects CFC staff has been working on.
The group also partook in social media training from MediaStyle, where they learned how to tell their story and share it with the world.
In addition to this training, they participated in meetings during Lobby Day, connecting with Members of Parliament and Senators to discuss the important issues surrounding the chicken sector.
They were also invited to lunch with Alberta MP Earl Dreeshen at the Parliamentary Dining Room.
During this lunch, the young farmers learned about life as a Member of Parliament and the work all parties are doing to support the agriculture sector.
Their time in Ottawa concluded with a behind-the-scenes tour of Parliament Hill, followed by the CFC’s Parliamentary Reception.
The young farmers then travelled to Saskatoon in July to attend CFC’s annual summer meeting.
The board continues to engage with the young farmers to ensure they have the tools to succeed.
These budding leaders are paving the way in Canadian agriculture through innovation, animal and plant science and entrepreneurship.
also hosted folk music jams here on the farm, and work with the Western Valley Equine Association and with local outfitters who take customers on the farm’s woodland to hunt black bear.”
The family also enjoys gardening, forestry and sportsmanship competitions, having faith in God and building their relationships with each other.
Broiler evolution
Broiler farming came about for the Budds because of Kevin’s continued scanning for diversification opportunities. Upon learning of the New Entrant Chicken Farmer Program through the Chicken Farmers of New Brunswick, he encouraged Budd to apply and, sure enough, he was selected in the draw.
The first challenges were to decide on barn design and which mechanical systems to include. “We wrestled for a while with the design and technologies that would prove most efficient but also affordable,” Budd recalls. “We visited farms all across Canada and in the end, decided on a one-story design. It was more expensive but we thought it would ensure a more optimal environment.
“It would provide fewer longterm complications and be safer for the kids, encouraging them to be involved. For the barn’s systems, we decided on hot water heating, a Vencomatic heat exchanger and Maximus Control System with cellphone monitoring.”
The barn was completed over the winter of 2016-2017 and the first flock of broiler chicks arrived in February 2017. Budd says the learning curve was steep, especially since he’d decided to try antibiotic-free production from the start.
However, with no experience in broiler farming, he decided to discontinue with that type of production, but like all other broiler
farmers in Canada, uses select antibiotics in line with Chicken Farmers of Canada’s (CFC) national phase-out policies and says he gets excellent results.
Then, only three flocks into production, the greatest challenge – one that was completely unimaginable – presented itself. A fire completely destroyed the barn down to the foundation slab. Budd says he remains grateful to the Chicken Farmers of New Brunswick for their help recovering from the fire and for help in general through the New Entrant Program. The rebuild was quick, lasting only the length of three flocks, with only minor improvements made to the feed line winching and fan placement in the new barn.
Marco Volpé was impressed with Budd at the time of the fire, which happened less than a year into production. “He didn’t let that bring him down,” says Volpé, who is senior manager at Groupe Westco, a regional poultry company where Budd purchases his chicks. “He took it as an opportunity to grow stronger.”
To increase profits, last year Budd began experimenting with producing a portion of his feed. He bought wheat directly from a local farm, blended it with purchased feed and at this point, he’s fed it to several flocks with good success. Late last year, the Budds took it a step further, planting winter wheat for the first time in order to add their own to purchased feed.
Of their overall approach to broiler farming, Budd says, “Susan and I strive for excellence and we’re always researching. Whether its tweaking lighting or water conditioning modifications, there’s so much to learn.”
Advocacy
As a new entrant, Budd was invited to take part in CFC’s Young Farmers Program last year. In it, he and
the other members of the group (selected from across Canada) received training on the importance of sharing information about poultry farming on social media.
In addition, the group travelled to Ottawa to learn about CFC and attend Lobby Day on Parliament Hill.
“It was my first time in Ottawa and it was very interesting,” Budd says. “We met with politicians and explained to them what we do on our small family farms and why supply management is so important.”
“It matters that such a large percentage of the population, including many politicians, has very little idea how food is produced,” he observes. “We farmers need to show them day-to-day life on a farm, and that farmers are real people. We also explain how we ensure safe food is delivered to consumers.”
During the past year, Budd says he’s realized the importance of social media in making connections with consumers. On a similar note, the Ag Alliance of New Brunswick promotes an Open Farm Day every fall and this year due to Covid-19, the use of virtual tours is being explored instead of physical tours. The Budds
“We farmers need to show them day-to-day life on a farm and that farmers are real people.”.
hope to participate.
And, although he recognizes that COVID-19 has been difficult for everyone, Budd believes that a silver lining can be found in how understanding across Canada has increased in relation to the importance of supporting food production in one’s own country.
“From practices used on the farm to all parts of the supply chain, having food produced here in Canada or even within your own province ensures that quality is maintained and production isn’t disrupted by disease, natural disasters, trade issues or poor practices,” he says. “Local production also keeps you and your friends and neighbours employed.”
“It’s good to see producers like Nicholas in the industry,” says Volpé, who also serves on the board of Chicken Farmers of New Brunswick. “His leadership, attention to details and willingness to learn lets us believe that someday he would be a great director.”
Says Budd, “I’m thankful that I grew up on a farm and that my parents made poultry farming possible. It’s been a fun journey that’s family friendly.”
DARKLING BEETLES ARE STEALING YOUR PROFITS!

Left unchecked, darkling beetles can compromise structural integrity of barns, causing an increase in energy cost, spread disease, and reduce overall ock health. As a part of a darkling beetle long-term control program, Credo®, used in rotation with Debantic® and Tempo® can save producers $4,252 per 100,000 birds.1





































Pauline Duivenvoorden
Telling the egg story in western Newfoundland.
By Lilian Schaer
For Pauline Duivenvoorden, there is huge satisfaction in producing food, but that satisfaction also comes with huge responsibility. Farming is a noble profession, she believes, and with so few Canadians involved in food production today, it’s important for those who are to talk about what they do.
That’s why the egg and dairy farmer from western Newfoundland – she and her husband Phil MacLean farm near Deer Lake about 50 km north of Corner Brook – never misses an opportunity to talk to consumers, whether by hosting open farm day, volunteering at a fair or giving a presentation to school children.
“Having a connection to local food production and understanding the food system is really important. Any opportunity to speak to a consumer on a one-to-one basis is an opportunity that should be taken advantage of,” she says. “On our farm, we do try to embrace the local community and the broader community as much as possible by answering questions and not being secretive about what we do.”
Duivenvoorden grew up in New Brunswick and graduated from what was then the Nova Scotia Agricultural College (now Dalhousie Faculty of Agriculture). She
and MacLean came to Newfoundland and Labrador after her 1986 graduation from the Ontario Veterinary College at the University of Guelph to take a large animal veterinary position with the provincial government.
After MacLean worked for local dairy farmers for several years, the couple started farming themselves with a rented farm before building their own barn in 1999. Duivenvoorden left the veterinary world in 1995 to join her husband as a fulltime farmer, and a little over two decades later, they expanded into poultry through the Egg Farmers of Newfoundland and Labrador new entrants’ program.
A NEW VENTURE
They now own quota for 5,000 layers and lease another 2,500. That’s in addition to a 400-cow dairy herd that is now in transition to three farm employees: a nephew and two brothers (no relation to Duivenvoorden or MacLean) who are all graduates of the Nova Scotia Agricultural College at Dalhousie University.
“With the succession plan for the dairy, we were interested in maintaining some contact with agriculture so poultry was good and manageable for us both to continue to oversee and keep us grounded,” she says. “We were familiar with supply management, but keen to learn and enter into a new venture.”
In 2016, after a year of educating themselves on poultry welfare and housing and reviewing plenty of research, Duivenvoorden and MacLean opted to build an enriched housing barn that could give birds
more space and freedom to express natural behaviours. Also important was ensuring a healthy barn environment for employees.
BUILT FOR ADVOCACY
Part of their new build included a viewing window into the barn and a camera system in the nesting boxes that lets people watch birds laying eggs. That’s because they thought people might be interested in how eggs are produced, but recognized the biosecurity limitations of opening a layer barn up for visitors.
“Fishery, forestry and agriculture are a big part of the economy here and people are fairly comfortable with those industries around them, but they are also interested and keen to know what we do and be sure we’re responsible,” she says.
Every September, they host an open farm day where they now feature egg as well as dairy production. Duivenvoorden makes school visits, especially at the elementary level, to talk to students about farming and volunteers at egg farming displays at local fairs.
They also donate eggs to the food bank in Corner Brook and sponsor a little green thumbs program for classrooms in partnership with the Newfoundland Federation of Agriculture, which provides everything a teacher might need to grow a garden in the classroom and teach students about vegetable production.
TALKING POULTRY
Duivenvoorden particularly enjoys one-on-one chats with consumers and will strike up a conversation at the grocery store if she sees a fellow


shopper buying eggs. It’s a great way, she says, to talk about food safety, the regulatory process and how important it is to have a responsible domestic food system.
“Having a connection to local food production and understanding the food system is really important.”
“I identify myself as an egg farmer and initially they’re surprised; there are only two layer producers in western Newfoundland so they don’t know any egg farmers, but they’re kind of keen to tell me what their thoughts are,” she says.
The first question she usually gets is whether or not the eggs on the shelf are from her farm. So, she uses that opportunity to talk about traceability, for example, and how each egg carton includes a number that is specific to the farm of origin.
With North America a continent of excess when it comes to food, many people don’t know what’s involved in food production, she be -
lieves. That’s what makes those interactions with consumers important – especially at moments when she is reminded of how many people today have never been on a farm.
According to Duivenvoorden, although not every farmer might be comfortable volunteering at a fair or giving a classroom presentation, everyone can talk to someone in their day who is not from agriculture.
“The idea is not to preach, but to share a few words with someone who has questions and make sure we are able to respond to questions and concerns, myths and fallacies,” she says.
Social media is a great way to connect with people too. She interacts with consumers on Twitter, but also enjoys following other farmers for information and support.
LOCAL FOOD’S IMPORTANCE
The pandemic has made people more aware of the importance of local food production and food security, as well as underlined the importance of the supply managed system to economic stability in the farming sector, she says.
And while farmers feel the responsibility of feeding people, it’s a job she believes is no more important than that of an accountant, electrician or the countless others who keep society and the economy moving.
“Very few producers are looking for accolades; what satisfies me is that I’ve provided something that has value to the average Canadian and I don’t need praise for that,” she says. “We always say thanks to consumers – they appreciate being appreciated.”
Egg farmer Pauline Duivenvoorden, pictured here with husband Phil MacLean, hosts open farm days, volunteers at fairs and presents to school children.

Blake Jennings
A heart for egg farming and a head for business.
By Mark Cardwell
Nova Scotia chicken farmer
Blake Jennings has always had a heart for farming and a head for business. At age nine, he started growing and selling squash, gourds and pumpkins at a roadside stand he opened in front of his family’s fifth-generation farm near Truro, an hour’s drive northwest of Halifax.
At 16, when he got his driver’s license, he started supplying pumpkins to the local Sobeys grocery store. Nine years later, Jennings, now 25, is the largest pumpkin producer in Atlantic Canada.
“Pumpkins are time sensitive like Christmas trees,” says Jennings, who hand picks and delivers more than one million pumpkins to Sobeys and Loblaw for the annual jack-o’-lantern market. “They’re worthless the day after Halloween.”
Jennings has always taken the same head’s-up, hands-on approach to his family’s egg business. The aptly-named Bayview Poultry Farms has 15,000 laying hens and pullets in two barns overlooking the Bay of Fundy.
From an early age, Jennings helped his grandfather Cecil, who founded the business in the 1950s, and his father Glen, a former executive vice chair of Chicken Farmers of Canada, to collect eggs, maintain equipment and clean barns.
Jennings also helped them to install the three small wind turbines that have powered the Jennings’ farm since 2007 – an initiative that made both industry and regional headlines for what was then a pioneering effort in both renewable energy and sustainable development.
“They help to reduce our operating costs,” Jennings says about the mills, which are amply powered by the winds from the nearby bay. “And we advertise our eggs as eco-friendly products because our birds are raised with the use of wind power.”
The Jennings made news again in 2014 – the year Jennings started working on the farm full-time, with a stated goal of one day taking over the family business – when they installed an enriched housing system for their birds.
The improvements included a doubling
in everything from the amount of living space to the numbers of perches, nest boxes and scratch boxes. “It’s definitely created a better environment for the birds, which leads to better feed consumption, increased egg production and decreased mortality rates,” Jennings says.
Early advocacy interest
Off the farm, Jennings showed an early interest in attending and participating in professional and public events put on by Egg Farmers of Nova Scotia. “I love to talk to people, inform them and reassure them about eggs and explain how eggs we make get to their place,” Jennings says.
“The most common question or concern I hear from people is they think eggs sold in stores aren’t fresh. I assure them that eggs get to the store in two to seven days and the expectancy is several months if they are kept refrigerated. I tell them eggs don’t have an expiry date – but they do have a best before date.”
“I also tell people who ask about animal welfare how happy our hens are. I also say
Blake Jennings, a fifth-generation egg farmer from Masstown, N.S., has been a passionate industry advocate from a young age.
they are locally produced and that the old myth about cholesterol is just that – a myth.”
One notable discussion Jennings has had about egg farming in Canada and his family’s innovative operations is with Prince Charles and Camilla, the Duchess of Cornwall.
Jennings met the royal couple during their visit to the Seaport Market in Halifax over the Victoria Day weekend in 2014. “It was a great honour,” Jennings told a journalist at the time. “I was shocked to be asked to talk with him. It really was special.”
Jennings later joined Egg Farmers of Canada’s young farmers program, which helps to connect young producers and train them to be industry leaders and advocates.
He calls the meetings, webinars and workshops at the heart of the year-long program a “great opportunity” for young producers to meet and share knowledge, expertise and experience with their peers and to learn about the many segments of the egg industry from leading experts.
He also credits the program with galvanizing his desire to promote the egg business and with boosting his communication skills and confidence. “I love getting out there to promote the goodness and health of our industry,” Jennings says. “I see egg farmers as being part of a big family.”
In addition to public advocacy, the Jennings are also well known to faculty, staff and students at the century-old agricultural campus of Dalhousie University in the village of Bible Hill, a 15-minute drive from the Jennings’ farm.
“We host tours of teachers
and students and other people or groups from the community,” says Jennings, who now owns and lives in his family’s farm house with his girlfriend, Rebecca Smith, while his parents and grandparents live just up the road.
“We’re very happy and proud to show our farm and the clean and healthy environment our hens are raised in.”
Eyeing new ventures
According to Jennings, he and his father are now working on plans to build a new barn that would be equipped with solar panels on the roof.
“We’re looking at it right now,” says Jennings, who likes to buy and fix up old trucks – including a monster truck he built to ride in mud bog events. “Our windmills are getting older so we need to add to our power needs by adding solar panels to the new barn. Solar is quite expensive. But it could be a good investment in the long run.”
For Jennings, the barn project is a continuation of the innovative, dollars-and-sense approach that his family has always taken in regards to egg farming.
“We’re always looking for ways to be more efficient,” he says. “But there’s more to it that. I get great pride from having grown up working with my dad and my grandfather, who’s in his late 80s and still going strong.
“Everything I know I learned from them. Our farm wouldn’t be here if it weren’t for their hard work and passion.”
Working with family, he added, brings both rewards and challenges. “But I honestly can’t imagine doing anything else than this. This isn’t a job. It’s a lifestyle.”

Premium+® laying nest
The Premium+® laying nest is the number one selling nest worldwide. Its high nest acceptance, minimal amount of floor eggs and use of high quality materials are reasons why many farmers worldwide favour the Premium+® laying nest.
Maximum number of first class hatching eggs
Optimal hygienic conditions
Highest possible nest acceptance For more info contact
Reduces the amount of floor eggs to a minimum
www.jpe.org

Sandra Dyck
From city kid to egg farmer and champion for agriculture. By Melanie Epp
Sandra Dyck grew up a city kid in the suburb of Charleswood, a residential community west of Winnipeg’s busy city center. Her father had owned a series of gas stations and car washes dotted throughout the city, but having grown up on a farm, his heart was always in the country.
When she was 15, Dyck’s father sold everything and purchased a broiler farm near Steinbach. The move was tough at first, but she soon came to love life in rural Manitoba. That love has grown into a passion that she harnesses in her work as an advocate. In fact, you’d be hard pressed to find a bigger champion for agriculture and rural living.
Today, Dyck is a full-time farmer, working closely with her husband Eric and their three kids, Rylee, Levi and Jacob. 4-D Farms Ltd. is located in Springstein, Man., about 15 minutes west of Winnipeg.
Dyck spends most of her time in the family’s layer barn, which has been in
production since 1967. She and her husband have quota for 4,500 hens. The layers are housed in enriched colony housing.
The Dycks also farm 3,500 acres, producing mixed grains, including oil and forage seeds.
They also own a leafcutter bee pollination business. Through the latter they custom pollinate alfalfa for seed. What’s more, the family has invested in solar energy and produces enough to power their farm.
Open-door advocacy
A true advocate for the agricultural sector, Dyck’s work connects her with a cross section of the public – from schoolchildren to new Canadians to curious consumers. She and her husband work with a number of organizations, opening their farm up to the public.
The Fort Whyte farm initiative and the University of Manitoba’s agricultural program are the tour’s main organizers, but the farm is open to any groups that are
interested in learning about agriculture. Approximately 150 to 200 people visit the farm each year.
“Education but also exposure is key to helping people understand farming,” the producer says. “It’s one thing to read about farming, but to experience it and see first-hand… that speaks volumes. They come to understand our farming practices and then they’re also advocates for us too.”
The Fort Whyte group brings inner city youth to the farm through a hobby program that teaches them gardening, beekeeping and small-scale livestock farming. The initiative also includes tours of commercial farms.
Dyck enjoys this program as it gives the kids the opportunity to experience something totally different and helps them to explore options when it comes to future employment.
Groups of new immigrants also visit the farm as part of an English as a Second Language (ESL) program. Many were
Sandra Dyck often hosts different groups at her farm to educate people about egg production and more.
farmers in their home countries and are excited to see how operations work in here in Canada.
Second-year agricultural students from the University of Manitoba visit a number of farming operations across the province. Doing so allows them to see what they’ve
“Education but also exposure is key to helping people understand farming.”
learned about in practice. It helps them see the range of possibilities when it comes to working in agriculture.
Raising her game
The visitors aren’t the only ones expanding their horizons. The tours have inspired Dyck to expand hers as well. The producer’s goal for 2020 is to gain a better picture of the different commodity groups through her membership to Keystone Agricultural Producers of Manitoba (KAP). She believes further education will make her a better advocate.
“I find when I go to these events and do these tours people don’t just have questions about poultry or grain,” the egg farmer says. “They ask me questions about cattle, and I’d like to have an educated answer for them.”
As a city kid who suddenly became a farm kid, Dyck understands first-hand just how little city folk sometimes know about how food is produced. Her volunteer work came full circle when, while volunteering for Ag in the Classroom, the producer got to visit her elementary school in Charleswood to talk to kids about farming.
“That’s where I started out as a little kid, and I was able to go back there and share with them my experience as an egg farm-
er,” she says. “It was really cool.”
Through Manitoba Egg Farmers (MEF), Sandra has volunteered at other events aimed at educating the public. For World Egg Day, she was one of a team of farmers who volunteered on behalf of MEF to
educate consumers in grocery stores. They set up stands near the egg cooler and shared information on egg production in the province.
Dyck says their presence helped clear up some of the confusion around the dif-
ferent types of eggs available to consumers. “People love it,” she said. “People come with great questions and stories. It’s very well received.”
The producer also volunteers for Ag in the City, an event where different com-
modity groups get together at the Forks Market in downtown Winnipeg. It promotes agriculture and is aimed more at adults than children.
But her advocacy work also has her working with children. As a 4-H leader for


the Starbuck, Man., club, the rural kids she works with do projects focused on sewing, cooking, camping and outdoor survival. Most of the kids are not from farms, but live in small towns.
The aim is to provide leadership training for youth. They learn how to run a meeting efficiently, how to manage money and keep minutes.
Last year she led a project on small livestock. This year she’s leading the energy program.
Once a month, Dyck teaches Sunday school at the local church. She and her husband also initiated their own club for kids in their community where the kids play games and do crafts. They sometimes give a small lesson to help introduce the children to church.
“My husband and I truly believe in giving back,” she said. What’s the point of it all if you’re not able to give back?”
Fueled by advocacy
While the average person would be exhausted just by reading the list of Dyck’s commitments, she says it’s what fuels her. Before transitioning full-time to the farm, she worked at a hospital in the city. The advocacy work provides her with the social time she misses through her work at the hospital. It’s also more in line with her passions.
“All of these events, I love them,” she says. “This is what gives me energy. If I can combine my passion for agriculture and my passion for people together, usually I will say yes.”
Advocacy work is essential, Dyck says. Consumers want to know where their food comes from and how it is produced, but they’re confused by slick marketing and misinformation.
“Less than two per cent of the population in Canada is connected to any sort of farm, so we have to be a loud two per cent,” she says. “We have to share our story and we love to do it.”
“It is really important for us to share our story so that consumers can make those informed decisions,” she says. “Because if we aren’t telling those stories someone else will.”

Evy Wiebe
RWA chicken leader also a natural advocate.
By Melanie Epp
Anyone who has seen Evy Wiebe in action knows she’s an excellent advocate for Canadian poultry producers. This is no small feat; advocacy is tough work – and necessary. Producers are lucky to have her in their corner.
Wiebe grew up on a small hobby farm in northern Ontario, a place she calls “the farm that time forgot.”
In 1994, she married Rod Wiebe and the two of them took over the family farm from Rod’s parents. The farm is located in Grunthal, Mb., just one hour south of Winnipeg.
The Wiebes have four children, three girls and one boy. The oldest, Emma, completed a nursing degree. She and her husband have a bee farm and live just next door.
The other three, Julia, Katrina and Sam, are still pursuing their studies. Two of the children are interested in taking over the farm when their parents retire.
RWA LEADERS
The Wiebes raise antibiotic-free broilers – 58,721 kg per cycle in two barns, one double level and one single level. In fact, the producers are considered industry leaders in the raised without antibiotic (RWA) subsector.
They’ve been in the program for three years and Wiebe says it’s an interesting challenge. The birds need longer to grow and their health must be closely monitored throughout.
Managing RWA broilers is more challenging too. Water, heat and feed must be closely monitored. There is little margin for error, Wiebe says. Litter presents a challenge, too, as the birds’ 100 per cent-grain-based diet makes for wetter manure. Wetter manure means more ventilation, and more ventilation means more heat.
To address these challenges, the producers work closely with their local feed mill. Wiebe says their relationship with their feed guy is crucial to the farm’s
success. Diet has a great impact on manure and, therefore, the quality of litter. Together, they’ve been able to fine-tune the system to reduce moisture.
The reason they chose to go into RWA was partly because they were offered the chance and partly due to increased demand. “We believe that this is where the consumer is going,” Wiebe says.
Broiler farming is their primary source of income. While Rod spends every day in the barn, much of Wiebe’s time is devoted to family and her advocacy work. The producer spends at least one day a week in the barn.
PATH TO ADVOCACY
Admittedly, Wiebe wasn’t always an advocate for Canadian agriculture. Her path began while doing door-to-door work for the Government of Canada.
At one home, she spoke with a farmer who asked why she was not an advocate for her sector.
“She said if you love your industry and
Evy Wiebe (third from the right) and husband Rod, pictured here with their family, are industry leaders in raised without antibiotics production.
you want it to continue, you need to advocate for your industry,” the chicken farmer recalls. “I stopped a bit and thought about it. It took me a while to actually act on it, but that’s what started this. Someone challenged me.”
That was back in 2007. Since then Evy has taken every opportunity to meet with consumers to raise awareness about poultry farming in Manitoba. Her first gig took her to the Red River Exhibition where she talked to visitors about chicken farming.
“It was a very casual environment,” Evy says. “You would be standing in the
booth and be available for when people had questions. And you would ask them questions and initiate conversations to engage them with chickens.”
ENGAGING THE PUBLIC
At first, Evy says she didn’t do a lot of initiating. Instead, the producer waited for people to approach her.
But as her confidence grew she began to engage with visitors as they passed by. In some cases, she would ask people what they knew about chickens. Most had no experience with farming. In fact, many of them didn’t know the difference between a rooster and a hen.


While many of the questions Evy gets are simple, sometimes she’s faced with tougher questions. Once someone asked her how chickens are slaughtered. In her experience it’s best to always tell the truth, but no more than what is necessary, she cautions.
Since the produceer had visited her local processor she was able to assure them that great care is taken throughout the bird’s life right through to the end.
“I’m 100 per cent comfortable with it, so I want to –when I interact with the public – give them some of the peace I’ve come to so that they can trust that animals are treated humanely,” the producer says.
“The entire life cycle – from when they arrive in my barn until they exit my barn – they were treated well, and I know
that the processing plant also treats them well and they are given a humane end.
“I want to give the public that confidence because I believe it’s there,” she adds. “We treat our animals well.”
A NATURAL
Manitoba Chicken Producers (MCP) food and consumer relations specialist Gina Sunderland has worked closely with Evy for years. In her role at MCP, Sunderland looks for farmers who like communicating with the public and are great at sharing their story.
“Hands down, Evy Wiebe is not only kind and humble, but she is an extremely strong communicator,” Sunderland exclaims.
“It’s very natural for her. She loves her work, she loves being a farmer and she is able to engage and captivate an audience.”
Thanks to her teaching degree, educating the public about chicken farming now comes naturally for Wiebe.
Sunderland says Evy has a gift for knowing where to start when approaching a subject. Evy attributes this gift to a teaching degree, which she uses to bridge the gap between the two worlds. “For some people it’s really simple, but for some it’s more complicated,” she says. “But you look at the knowledge base that the person has and then you just try to stretch it.”
“She’s an incredible community ambassador for our industry.”
TIRELESS ADVOCACY
Evy’s advocacy work has taken her many places. She’s met with consumers in front of the chicken counter in Manitoba grocery stores.
She’s participated in Discover Agriculture in the City, an initiative held at The Forks in the center of Winnipeg. It’s a daylong event that draws people of all ages from all walks of life.
She’s hosted booths at Brandon Royal Winter Fair, Save on Foods, Discovery Place and at Open Farm Day at Farm Food Discovery Centre.
Recently, Evy started visiting schools through Agriculture in the Classroom. She’s enjoyed every single event she’s attended.
Sunderland says poultry farmers are lucky to have Evy as an advocate. “She’s incredibly engaging, vibrant, friendly… people listen to her,” Sunderland says. “She has an incredible way with the public and she has never said no.
“She looks for opportunities, gets out there and engages,” Sunderland continues. “She’s an incredible community ambassador for our industry.”

Darren Ference
Turkey producer committed to raising sector’s profile.
By Treena Hein
Apassion for farming –and promoting it – was always there for Darren Ference, who is currently serving his third year as chair of Turkey Farmers of Canada (TFC). For many years, Ference has advocated for agriculture, and especially turkey farming, educating young people about it in a multitude of ways and mentoring them as well.
He was raised with his brothers on a mixed farm that produced grain and beef in east-central Alberta where his grandparents made their homestead. With his wife Carrie, daughters Ryleigh and Ashleigh and son Raine, Ference carries on the family farming tradition. They crop 3,000 acres and run both cow-calf and poultry operations with Ference’s brother Jason, sister-in-law Chrystal and their children Charlize, Neely and Justin.
The family purchased the poultry farm in Gibbons, Alta., in 2001 for several important reasons. For one, they already had some uncles and aunts who were poultry farmers and could, therefore, draw on them as resources if needed.
What’s more, Ference says he and his family were attracted to the stability of the supply management system as a way to help mitigate some of the risks of their other two farming operations. “Farmers get a fair return under supply management and consumers get good prices, good quality, food safety, environmental and animal welfare assurances, so everybody wins,” he explains.
“We also liked the cycle of turkeys. We thought that three flocks a year would work well with the grain farming and the cows, and it has.”

A POULTRY BUSINESS IS BORN
Ference and his brother decided to name their poultry farm Raeyson’s Poultry, a combined name to represent them and their parents, Ray and Rae.
Although anything new comes with a learning curve and its own share of early challenges, Ference says that with turkey farming, he applied a tried-and-true philosophy that has never let him down. “Yes, I had to learn how production works, but I don’t believe it matters if it’s crops or cows or turkeys, it’s really important to
provide a good start,” he explains.
“You get good poults and give them everything they need, and they will be able to manage the challenges that arise. It’s the same with crops or calves or anything else, including children. If you give your children a good start with a good work ethic and teach them responsibility, they will be able to meet life’s challenges.”
In three barns, Ference and his family produce 700,000 kg of turkey a year. Two barns have the latest in automation for feeding, watering and environmental
Darren Ference (first on the left) with his wife Carrie, daughters Ashleigh and Ryleigh and son Raine.
“People need to see our passion and respect for the land and the animals. We just have to be able to show people.”
control; the producers retrofitted one of these and built another anew after its predecessor was destroyed in a fire in 2017. The Ferences will retrofit the third barn in the future.
A reverse osmosis system treats water for all the barns. The family’s wheat is used in the feed and their canola straw is used as bedding. “We went that way about five years ago when shavings became more expensive and it’s worked well,” Ference says. “In the future, in addition to bringing our third turkey barn up to speed, we will hopefully build a chicken barn and use our chicken quota that we are leasing out now.”
HANDS-ON ADVOCACY
To say Ference is heavily involved in agriculture advocacy might be an understatement. For starters, in a program run by animal science professor Frank Robinson at the University of Alberta, Ference guides agriculture students who are part of the mentorship program.
The producer also educated youth at the nearby Altario School, which includes 60 kids from kindergarten to grade 12. Ference assisted principal Kevin Van Lagen with the small-scale farm he created last year – called the Ag Learning Centre – by adding a miniature turkey barn. Alberta Turkey Producers provided a $2,000 grant for the project, which houses 40 birds for full production cycles.
Van Lagen lauds Ference’s efforts. “Darren had the idea and installed the mini-turkey barn, setting up a feeding and watering system similar to an actual commercial barn. He donates the feed and poults twice a year. When we have a new batch of birds he’s there every day. And afterwards, he’s there at least once a week and collaborates with the teachers all the time. Darren also arranged for the
processing. And from our most recent batch this spring, we donated five turkeys to the local food bank.”
Altario School also runs outdoor education credit courses for high school students from its own rolls and other local schools in the spring and fall, in conjunction with Lakeland College and producers in the area. Students camp out, work in the Ag Learning Centre barn and visit farms like Raeyson’s. “Darren is really passionate about turkey and he wants to raise its profile,” says Van Lagen.
TURKEY BOARDS
In 2009, Ference joined the Alberta Turkey Producers board, later becoming chair and past-chair. He served on the board for the maximum nine years allowed. He was the Alberta member on the TFC board for seven years, and is now completing his third year as chair.
“We’ve worked hard together, producers and processors, to regain the market that turkey has lost through changing demographics,” Ference says. “As demand for whole birds has dropped, we’ve made lots of progress with cut-up pieces, ground
turkey and other products.
“It’s hard to say what effect COVID-19 will have on turkey consumption,” he continues. “People may value that traditional family turkey meal more than ever, but we will continue to promote turkey in all its forms. People are starting to realize it’s leaner and healthier than chicken and just as versatile.”
Ference adds that as agriculture has made progress in educating Canada’s mostly now urban population and combating misinformation, farmers and the entire food sector needs to stay at the forefront.
“People don’t understand food production so they need to understand what it’s all about, and they also need to be able to trust farmers, that they are looking after the land for the next generations, and keep their animals so that they are happy and healthy,” he says. “People need to see our passion and respect for the land and the animals. We just have to be able to show people and find more ways to connect with people.”
As for his spare time, Ference says, “Carrie and I love to be with the kids, camping, boating and travel. The kids play a lot of sports and there’s a lot of travel with that. I believe a farm is a fantastic place to raise a family. I enjoy all the aspects of agriculture and the challenges every day, problem solving and keeping everything moving forward. It’s a challenging and rewarding career.”


Clinton Monchuk
While Clinton
Monchuk’s entry into Canadian poultry was by no means conventional, today he is one of the sector’s strongest advocates. The Farm & Food Care Saskatchewan (FFC SK) executive director took time out of his busy schedule to talk about the importance of advocacy and how he ended up in poultry.
Monchuk wears several hats. He and his brother farm 3,700 acres in east-central Saskatchewan, where they grow malting barley, canola and wheat, as well as oats, flax, yellow peas and brown and yellow mustard. He’s also one of the province’s newest egg farmers. Monchuk and his brother just started their fourth flock. They’ve had quota since 2016, when they built an aviary, free-run system.

But while he loves farming, he admits he’s more of a minority shareholder. His full-time job is with FFC SK, a role that allows him to bring consumers closer to farming and farmers closer to consumers.
Poultry background
Although Monchuk’s a new egg producer, he’s a poultry veteran. For nearly 10 years he served as CEO of Chicken Farmers of Saskatchewan (CFS). While he might not be the most obvious hire, his credentials were perfect for the role.
At that time, the board was looking for someone who understood government workings. Monchuk had done his undergraduate degree in agricultural economics and a master’s degree in business. Following that, he did an internship in Washington, D.C., where he worked as a lobbyist, and then moved to Ottawa to lobby on
behalf of Canadian farmers and ranchers for another three years. He also had experience with supply management, as he grew up on a dairy farm.
Not long after Monchuk took on the role in 2007, there was an avian influenza outbreak in the province. His strengths in management and communication were an immediate asset. “It got me into the fire pretty quick,” he reflects.
University of Saskatchewan poultry extension specialist Tennille Knezacek worked with Monchuk closely during his time at CFS. She says he was instrumental in implementing the new On-Farm Food Safety Assurance Program, as well as managing the avian influenza emergency team in 2007. Knezacek says he also pushed for more industry transparency through social media.
Monchuk, she says, is well suited to his
As executive director of Farm & Food Care Saskatchewan, Clinton Monchuk spends much of his time educating consumers about poultry production.
New egg producer a careerlong poultry advocate. By Melanie Epp
CLASSIC FLOOD CLASSIC FLOOD

Optional two piece cone for installation on existing feed pipes.



Optional 8 or 14 spoke grill.


Reinforced wear areas in the pan add strength, leading to a longer lifespan.

Easy to read Feed Level Indicator ensures each pan is set exactly the same and allows for adjustments as chicks grow.
Specially designed flood windows increase available feed in the pan to attract chicks starting on feed.

Standard or 1/2” longer extended fin. Extended fins keep the cone off the pan bottom maintaining feed flow.
role at FFC SK. “But I miss him in the industry,” she says. “I have nothing but good things to say about Clinton. If he would come back and work for the poultry industry again it would put a huge smile on my face.”
Well-positioned advocate
The combination of his role as a farmer and with FFC SK puts Monchuk in a unique position to reach consumers. Working on-farm keeps him connected with producers, but also helps him to stay relevant when he speaks with consumers.
“Technology changes almost daily,” Monchuk says. “If my only experience with farming was way back in the 80s and 90s, it would be outdated and I wouldn’t be talking current information to consumers.”
Monchuk took on his job at FFC SK in the fall of 2016. Most commodity groups in the province are members of the organization, including egg and chicken producers. Advocacy is the organization’s main task, so helping consumers better understand farming.
Through farm tours, public events and online videos, FFC SK brings consumers closer to the farm. The organization just launched a new initiative called Canadian Food Focus that highlights the nutritional benefits of Canadian agricultural products and helps consumers integrate them into their daily diets.
Informing consumers
Ultimately, though, FFC SK’s role – and Monchuk’s responsibility within the organization – is about making sure consumers have access to truthful information about farming so they can make informed decisions about the food they eat.
Consumers, Monchuk says, have a lot of questions about how eggs and chicken are produced. Many center around animal welfare, he says.
“For the bulk of the population, they’ve never seen the inside of a barn,” Monchuk says. “The vision that they have and their perception around the poultry industry is going to be from animal rights videos.

“If that’s their only perception of the industry you can imagine what they think happens behind these closed doors,” he adds.
In one of his early encounters, Monchuk remembers meeting a woman who told him she would no longer eat poultry products after learning about how they were treated. Monchuk asked her to expand on her concerns and learned that she had seen an animal right video showing unspeakable animal cruelty.
Rather than immediately defending the industry, Monchuk listened to her. “She had a genuine concern and if we don’t address that concern, it becomes an issue later on,” he says.
What followed was an open conversation about poultry production in Canada and how birds are really treated. “When I gave her that alternate view of what happens in a barn and explained what we’re doing it changed her perspective,” he says.
In fact, at the end of the conversation she was asking where she could buy locally produced eggs and chicken, to which he answered, “Pretty much any grocery store.”
Handling tough questions
Other areas of concern for consumers include antibiotics, hormones and genetic modification. Many have questions about the different types of housing systems and what they mean. Monchuk says he’s open about the pros and cons of each, taking special care not to pit one as better than the other.
“Advocacy has to exist,” Monchuk says. “I do that because I work for Farm & Food Care, but also because I’m a farmer. I think that the more farmers and ranchers that do this in our country, the more informed the population will be.”
Some of the questions are tough, and while one might be inclined to avoid answering them, Monchuk says producers should try. While viewing these concerns through farmers’ eyes is understandable, producers should try viewing them from the consumer’s perspective.
“What has to come across is showing that you care. I’ve never met a farmer who doesn’t care about their animals.”
“If we don’t speak up about what we’re doing then that negative view persists,” he says. “What has to come across is showing that you care. I’ve never met a farmer or a rancher who doesn’t care about their animals or their crop or their land. They care about it because it’s their livelihood. In a lot of instances, people don’t realize that.”
At the end of the day, it’s Monchuk’s passion for people and agriculture that drives his advocacy work. “I love talking to people,” he says. “I enjoy talking about farming and I enjoy talking, so I think this position is made for me. I really enjoy it.”
Monchuk with son Jackson, daughter Katelyn and wife Laura.





centerline velocity
» Outlet chevron design is engineered to reduce sound levels
Tavistock, Ontario
1-888-218-7829 sales@ruby360.ca ruby360.ca

Quebec, New Brunswick & Eastern Ontario
Jacques Plante
Saint-Hyacinthe, Quebec 514-232-2539 jacques@ruby360.ca

Manitoba Al Sawatzky
Penner Farm Services (Salmet) Bluenort, Manitoba 204-372-5291 asawatzky@pennerfarmservice.com
Alberta & Saskatchewan
Lance Fluckiger Leduc, Alberta 587-926-0090 lancen@fluckigercarpentry.com










David Phaneuf
Hatching egg producer committed to educating people about their food.
By Mark Cardwell
Quebec hatching egg producer David Phaneuf has always been amazed by how little people know about the origins of the foods they eat. So, he’s made it a personal goal from the start of his professional career to try and change that.
“Most people don’t have any understanding of the broiler industry,” says Phaneuf, a 37-year-old father of three who owns and operates a diversified farming business called Ferme Fatran.
“So, I take every chance I get to talk about our production and to explain how the business works.”
Phaneuf’s advocacy efforts began soon after he graduated with an agronomy degree from Laval University in Quebec City in 2006. He returned home to work alongside his parents Gaétan and Lise on the family farm in Saint-Liboire, a rural municipality an hour’s drive east of Montreal.
The Phaneufs raise 19,000 Ross 308 broiler birds in two flocks in three barns on their property. They also raise 80,000 broilers and 12,000 turkeys annually in four small barns on a nearby farm they bought in 1995.
They grow commercial crops as well –mostly corn for feed mills, soybean for human consumption and barley for breweries – on more than 1,000 acres.

Egg hatching, however, is the Phaneuf’s principal commercial activity, accounting for roughly half of farm revenues and most of the work done by seven employees, including Phaneuf and his parents.
“My kids are still too young to help out,” notes Phaneuf, whose wife Véronique Marcil teaches at a local public school. “But they are already keen to get involved. A farm is a great place to live and learn.”
CAREER-LONG ADVOCATE
Soon after graduating from Laval, Phaneuf signed up for the ambassador program with Quebec’s massive farmers’ union, the Union des producteurs agricole (UPA).
The program notably includes school visits by producers to talk about farming and farming-related issues. “I did a lot of that,” the poultry producer says. “It’s a great opportunity to teach young people about what it is we do.”
The Phaneufs were also early adherents
to the UPA’s ‘Portes ouvertes’ (or open door) program. Begun in 2002, the annual event today involves more than 100 producers who open their farms to public visits on a Sunday in early September.
In addition to doing public advocacy work, Phaneuf has also been an active member of Quebec’s hatching egg producers’ board since 2008. There are 41 hatching egg producers in Quebec who supply the province’s five hatcheries. Like its counterparts in other Canadian provinces, the UPA-affiliated Syndicat des producteurs d’œufs d’incubation du Québec manages the rules and regulations needed to ensure a safe and steady supply of hatching eggs for the broiler industry in la belle province.
“I really enjoy working with my fellow producers and being involved in the many important issues we deal with,” says Phaneuf, who is one of the seven members of the Quebec board and one of its two vice chairs.

David Phaneuf owns and operates a diversified farming business called Ferme Fatran, whose main commercial activity is egg hatching.
PHOTO: DAVID PHANEUF

The Konavi® Feeding System is a breakthrough in global broiler feeding. It features an angled cone with anti-rake fins that helps keep birds out of the feeder to maintain fresh, clean feed. With its low pan height and patented scalloped edge, the Konavi Feeder invites chicks to eat from the pan from day one and gives birds
comfortable, easy access to feed throughout their growth cycle. Plus, the streamlined design permits more complete cleaning between flocks for better bird health. The Konavi Feeder lets beaks in, and helps keep feet out. Learn more about clean, open-style feeding at choretime.com/KONAVI-Broiler-Feeder

PANDEMIC FALLOUT
One current issue, he notes, is the fallout from the COVID-19 crisis, which has led to a steep decline in restaurant sales and created a broiler and chick surplus in the food chain.
That has led to a need to renegotiate prices with Quebec’s hatcheries, which pay hatching egg producers for the chicks they sell, not for the number of eggs they receive.
According to Phaneuf, an average of 82 chicks hatch from every 100 fertilized eggs Quebec producers send to hatcheries. That works out to roughly 58 cents per fertilized egg in Quebec.
“That’s close to the Ontario
price, which is normally a good price that allows us to cover our production costs, to pay our bills and lead a decent life,” Phaneuf says. “But the pandemic has created a situation that we need to straighten out.”
Though he normally travels two or three times a month to UPA headquarters in the off-island Montreal suburb of Longueuil to attend hatching egg board meetings, Phaneuf says those meetings are now being done virtually due to the pandemic.
NATIONAL ISSUES
In addition to his UPA work, Phaneuf is also a regular participant at open meetings of
the Canadian Egg Hatching Producers (CHEP).
As the newest member of Canada’s supply management system, CHEP uses quota, import and price controls to help ensure industry stability and to provide a steady supply of hatching eggs from the nearly 250 Canadian broiler hatching egg farmers in six provinces.
Those farmers produce more than 700 million broiler hatching eggs annually, generating nearly $300 million in revenues and supporting 4,200 jobs directly and indirectly.
According to Phaneuf, participating in open meetings at the national level is a great way to both learn and stay abreast of national and international issues that can impact the egg and poultry industry as a whole and his fellow producers in particular.
“It lets you know who the players are and to better understand the complexities of the issues that are involved,” he says. “That makes it a lot easier for me to make decisions not only at the board level but in my own business as well.”

Phaneuf was notably involved in the federal working group that was struck in December 2018 to look at the potential impacts that several recent and pending free trade deals – including the Comprehensive Economic and Trade Agreement (CETA), the Canada-United States-Mexico Agreement (CUSMA), the Trans-Pacific Partnership (TPP) and Canada-Mercosur – could have on Canada’s poultry and egg sector.
The group spent four months studying the potential
impacts of those trades and made several still-unannounced recommendations to the federal government on how to mitigate them.
“Hatching egg producers get hit from both sides by free trade deals because we lose out on sales for the table egg and broiler markets,” Phaneuf notes.
He says 20 per cent of broilers and seven per cent of poultry meat production in Quebec currently come from eggs that were fertilized and imported into Canada from the U.S. and South American countries like Brazil that are now part of the Mercosur block now in free trade talks with Canada.
“We’re already losing nearly 30 per cent of our market to these imports,” Phaneuf says. “I’m afraid we’ll lose a lot more feathers from the deal with Mercosur if we’re not careful.”
Though he doesn’t hold a position with CHEP – at least not yet – Phaneuf’s participation at the federal level haven’t gone unnoticed. “David is almost always present at CHEP’s open meetings to follow the discussion and shows good engagement,” says CHEP executive director Drew Black. “He is a quick learner and is well informed on industry issues.”
For the time being, however, Phaneuf says he’s content to continue following the federal egg and poultry scene as an interested observer.
“I’m glad to participate and to learn but I’m happy keeping my involvement to the provincial level, which is already pretty demanding in terms of time and commitment,” he says. “My main focus right now is my family and my farm.”
WHO’S WHO DIRECTORY & LISTINGS
ALBERTA
HEALTH MONITORED HATCHERIES
FAIRLANE HATCHERY
PO Box 12, Skiff, AB T0G 2B0
Ph: (403) 222 0000
HARISE EGG PROCESSING & HATCHERY
North West 4-50-24 West 4th, Leduc, AB T9E 2X2
Ph: (403) 986-5013
LETHBRIDGE HATCHERY
1520 – 39 Street North Lethbridge, AB T1H 6L4
Ph: (403) 327-0491
LILYDALE - SOFINA FOODS INC.
7503 - 127th Ave., Edmonton, AB T5C 1R9
Ph: (780) 475 6607
MAPLE LEAF CONSUMER FOODS
4710 - 39 Ave., Wetaskiwin, AB T9A 3G2
Ph: (780) 421 0638
MILLER HATCHERIES
10011 94A Ave., Westlock, AB T7P 2M7
Ph: (780) 349 6691
ROCHESTER HATCHERY
27020 Hwy. 18, RR 1 Westlock, AB T7P 2R9
Ph: (780) 307 3622
SUNRISE HATCHERY INC.
9420 - 109 St., Westlock, AB T7P 2R4
Ph: (780) 307 3622
UNIVERSITY OF ALBERTA, (Edmonton Research Station F-83, Poultry Research Facility) 116 St. – 83 Ave. Edmonton, AB T6G 2R3
Ph: (780) 492 7694 (Hatchery)
REGISTERED EGG GRADING STATIONS
Armena
Sunworks Farm Ltd.
PO Box 55, AB T0B 0G0
Ph: (780) 672 9799
Fax: (780) 672 9984
Athabasca
Katherine Nelson
PO Box 336, AB T9S 2A4
Ph: (780) 675 4741
Bezanson
Mini Creek Farm Ltd.
PO Box 40, AB T0H 0G0
Ph: (780) 568 3308
Blackfalds
Hutterian Brethren Church of Bentley (Bentley Colony Section)
RR 1, AB T0M 0J0
Ph: (403) 885 5095
Breton
Purnima Farms
PO Box 575, AB T0C 0P0
Ph: (780) 696 2332
Fax: (780) 696 2402
Calgary
Burnbrae Farms Ltd.
3404 - 56th Ave. SE, AB T2C 2C3
Ph: (403) 279 1779
Fax: (403) 236 5323
Calgary
1899029 Alberta Ltd., (Sparks Eggs)
RR 6, AB T2M 4L5
Ph: (403) 285 3447
Calgary
Loblaws Inc.
55 Freeport Blvd. NE, AB T3J 2X9
Ph : (403) 567 4319
Carbon
1315153 Alberta Corp., (Britestone Farming)
PO Box 129, AB T0M 0L0
Ph: (403) 572 3049 ext 245
Cardston
Hutterian Brethren Church of East Cardston (1977)
General Delivery, AB T0K 0K0
Ph: (403) 653 2451
Castor
Hutterian Brethren of Castor
PO Box 547, AB T0C 0X0
Ph: (403) 882 3305
Fax: (403) 882 2200
Delia
Cloverleaf Colony Farming Co. Ltd.
PO Box 269, AB T0J 0W0
Ph: (403) 364 3605
Fax: (403) 364 3606
Drumheller
Starland Colony
PO Box 1720, AB T0J 0Y0
Ph: (403) 772 2133
Fax: (403) 772 2152
Eaglesham
Codesa Colony, (Peace Country
Poultry Farms)
PO Box 300, AB T0H 1H0
Ph: (780) 359 2422
Fort Macleod
Driview Farms, (Gerrit and Janet Van Hierden)
PO Box 1123, AB T0L 0Z0
Ph: (403) 553 2178
Grande Prairie
Hutterian Brethren Church of Grandview, (Grandview Colony) 723042B RGD RD. 74, AB T8X 4L1
Ph: (780) 532 6500
Granum
Hutterian Brethren Church of Granum
PO Box 360, AB T0K 1A0
Ph: (403) 687 2180
Hilda
Roseglen Farming Co. Ltd.
Box 117, AB T0J 1R0
Ph: (403) 838 2272 ext 712
Fax: (403) 838 2039
Huxley
Hutterian Brethren Church of Huxley, (Huxley Colony)
RR 2, AB T0M 0Z0
Ph: (403) 442 2488
Irracana
Hutterian Brethren Church of Tschetter, (Tschetter Colony)
General Delivery, AB T0M 1B0
Ph: (403) 935 4406
Irvine
Hutterian Brethren Church of Elkwater, (Elkwater Colony)
PO Box 117, AB T0J 1V0
Ph: (403) 834 2120
Fax: (403) 834 2006
La Crete
Wild Rose Poultry Farms, (Abraham F. Wall)
PO Box 924, AB T0H 2H0
Ph: (780) 928 2557
La Crete
Savage Farm, (Corny F. Wall)
PO Box 1024, AB T0H 2H0
Ph: (780) 928 2721
Lethbridge
Galimax Trading Inc
409 12A Street South, AB T1J 2T2
Ph: (403) 715 8470
Lethbridge
Harvest Haven Market Farm
RR 8, Site 22, Comp. 1, AB T1J 4P4
Ph: (403) 329 9157
Fax: (403) 329 3412
Mayerthorpe
Rocfort Colony Ltd
PO Box 1080, AB T0E 1N0
Ph : (780) 785 3208
Morinville
Moralta Poultry Farms, (Morinville Colony)
RR 2, AB T8R 1P5
Ph: (780) 939 2118
Fax: (780) 939 3452
Morinville
Kuku Farms
RR 1, AB T8R 1P4
Ph: (780) 777 7786
Nobleford
5 Grain Eggs Ltd.
Box 596, AB T0L 1S0
Ph: (403) 308 3502
Oyen
Acadian Hutterian Brethren Ltd., (Acadia Colony)
PO Box 210, AB T0J 2J0
Ph: (403) 664 2406
Pincher Creek
Hutterian Brethren Church of Spring Point
PO Box 249, AB T1K 3Z8
Ph: (403) 553 2284
Pincher Creek
Hutterian Brethren of Pincher Creek
PO Box 1028, AB T0K 1W0
Ph: (403) 627 4021
Red Deer
Hutterian Brethren Church of Pine Hill (P.H. Egg Farms)
RR 4, AB T4N 5E4
Ph: (403) 886 4626
Fax: (403) 886 4656
Standard
Standard Hutterian Brethren, (Standard Colony Farming Co. Ltd.)
PO Box 390, AB T0J 3G0
Ph: (403) 644 2224
Fax: (403) 644 2196
Standard
Midwest Agricultural Co. Ltd
PO Box 190, 213012 Highway 262
Grid, AB T0J 3G0
Ph: (403) 677 2665
Vulcan
Hutterian Brethren Church of the Little Bow Colony
PO Box 1587, AB T0L 2B0
Ph: (403) 897 2323
Warburg
Hutterian Brethren Church of Warburg, (Warburg Colony)
PO Box 520, AB T0C 2T0
Ph: (780) 628 7770 ext 106
Fax: (780) 848-2571
Warburg
Sunshine Organic Farm, (Edward & Sherrill Horvath)
RR 1, AB T0C 2T0
Ph: (780) 848 2288
Fax: (780) 848 2295
Warner Plainview Hutterian Brethren, (Country Morning)
PO Box 240, AB T0K 2L0
Ph: (403) 642 2111 ext 526
Fax: (403) 642 2085
REGISTERED
EGG
PRODUCT STATIONS
Calgary Loblaws Inc.
55 Freeport Blvd. NE., AB T3J 4X9
Ph: (403) 567 4319
Lethbridge
Egg Processing Innovations
Cooperative, (EPIC)
2525 36 St. N., AB T1H 5L1
Ph: (403) 394 7756
Fax: (403) 394 7738
POULTRY CONSULTING, VETERINARIANS, RESEARCH
Canadian Poultry Consultants Ltd.
Ph: (877) 449 3447 admin@canadianpoultry.ca www.canadianpoultry.ca
Smith Poultry Consulting
16 Precourt Place, Cartier, MB R4K 1B3
Ph: (204) 864 2083 smithpoultryconsulting@mymts.net
Poultry Health Services
1A-4 East Lake Ave., Airdrie, AB T4A 2G8
Ph: (888) 950 2252 phsinfo@poultryhealth.ca
PROVINCIAL GOVERNMENT/ UNIVERSITIES
AGRICULTURE AND AGRI-FOOD CANADA
Alberta & Territories regional office 9700 Jasper Ave., Suite 945, Edmonton, AB T5J 4C3
Ph: (780) 495 3307
Fax: (780) 495 3324



aafc.atsbccalendar-calendrierseacb. aac@canada.ca www.agr.gc.ca
ALBERTA AGRICULTURAL PRODUCTS MARKETING COUNCIL
J.G. O’Donoghue Building, 7000 - 113 St., Edmonton AB T6H 5T6
Ph: (780) 427 2164 marketingcouncil@gov.ab.ca www.agriculture.alberta.ca/marketingcouncil
ALBERTA AGRICULTURE AND FORESTRY
229 Legislature Building, 10800-97 Avenue, Edmonton, AB T5K 2B6
Minister of Agriculture and Forestry – Honourable Devin Dreeshen
Ph: (780) 427-2137 AF.minister@gov.ab.ca
CANADIAN FOOD INSPECTION AGENCYRegional Office - Edmonton 8403 Coronet Rd. NW, Edmonton, AB T6E 4N7
Ph: (780) 395 6700
Fax: (780) 395 6792
CANADIAN FOOD
INSPECTION AGENCY -
Regional Office - Alberta South 110 Country Hills Landing NW, Room 102, Calgary, AB T3K 5P3
Ph: (587) 230 2450
Fax: (587) 230 2481
CANADIAN FOOD INSPECTION AGENCYWestern Area Office 1115 57th Ave. NE, Calgary, AB T2E 9B2
Ph: (587) 230 2200
Fax: (587) 230 2253 www.inspection.gc.ca
MINISTRY OF AGRICULTURE AND FORESTRY, GOVERNMENT OF ALBERTA
J.G. O’Donoghue Building, 7000113 St., Edmonton AB T6H 5T6
Ph: (403) 742 7901
Toll Free: (403) 310-FARM (3276) (Ag-Info Centre)
alberta.ca/agriculture-and-forestry
Dr. Valerie Carney, Poultry Research Centre Lead
Ph: (780) 415 2269, valerie.carney@gov.ab.ca
Brenda Reimer, Poultry Research Technologist
Ph: (780) 415 0827, brenda.l.reimer@gov.ab.ca



ALBERTA/ BRITISH COLUMBIA
FACULTY OF VETERINARY MEDICINE,
University of Calgary, Foothills Campus
TRW 2D01, 3280 Hospital Dr. NW, Calgary, AB T2N 4Z6
Ph: (403) 210 3961 Fax : (403) 210-8121
vetmed@ucalgary.ca vet.ucalgary.ca
THE POULTRY RESEARCH CENTRE,
Department of Agricultural, Food and Nutritional Science, University of Alberta F83 Edmonton Research Station, Edmonton, AB T6G 2E1
Ph: (780) 492 6221 Fax: (780) 492 6471 prc@ualberta.ca poultry.ualberta.ca
Dr. Martin Zuidhof, Academic Leader.
INDUSTRY ASSOCIATIONS
Alberta Chicken Producers 2518 Ellwood Dr. SW, Edmonton, AB T6X 0A9
Ph: (780) 488 2125
Fax: (780) 488 3570
Toll Free: (877) 822 4425 www.chicken.ab.ca
Board of Directors: Jason Born, Chair; David Hyink, Vice Chair Directors: Dennis Steinwand, Rob Van Diemen, Henk Schuur Karen Kirkwood, Executive Director.
Alberta Farm Animal Care PO Box 36044 RPO Lakeview, Calgary, AB T3E 7C6
Ph: (403) 652 5111 afac@afac.ab.ca www.afac.ab.ca
Cora Sheele, Chair; James Jenkins, Vice Chair; Casey Vander Ploeg, Finance Chair; Darrell Dalton, Council Chair. Directors: Laurie Fries, Melanie Wowk, Heini Hehli, Steve Mason. Annemarie Pedersen, Executive Director.
Alberta Hatching Egg Producers
#301, 8925 - 51 Ave., Edmonton, AB T6E 5J3
Ph: (780) 434 8414
Fax: (780) 434 9552 info@ahep.ca www.ahep.ca
Jeff Notenbomer, Chair; Gary Van Klei, Vice Chair. Directors: Kevin Tiemstra, Jeff Kamlah and Cora Scheele. Bob Smook, General Manager
Alberta Turkey Producers #101 2520 Ellwood Dr. SW Edmonton, AB T6X 0A9
Ph: (780) 465 5755
Fax: (780) 465 5528 info@albertaturkey.com
www.albertaturkey.com
David Mandel, Chair; Laurel Winter, Vice-Chair; Directors: Graham Gilchrist, Marc Therrien, Scott Olson; Director in Training: Paul Clout
Egg Farmers of Alberta #101-90 Freeport Blvd. NE, Calgary, AB T3J 5J9
Ph: (403) 250 1197
Fax: (403) 291 9216
Toll Free: (877) 302 2344 info@eggs.ab.ca www.eggs.ab.ca
Conrad Vanessen, Chair; Bernadette Vandenborn, Vice Chair; Beatrice Visser, EFC Director; Peter Waldner, EFC Alternate; Elie Hofer, Director; Jerry Hofer, Director. Susan Gal, General Manager.
Western Feed Industry Association (WFIA - ANACAlberta and Saskatchewan Division)
c/o 203, 711 - 51 Ave, Red Deer, AB AB SK T4N 6H8
Ph: (403) 347 7877
Fax: (403) 309 1741 agrinet@telus.net www.anac-ab.ca
Krisjan Jones, Chair; Doug Durbano, Vice-Chair; Jeff Nielsen, Past Chair; Darrell Kimmell, National Director; Directors: Nancy Fischer, Darryl Lewis, Tim Armstrong, Tim Mugford, Sharon Klinger, Alin Friedt; Director at Large: Mike Robinson; Social Directors: John Stephen, Wilf Graf; Division Manager – Brad Drechsler.
BRITISH COLUMBIA
HEALTH MONITORED HATCHERIES
BRADNER FARMS HATCHERY
28670 - 58th Ave., Abbotsford, BC V4X 2E8
Ph: (604) 856 1227
ECHO POULTRY FARM AND HATCHERY
30230 Huntingdon Rd., RR 1, Abbotsford, BC V4X 2K6
Ph: (604) 859 7925
FARMCREST FOODS LTD.
1880 - 30th St. SW, Salmon Arm, BC V1E 4M1
Ph: (250) 832 0036
GOLDEN FEATHER HATCHERY
5840 Blackburn Rd., Chilliwack, BC V2R 4N9
Ph: (604) 823 4938
L 148 HOLDINGS LTD., (OKANAGAN HATCHERY (1989) LTD.)
1429 McLeod Rd., RR 2, Armstrong, BC V0E 1B8
Ph: (250) 546 9223
LILYDALE - SOFINA FOODS INC.
27923 Myrtle Ave., Abbotsford, BC V4X 1R3
Ph: (604) 856 4171
FRASER VALLEY CHICK SALES
1681 Clearbrook Rd., Township 16, New Westminster District, Abbotsford, BC V2T 5X5
Ph: (604) 864 0555
PACIFIC PRIDE CHICKS LTD.
32870 King Rd., Abbotsford, BC V2S 7Z7
Ph: (604) 850 2913
ROSSDOWN FARMS LTD.
2325 Bradner Rd., Abbotsford, BC V4X 1E2
Ph: (604) 856 6698
THIESSEN GAME BIRDS LTD.
6029 Leclair Rd., Abbotsford, BC V4X 2C9
Ph: (604) 856 7405
WESTERN HATCHERY LTD.
505 Hamm Rd., Abbotsford, BC V2T 6B6
Ph: (604) 859 7168
REGISTERED EGG GRADING STATIONS
Abbotsford
Golden Valley Foods Ltd.
3841 Vanderpol Court, BC V2T 5W5
Ph: (604) 855 7431
Fax: (604) 855 7439
Armstrong
Kelly Burden, (Shovel Tree Acres) 1930 Power House Rd., RR 2, BC V0E 1B0
Ph: (250) 546 8597
Black Creek
Kehler Vegetable Company Ltd
8083 Island Highway, BC V9J 1G9
Ph: (250) 202 3236
Bridge Lake Sunset Egg Grading Station 7611 Lee Rd., PO Box 107, BC V0K 1E0
Ph: (250) 593 0038

Cawston
Zebroff’s, (George Zebroff & Zebroff’s Organic Farm)
RR 1, BC V0X 1C0
Ph: (250) 499 5374
Fax: (250) 499-5374
Chilliwak
Local ChickInn Ltd
7324 Hopedale Road, BC V2R 4J9
Ph: (250) 202 3236
Creston
Bren-Den Ventures Ltd
(Sunshine Valley Organics)
1320 2nd Avenue NW, BC B0B 1G6
Ph: (250) 428 8948
Creston
Kootenay Country Farms Inc, 3160 Lister Rd, BC V0B 1G2
Ph: (250) 431-8931
Duncan Running W Egg Farm Ltd., (Farmer Ben’s Eggs)
1711 Herd Rd., RR 1, BC V9L 1M3
Ph: (250) 746 6110
Fax: (250) 746 7799
Farmington
South Peace Hutterian Brethren Church, (South Peace Colony)
PO Box 69, BC V0C 1N0
Ph: (250) 782 8164
Farmington
Peace View Hutterian Brethren
Church, (Peace View Colony)
PO Box 194, BC V0C 1N0
Ph: (250) 789 3010
Nanoose Bay 0917522 B.C. Ltd., (Springford Farm Egg Co.)
1934 Northwest Bay Rd. BC V9P 9C5
Ph: (250) 468 7540
Fax: (250) 468 7545
Nelson
Frederik Mansveld, Pamela
Mansveld, (Mill Creek Farm)
6155 Harrop Procter Rd., BC V1L 6P9
Ph: (250) 229 4717
Redstone
A&S Enterprise Management Inc. (Pasture to Plate)
3781 Chezacut Rd., Box 20, BC
V0L 1S0
Ph: (250) 394 4005
Ruskin
Thompson Creek Farm, (Phillip Northrop)
10437 Wilson Rd., BC V4S 1B4
Ph: (604) 462 9641
250 – 32160 South Fraser Way
Abbotsford, BC V2T 1W5
Phone: 604-556-3348 • bcemb@bcegg.com
Family-owned and operated
BC Egg Board of Directors
Chair
Gunta Vitins, B.Sc., B.Ed, MBA
Vice-Chair, EFC Representative Walter Siemens
Director, EFC Alternate Matt Vane
Director, Secretary Jeff Regier
Director Jon Krahn
BC Egg Management
Executive Director Katie Lowe, PAg
Manager Operations & Logistics Joey Aebig, BBA
Directors Communications and Marketing
Surrey
Selde Farm
3138-144 St., BC V4P 1R1
Ph: (604) 536 7510
Terrace
414612 B.C. Ltd., (Daybreak Farms Ltd.) 4423 Eby St., BC V8G 0B3
Ph: (250) 638 0777
Fax: (250) 638 8757
Victoria
Michael Romaine, (Healing Farm) 5971 Old East Rd., BC V8Y 1V7
Ph: (250) 652 6456
Westbridge Frank and Deborah Van Oyen, (Springhill Eggs)
3220 Christian Valley Rd., PO Box 114, BC V0H 2B0
Ph: (250) 446 2365
Westholme
Burnbrae Farms Ltd., (Island Eggs, A Division of Burnbrae Farms Ltd.)
3492 Mt. Sicker Rd., PO Box 1, BC V0R 3C0
Ph: (250) 246 9298
Fax: (250) 246 2110
REGISTERED EGG PRODUCT STATIONS
Abbotsford
Eggsolutions – Vanderpols Inc.
3911 Mt. Lehman Rd., BC V2T 5W5
Ph: (604) 856 4127
Fax: (604) 856 6724
POULTRY CONSULTING, VETERINARIANS, RESEARCH
Ambrose Poultry Consulting Ltd.
PO Box 80, Stn. Whonnock, Maple Ridge, BC V2W 1V9
Ph: (604) 302 1352
Canadian Poultry Consultants Ltd.
30325 Canary Court, Abbotsford, BC V4X 2N4
Ph: (604) 854 6600
admin@canadianpoultry.ca www.canadianpoultry.ca
Intertek - Cargo Inspection & Testing
105 - 9000 Bill Fox Way, Burnaby, BC V5J 5J3
Ph: (604) 454 9011
Fax: (604) 434 1850 www.intertek.com



Amanda Brittain, MA, ABC
Manager Finance Erin Duetta
Executive Assistant Nicole Thompson




























Poultry Health Services
1625 Angus Campbell Rd., Abbotsford V3G 2G4
Ph: (888) 950-2252
phsinfo@poultryhealth.ca
Poultry Plus Veterinary Consulting Ltd.
11660 Sylvester Rd., Mission, BC V2V 4J1
Ph: (604) 820 5556 poultryplus@hotmail.com
SGS Canada Inc.
3260 Production Way, Burnaby, BC V5A 4W4
Ph: (604) 638 2349
Fax: (604) 444 5486
www.sgs.ca
S.J. Ritchie Research Farms (commercial trials)
30325 Canary Court Abbotsford, BC V4X 2N4
Ph: (604) 854 6600, (877) 449 3447
PROVINCIAL GOVERNMENT UNIVERSITIES
AGRICULTURE AND AGRI-FOOD CANADA
British Columbia regional office
4321 Still Creek Dr., Suite 420
Burnaby, BC V5C 6S7
Ph: (604) 292 5858
Fax: (604) 292 5891
aafc.atsbccalendar-calendrierseacb. aac@canada.ca www.agr.gc.ca
ANIMAL HEALTH CENTRE
1767 Angus Campbell Rd., Abbotsford BC V3G 2M3
Ph: (604) 556 3003
Fax: (604) 556 3010
Toll Free: (800) 661 9903 (BC only) pahb@gov.bc.ca www2.gov.bc.ca
BRITISH COLUMBIA FARM
INDUSTRY REVIEW BOARD
1st Floor 2975 Jutland Rd., Victoria BC V8T 5J9
Victoria BC V8W 9B5
Ph: (250) 356 8945
Fax: (250) 356 5131 firb@gov.bc.ca www2.gov.bc.ca

CANADIAN FOOD
INSPECTION AGENCY -
Regional Office – BC Animal and Food Region (includes Yukon) 4321 Still Creek Dr., Suite 400, Burnaby, BC V5C 6S7
Ph: (604) 292 5700
Fax: (604) 292 5605
CANADIAN FOOD INSPECTION AGENCYWestern Area Office 1115 57th Ave. NE, Calgary, AB BC AB SK MB T2E 9B2
Ph: (587) 230 2200 Fax: (587) 230 2253 www.inspection.gc.ca
MINISTRY OF AGRICULTURE
PO Box 9409, Stn. Prov. Govt., Victoria BC V8W 9V1
Ph: (888) 221-7141 www2.gov.bc.ca/gov/content/ industry/
UNIVERSITY OF BRITISH COLUMBIA,
Faculty of Land and Food Systems, 248-2357 Main Mall, Vancouver BC V6T 1Z4
Ph: (604) 822 1219
Fax: (604) 822 2184 lfs.dean@ubc.ca www.landfood.ubc.ca
INDUSTRY ASSOCIATIONS
ANAC - BC Division
PO Box 2100, Sardis Station Main, Chilliwack, BC V2R 1A5
Ph: (604) 866 2378 rjdornan@telus.net
BC Chicken Growers Association
PO Box 581, Abbotsford, BC V2T 6Z8
Ph: (604) 859 9332 office@bcchickengrowers.ca www.poultryinmotion.ca
Dale Krahn, President; Dave Martens, Vice President; Directors: Mark Bartel, Fred Redekop, Ravi Bathe, Ray Baylis, Brad Driediger, Jeff Spitters, Brian Whitta. Administrator: Margaret Duin.
BC Chicken Marketing Board
101 - 32450 Simon Ave., Abbotsford, BC V2T 4J2
Ph: (604) 859 2868
Fax: (604) 859 2811 info@bcchicken.ca www.bcchicken.ca
Chair: Harvey Sasaki, Vice Chair: Alistair Johnson, Members: Derek Janzen, Ray Nickel and Gay Hahn. Bill Vanderspek, Executive Director

BRITISH COLUMBIA/MANITOBA
BC Egg
250 – 32160 South Fraser Way, Abbotsford, BC V2T 1W5
Ph: (604) 556 3348
bcemb@bcegg.com www.bcegg.com
Gunta Vitins, Chair; Walter Siemens, Vice-Chair, EFC Representative; Matt Vane, Director, EFC Alternate; Jeff Regier, Director, Secretary; Jon Krahn, Director; Katie Lowe, Executive Director
British Columbia Broiler Hatching Egg Commission
180 - 32160 South Fraser Way, Abbotsford, BC V2T 1W5
Ph: (604) 850 1854
Fax: (604) 850 1683 info@bcbhec.com www.bcbhec.com
Jim Collins, Chair; Joe Neels, Vice Chair. Directors: Beata Kunze, Allan Mulder, Calvin Breukelman. Stephanie Nelson, Executive Director.
British Columbia Broiler Hatching Egg Producers’ Association
PO Box 191, Abbotsford, BC V4X 3R2
Ph: (604) 864 7556 association@bcbhec.com www.bcbhec.com
President, Bryan Brandsma; Director: Angela Groothof, Art deRuiter, Wayne DeJong. Secretary, Sandra Lepp.
British Columbia Turkey Marketing Board
106 - 19329 Enterprise Way, Surrey, BC V3S 6J8
Ph: (604) 534 5644
Fax: (604) 534 3651 info@bcturkey.com
Kevin Klippenstein, Chair; Shawn Heppell, Board Member, TFC Representative; Debbie Etsell, Board Member, Finance Chair; James Krahn, Board Member & Vice Chair. Michel Benoit, General Manager.
MANITOBA
HEALTH MONITORED HATCHERIES
BERG’S POULTRY FARM AND HATCHERY
Hwy. 45 E., PO Box 547, Russell, MB R0J 1W0
Ph: (204) 773 2562
CARLETON HATCHERIES
Hwy. 216 S., Grunthal, MB R0A 0R0
Ph: (204) 434 6886
CHARISON TURKEY HATCHERY
North East 31-15-2 East, Room of Rockwood, Gunton, MB R0C 1H0
Ph: (204) 886 2922
CLARK HY-LINE INC.
PO Box 48, Site 520, RR 5, Brandon, MB R7A 5Y5
Ph: (204) 725 3500
FRIENDLY FAMILY FARMS
LTD. (Hatchery Division)
247 Centre Ave., Blumenort, MB R0A 0C0
Ph: (204) 326 2384
Exceldor Cooperative /Exceldor Coopérative
750 Pandora Ave. E., Winnipeg, MB R2C 4G5
Ph: (204) 488 2230
HIDDEN VALLEY COLONY LTD.
PO Box 69, Austin, MB R0H 0C0
Ph: (204) 637 2506
JAMES VALLEY HATCHERY
PO Box 324, Elie, MB R0H 0H0
Ph: (204) 353 2006
MAPLE GROVE HATCHERY
32 Tower Ave., Steinbach, MB R5G 0B8
Ph: (204) 326 3454
SNOW VALLEY FARMS LTD.
PO Box 2587, Winkler, MB R6W 4C3
Ph: (204) 325 8487
STEINBACH HATCHERY & FEED
231 Main St., Steinbach, MB R5G 1Y7
Ph: (204) 326 3454
REGISTERED EGG GRADING STATIONS
Arden
Riverside Hutterian Mutual Corporation, (Riverside Poultry Farm)
PO Box 278, MB R0J 0B0
Ph: (204) 368 2284
Brandon
TNT Egg Processors
RR 5, Box 32, MB R7A 5Y5
Ph: (204) 728-0959
Cartier
Maxwell Colony Ltd.
RR 1, PO Box 210, MB R4K 1B8
Ph: (204) 864 2709
Fax: (204) 864 2175
Darlingford
Pembina Colony Ltd.
General Delivery, MB R0G 0L0
Ph: (204) 246 2081
Fax: (204) 246 2080
Deloraine
Gerard August & Marguerite
Martha Raes, (Bayview Farms)
RR 1, MB R0M 0M0
Ph: (204) 747 2020
Fax: (204) 747 2448
Dugald
Ridgeland Colony Ltd.
PO Box 508, RR 1, MB R0E 0K0
Ph: (204) 866 2970
Fax: (204) 866 3084
Elie
Iberville Hutterian Mutual Corp.
PO Box 435, MB R0H 0H0
Ph: (204) 864 2058
Elkhorn
Boundary Lane Colony Farms, (Boundary Lane Colony)
PO Box 40, MB R0M 0N0
Ph: (204) 845 2111 ext 210
Fax: (204) 845 2203
Graysville
Rose Valley Holding Co. Ltd., (Rose Valley Colony Ltd.)
PO Box 93, MB R0G 0T0
Ph: (204) 828 3338 ext 208
Fax: (204) 828 3279
Headingley
Sturgeon Creek Colony Farms Ltd.
PO Box 285, MB R4J 1C1
Ph: (204) 633 2196
Fax: (204) 633 7746
Lac du Bonnet
Brightstone Colony Farms Ltd.
PO Box 880, MB R0E 1A0
Ph: (204) 345 2526
Fax: (204) 345 6039
Miami
Rosebank Colony Ltd.
PO Box 280, MB R0G 1H0
Ph: (204) 435 2388
Portage la Prairie
Poplar Point Colony Farms Ltd.
PO Box 910, MB R1N 3C4
Ph: (204) 267 2560
Somerset
Evergreen Colony Ltd.
PO Box 231, MB R0G 2L0
Ph: (204) 744 2596
St. Andrews
Daniel Waldner, (Daniel Waldner & Elizabeth Waldner)
1077 Fort Garry Rd., MB R1A 3W4
Ph: (204) 482 7360
St. Andrews
S & D Clouston Farms
1056 Bracken Rd., MB R1A 4H8
Ph: (204) 482 4984
Fax: (204) 785 2713
Steinbach
Ackron Egg Farms Ltd., (Nature’s Farm)
5 Life Sciences Pkwy., MB R5G 2G7
Ph: (204) 326 5509
Fax: (204) 326 6626
Steinbach
Countryside Farms
88 Millwork Dr., MB R5G 1V9
Ph: (204) 284 0632
Fax: (204) 326 5744
Winnipeg
Burnbrae Farms Ltd.
500 Pandora Ave. W., MB R2C 1N1
Ph: (204) 222 2783
Fax: (204) 224 0046
REGISTERED EGG PRODUCT STATIONS
Winnipeg Burnbrae Farms Ltd.
500 Pandora Ave. W., MB R2C 1N1
Ph: (204) 222 2783
Fax: (204) 224 0046
POULTRY CONSULTING, VETERINARIANS, RESEARCH
Canadian International Grains Institute
303 Main St., Suite 1000, Winnipeg, MB R3C 3G7
Ph: (204) 983 5344 www.cigi.ca
Canola Council of Canada
400 - 167 Lombard Ave., Winnipeg, MB R3B 0T6
Ph: (204) 982 7763
Toll Free: (866) 834 4378 admin@canolacouncil.org www.canolacouncil.org
Central Testing Laboratories Ltd.
Unit 9 - 851 Lagimodiere Blvd., Winnipeg, MB R2J 3K4
Ph: (204) 237 9128 www.ctl.mb.ca
Dominion Veterinary Laboratories Ltd.
1199 Sanford St., Winnipeg, MB R3E 3A1
Ph: (204) 589 7361 www.domvet.com
Intertek - Agricultural Testing, Grading & Inspection
973 St. James St., Winnipeg, MB R3H 0X2
Ph: (204) 944 1887 www.intertek.com
South-East Veterinary Clinic Hwy. 52 & Herschfeld Rd., Steinbach, MB R5G 1P5
Ph: (204) 326 9849
Fax: (204) 326 5594 www.southeastvet.ca
Verus Animal Nutrition
3220 Roblin Blvd., Winnipeg, MB R3R 0C3
Ph: (204) 414 9400
Fax: (204) 414 9405 orders@verusalliance.com www.verusalliance.com
PROVINCIAL GOVERNMENT UNIVERSITIES
AGRICULTURE AND AGRI-FOOD CANADA
Manitoba regional office
303 Main St., Room 402, Winnipeg, MB R3C 3G7
Ph: (204) 259 4189
Fax: (204) 259 4088 aafc.atsbulletinmb-bulletinseamb. aac@canada.ca www.agr.gc.ca
CANADIAN FOOD INSPECTION AGENCYRegional Office - Manitoba
269 Main St., Room 613,
Winnipeg, MB R3C 1B2
Ph: (204) 259 1400 Fax: (204) 259 1331 www.inspection.gc.ca
CANADIAN FOOD INSPECTION AGENCYWestern Area Office 1115 57th Ave. NE, Calgary, AB T2E 9B2
Ph: (587) 230 2200 Fax: (587) 230 2253 www.inspection.gc.ca
VETERINARY DIAGNOSTIC SERVICES, DEPARTMENT OF AGRICULTURE, FOOD AND RURAL DEVELOPMENT, GOVERNMENT OF MANITOBA 545 University Cres., Winnipeg MB R3T 5S6 Ph: (204) 945 8220 www.gov.mb.ca/agriculture/ livestock
UNIVERSITY OF MANITOBA
Department of Animal Science, Faculty of Agricultural & Food Sciences, 201 - 12 Dafoe Rd.
Winnipeg MB R3T 2N2
Ph: (204) 474 9383 Fax: (204) 474 7628 animal_science@umanitoba.ca www.umanitoba.ca/afs/animal_ science/
Poultry Research Unit Supervisor, Jay Bourcier, (204) 297 7217
INDUSTRY ASSOCIATIONS
ANAC - Manitoba Division
338 Luxiana Dr., Grande Pointe, MB R5A 1E1 Ph: (204) 918 2546 bjames.anac@gmail.com
Manitoba Chicken Producers 1357 Kenaston Blvd., Winnipeg, MB R3P 2P2 Ph: (204) 489-4603 Fax: (204) 488-1163 chicken@chicken.mb.ca www.chicken.mb.ca
Jake Wiebe, Chair; Stuart Nikkel, Vice Chair; Directors: Josie Boschman, Ted Froese, Murray Klassen, Dean
DIRECTORS
Jake Wiebe Chair
Stuart Nikkel Vice Chair
Murray Klassen
Dean Penner
Benny Waldner
Penner, Benny Waldner, Claudia Wollmann. Staff: Wayne Hiltz, Executive Director.
Manitoba Egg Farmers 18 - 5 Scurfield Blvd., Winnipeg, MB R3Y 1G3
Ph: (204) 488 4888 Fax: (204) 488 3544 www.eggs.mb.ca
Harold Froese, Member-at-Large, Chair; Catherine Kroeker-Klassen, Member-at-Large, Vice Chair; Members: Rick Lee, District 2; Kurt Siemens, District 3; Doug Pauls, District 4; Edward Maendel, District 6. Dan Penner, Memberat-Large. Executive Member, Ed Kleinsasser.
Manitoba Turkey Producers 895B Century St., Winnipeg, MB R3H 0M3 Ph: (204) 489 4635 Fax: (204) 489 4907 mbturkey@turkey.mb.ca www.turkey.mb.ca
Rachelle Brown, Chair, Executive Committee, Turkey Farmers of Canada Director; Bill Uruski, Vice-Chair, Executive Committee, Keystone Agricultural Producers Alternate, Provincial Animal Care

Committee; Steve Hofer, Director, Turkey Farmers of Canada Alternative; Mike Reimer, Director, Keystone Agriculture Producers Rep. Helga Wheddon, General Manager.
NEW BRUNSWICK
HEALTH MONITORED HATCHERIES
ATLANTIC POULTRY INC. 425 Route 104, Burtts Corner, NB E6L 2A9 Ph: (506) 363 3054
COUVOIR WESTCO LTÉE 9 Boulet St., St. François, NB E7A 1A5 Ph: (506) 992 3112
MARITIME HATCHERY LTD 29727, route 134 Dalhousie Junction, NB E3N 5Z7 Ph: (506) 684 9111
Wayne Hiltz
Executive Director
Gina Sunderland
Food & Consumer Relations
Erica Poudrette
Executive Assistant
Lucinda Reay
Production Control Manager
Victoria Kurtz
Office Coordinator
Val Weeks
Field Services Manager
Rachel Plett
Field Services Technician
To advocate for the sustainability of our farmers so that we can continue to provide a healthy, safe and nutritious supply of chicken to our communities.
1357 Kenaston Boulevard,Winnipeg MB R3P 2P2
Tel: 1 204 489 4603 Email: chicken@chicken.mb.ca www.chicken.mb.ca
REGISTERED EGG GRADING STATIONS
Amherst
Sunny Glen Eggs Ltd.
50 Tantrammar Cres., NB B4H 0A1
Ph: (506) 363 3025
Fax: (506) 363 3667
Bear Island
Goodine’s Poultry Farm
3166 Route 105, NB E6L 1H7
Ph: (506) 363 2323
Edmundston
Les Oeufs Madalia S.E.C., (Madalia Eggs L.P.)
460, chemin St-Joseph, NB E7B 2G9
Ph: (506) 735 3949
Kars
Grants Breeder Farm Ltd.
2914 Route 124, NB E5T 2Y1
Ph: (506) 485 2930
Fax: (506) 485 2930
Keswick
Early Bird Eggs Ltd.,
(Dunphy’s Poultry Farm)
RR 3, NB E6L 2A2
Ph: (506) 363 3092
Fax: (506) 363 4370
St. Simon
Ferme Avicole Chiasson
RR 1, Site 32A, rue Centre, NB E0B 1L0
Ph: (506) 727 5597
POULTRY CONSULTING, VETERINARIANS, RESEARCH
Perennia Field Services/Food
Safety Services
199 Dr. Bernie MacDonald Dr., Bible Hill, NS B6L 2H5
Ph: (902) 896 0277
Fax: (902) 896 7299 info@perennia.ca www.perennia.ca
PROVINCIAL GOVERNMENT/ UNIVERSITIES
AGRICULTURE AND AGRI-FOOD CANADA
Atlantic Regional Office
410 - 1791 Barrington St., 4th Floor, Halifax, NS B3J 3K9
Ph: (902) 426 3198
Fax: (902) 426 3439
aafc.atsbulletin-bulletinsea.aac@ canada.ca www.agr.gc.ca
AGRICULTURE AND AGRI-FOOD CANADA
New Brunswick regional office PO Box 57000, Research Centre, 850 Lincoln Rd., Fredericton, NB E3B 6C2
Ph: (506) 460 4346
Fax: (506) 460 4345
aafc.atsbulletin-bulletinsea.aac@ canada.ca
CANADIAN FOOD
INSPECTION AGENCY
- Regional Office – New Brunswick
500 Beaverbrook Court, Suite 430, Fredericton, NB E3B 5X4
Ph: (506) 452 4962
Fax: (506) 451 2562
CANADIAN FOOD
INSPECTION AGENCY- Atlantic Area Office
1081 Main St., PO Box 6199
Moncton, NB E1C 8R2
Ph: (506) 777 3939
Fax: (506) 777 3942 www.inspection.gc.ca
DEPARTMENT OF AGRICULTURE, AQUACULTURE AND FISHERIES, GOVERNMENT OF
NEW BRUNSWICK
Agricultural Research Station, PO Box 6000, Fredericton NB E3B 5H1
Ph: (506) 453 2666
Fax: (506) 453 7170
DAAF-MAAP@gnb.ca www.gnb.ca/AgricultureAquacultureFisheries
INDUSTRY ASSOCIATIONS
ANAC - Atlantic Division
Matthew Miller, Chairman; Neil Campbell, Vice-Chairman. Director: Anne Beaumont, Katelyn O’Connell (NS), Ed Doyle (NL), Jeff Dean (PEI). Director-at-Large: Ashley Gillcrist, Dave Seeley Chicken Farmers of New Brunswick 101 - 277 Main St., Fredericton, NB E3A 1E1
Ph: (506) 452 8085
Fax: (506) 451 2121 nbchicken@nb.aibn.com
Hugh Harmon, Chair; Marc Cormier, Vice Chair, CFC Director; Members: Léandre Morin, Daniel Dupuis, Marco Volpé. Louis Martin, Manager.



Egg Farmers of New Brunswick/Les producteurs d’oeufs du N.-B.
Suite 101, 275 rue Main Street, Fredericton, NB E3A 1E1
Ph: (506) 458 8885
Fax: (506) 453 0645 nbegg@nbnet.nb.ca www.nbegg.ca
Hans Kristensen, Chair
Turkey Farmers of New Brunswick
103 - 277 Main St., Fredericton, NB E3A 1E1
Ph: (506) 452 8103
Fax: (506) 451 2121 nbturkey@nb.aibn.com www,nb.canadianturkey.ca
Bertin Cyr, Director; Joshua Hayes, Alternate Director; Hugo Therrien, 2nd Alternate Director. Louis Martin, Sec.-Mgr.
NEWFOUNDLAND
HEALTH MONITORED HATCHERIES
ATLANTIC POULTRY INC.
Route 80, Blaketown Rd., Whitbourne, NL A0B 3K0
Ph: (709) 759 2305
REGISTERED EGG GRADING STATIONS
Roaches Line
Newfoundland Eggs Inc.
Site 4, Box 7, RR 1, NL A0A 1W0
Ph: (709) 528 4595
Fax: (709) 528 4596
Portugal Cove-St. Philip’s
Stewart King 170 Bennetts Road, NL A1M 1X3
Ph: (709) 895 3131
POULTRY CONSULTING, VETERINARIANS, RESEARCH
Perennia Field Services/Food Safety Services 199 Dr. Bernie MacDonald Dr.,



Bible Hill, NS B6L 2H5
Ph: (902) 896 0277
Fax: (902) 896 7299 info@perennia.ca www.perennia.ca
PROVINCIAL GOVERNMENT
UNIVERSITIES
AGRICULTURE AND AGRI-FOOD CANADA
Atlantic Regional Office
410 - 1791 Barrington St., 4th Floor, Halifax, NS B3J 3K9
Ph: (902) 426 3198
Fax: (902) 426 3439
aafc.atsbulletin-bulletinsea.aac@ agr.gc.ca
www.agr.gc.ca
AGRICULTURE AND AGRI-FOOD CANADA
Newfoundland and Labrador
regional office
308 Brookfield Rd., Building 25, St. John’s, NL A1E 0B2
Ph: (709) 793-3186
Fax: (709) 793-3341
aafc.atsbulletin-bulletinsea.aac@ canada.ca
CANADIAN FOOD INSPECTION AGENCY
- Regional Office -
Newfoundland and Labrador
10 Barter’s Hill,
St. John’s, NL A1C 5X1
Ph: (709) 772 4424
Fax: (709) 772 2282
FARM INDUSTRY REVIEW BOARD
Production and Market Development Division
2nd Floor Fortis Building, 4 Herald Avenue, PO Box 2006, Corner Brook NL A2H 6J8
Ph: (709) 637 2672
Fax: (709) 637 2365
www.flr.gov.nl.ca
FORESTRY AND AGRIFOODS AGENCY, GOVERNMENT OF NEWFOUNDLAND AND LABRADOR
Animal Health Division
1st Floor, Provincial Agriculture Building
308 Brookfield Road, PO Box 7400, St John’s, NL A1E 3Y5
Ph: (709) 729-6879
Fax: (709) 729 0055
animalhealthdivision@gov.nl.ca
www.faa.gov.nl.ca







When you need the highest performing systems with proven positive real results, and bird densities to fit any barn size, you can depend on Big Dutchman and J. Dean Williamson Ltd. to help.






INDUSTRY ASSOCIATIONS
ANAC - Atlantic Division
Matthew Miller, Chairman; Neil Campbell, Vice-Chairman.
Director: Anne Beaumont, Katelyn O’Connell (NS), Ed Doyle (NL), Jeff Dean (PEI). Director-at-Large: Ashley Gillcrist, Dave Seeleyt
Chicken Farmers of Newfoundland and Labrador PO Box 8098, St. John’s NL A1B 3M9
Ph: (709) 747 1493
Fax: (709) 747 0544 rwalsh@nlchicken.com www.nlchicken.com
Paul Dunphy, Chairperson; Carol Anne Walsh, Vice-Chairperson; Directors: Davis Noel, Ruth Noseworthy, Alex Smallwood. Ron Walsh, Manager.
Egg Farmers of Newfoundland and Labrador PO Box 175, Mount Pearl, NL A1N 2C2
Ph: (709) 722 2953
Fax: (709) 722 6204
info@nleggs.ca www.nleggs.ca

NOVA SCOTIA
HEALTH MONITORED HATCHERIES
ATLANTIC POULTRY INCORPORATED
9565 Commercial St., New Minas, NS B4N 3G3
Ph: (902) 678 1335
COX ATLANTIC CHICK
HATCHERY LTD.
7762 Hwy. 215, Maitland, NS B0N 1T0
Ph: (902) 261 2244
MARITIME CHICKS LTD.
2844 Bishopville Rd., Hantsport, NS B0P 1P0
Ph: (902) 684 3530
NSAC HATCHERY
39 Discovery Dr., Truro, NS B2L 2R2
Ph: (902) 893 6635
REGISTERED EGG GRADING STATIONS
Amherst
Maritime Pride Eggs Inc.
50 Tantramar Cres., NS B4H 0A1
Ph: (902) 667 2015
Fax: (902) 667 1630
Collingwood
Floyd Dickie & Sons Ltd.
3009 Wyvern Rd., NS B0M 1V0
Ph: (902) 686 3829
Fax: (902) 686 3171
Lake George
Canaanland Free Range Eggs
4529 Aylesford Rd., NS B0P 1C0
Ph: (902) 847 0831
Middleton
Coldspring Farm Ltd.
77 Delusion Rd., NS B0S 1P0
Ph: (902) 825 4401
Millville, Cape Breton Co.
Hilly Acres Farm Ltd.
289 Millville Rd., NS B0C 1B0
Ph: (902) 674 2825
Fax: (902) 674 2858
New Germany
Delong Poultry Farm Ltd.
312 Barss Corner Rd., NS B0R 1E0
Ph: (902) 644 2718
Fax: (902) 644 2718



Geneve Newcombe, Director
Paul Overmars, Director
Ian Thomas, Director

New Ross
Rocky Top Farm
150 Will Turner Rd., NS B0J 2M0
Ph: (902) 689 2112
Fax: (902) 689 2520
Nuttby
Sullivan’s Family Farm
161 Sullivan Road, NS B6L 6T5
Ph: (902) 890 0415
Port Morien
Terence Kennedy
3980 Homeville Rd., RR 1, NS B0A 1T0
Ph: (902) 849 3478
Port Williams
Atlantic Poultry Incorporated
830 & 840 Belcher St., NS B0P 1T0
Ph: (902) 679 4711
Fax: (902) 678 8599
Princeville, Inverness Co.
Rooyakkers Farm Ltd.
901 Riverside Rd., NS B0E 3L0
Ph: (902) 625 2131
Fax: (902) 631-4621
West Dublin
Gerald Risser
78 Bushen Hill Rd., NS B0R 1C0
Ph: (902) 688-3134
Fax: (902) 688-3134


Jeff Clarke, Chair
Tim Cox, Vice Chair
Glen Jennings, EFC Director
Ralph DeLong, Director
Proudly representing Nova Scotia’s egg and pullet producers.
2020 Board of Directors:
POULTRY CONSULTING, VETERINARIANS, RESEARCH
Perennia
199 Dr. Bernie MacDonald Dr., Bible Hill, NS B6L 2H5
Ph: (902) 896 0277
Fax: (902) 896 7299 www.perennia.ca
PROVINCIAL GOVERNMENT UNIVERSITIES
AGRICULTURE AND AGRI-FOOD CANADA
410 - 1791 Barrington St., Halifax, NS B3J 3K9
Ph: (902) 426 3198 Fax: (902) 426 3439 aafc.atsbulletin-bulletinsea.aac@ canada.ca www.agr.gc.ca
ATLANTIC POULTRY RESEARCH INSTITUTE
Haley Institute of Animal Science andAquaculture
PO Box 550, 25 Farm Lane, Truro NS B2N 5L9
Ph: (902) 893 6657
Fax: (902) 895 6734 laurie.eagles@dal.ca www.dal.ca/sites/apri.html
Yvonne Thyssen-Post, Chief Executive Officer; Janice MacIsaac, Research Associate
DALHOUSIE UNIVERSITY, FACULTY OF AGRICULTURE, Department of Animal Science and Aquaculture
58 River Rd., PO Box 550, Truro NS B2N 5E3
Ph: (902) 893 6600
Dr. Bruce Rathgeber, Associate Professor, Poultry
Ph: (902) 893 6654 brathgeber@dal.ca dal.ca/faculty/agriculture.html
CANADIAN FOOD INSPECTION AGENCYRegional Office - Nova Scotia 44-1000 Windmill Rd., Dartmouth, NS B3B 1L7
Ph: (902) 536 1010
Fax: (902) 536 1098
DEPARTMENT OF AGRICULTURE, Veterinarians at Hancock Veterinary Pathology Lab 65 River Rd., Hancock Veterinary Building, Bible Hill NS B2N 2P3
Ph: (902) 893 6540
Fax: (902) 895 6684
AnimalHealthLab@novascotia.ca www.novascotia.ca/agri
NATURAL PRODUCTS
MARKETING COUNCIL, NS DEPT. OF AGRICULTURE
Edward F. Lorraine Building, 74 Research Dr., Bible Hill NS B6L 2R2
Ph: (902) 893 6511
Fax: (902) 893 6573
Elizabeth Crouse, General Manager elizabeth.crouse@novascotia.ca www.novascotia.ca/agri
NOVA SCOTIA DEPARTMENT OF AGRICULTURE
1800 Argyle St., Suite 607, Halifax NS B3J 3N8
Ph: (902) 424 4560
Fax: (902) 424 4671
Toll Free: (800) 279 0825 www.novascotia.ca/agri
INDUSTRY ASSOCIATIONS
ANAC - Atlantic Division
Matthew Miller, Chairman; Neil Campbell, Vice-Chairman. Director: Anne Beaumont, Katelyn O’Connell (NS), Ed Doyle (NL), Jeff Dean (PEI). Director-at-Large: Ashley Gillcrist, Dave Seeley
Chicken Farmers of Nova Scotia
531 Main St., Kentville NS B4N 1L4
Ph: (902) 681 7400
Fax: (902) 681 7401
chicken@nschicken.com www.nschicken.com
Thom Qulton, Chair; Ron teStroete, Vice-Chair; Directors: Karson Lewis, John Swetnam, Julie Gould, Warren Cox. Chris Bell, Executive Director.
Egg Farmers of Nova Scotia
55 Queen Street, PO Box 1096, Truro, NS B2N 2B2
Ph: (902) 895 6341
www.nsegg.ca
Jeff Clarke, Chair, Pullet Director; Tim Cox, Vice Chair, Western Zone; Glan Jennings, EFC Director, Central Zone; Ralph DeLong, Southern Zone; Geneva Newcombe, Western Zone; Theodore Eyking, Eastern Zone; Paul Overmars, Eastern Zone; Ian Thomas, Central Zone.
Turkey Farmers of Nova Scotia 969 Seminary Ave., Box 407, Canning NS B0P 1H0
Ph: (902) 582 7877
Fax: (902) 582 5326 info@turkeyfarmersofnovascotia. com www.turkeyfarmersofnovascotia. com
ARKELL HATCHERY
RR 2, 413 Arkell Rd. Guelph, ON N1H 6H8
Ph: (519) 836 0150
BONNIE’S CHICK HATCHERY LTD.
18 Arthur St., Elmira, ON N3B 2Z6
Ph: (519) 669 2561
CARGILL LIMITED
644 Nanticoke Creek Parkway, Jarvis, ON N0A 1J0
Ph: (519) 587-2289
CEVA ANIMAL HEALTH INC.
131 Malcolm Rd., Guelph, ON N1K 1A8
Ph: (519) 822-2994
CRO QUAIL FARMS INC. (Cro Quail Farms and Speck Farms) 3625 16th Rd., St. Anns, ON L0R 1Y0 Ph: (905) 562 7277
CUDDY FARMS LTD. 2008
528429 Centre Rd., RR 5, Strathroy, ON N7G 3H6 Ph: (519) 245 1592
FLINTSHIRE PHEASANT HATCHERY
RR 1, Flinton, ON K0H 1P0
Ph: (613) 336 8552
FREY’S HATCHERY LTD.
7269 Wellington Rd. 86, Wallenstein, ON N0B 2S0
Ph: (519) 664 2291
FREY’S HATCHERY LTD.
80 Northside Dr., St. Jacobs, ON N0B 2N0 Ph: (519) 664 2291
HORIZON POULTRY
Direct Bag, PO Box 1000, Hanover, ON N4N 3T4 Ph: (519) 364 3200
HYBRID TURKEYS, A Division of Hendrix Genetics Ltd.
650 Riverbend Drive, Suite C, Kitchener, ON N2K 3S2 Ph: (519) 894 4719
HYBRID TURKEYS, A Division of Hendrix Genetics Ltd.
650 Riverbend Drive, Suite C, Kitchener, ON N2K 3S2
Ph: (519) 653-3527
ISA NORTH AMERICA, A Division of Hendrix Genetics Ltd.
500 Franklin Blvd., Cambridge, ON N1R 5V9 Ph: (519) 621 5191
KING COLE DUCKS LTD.
HEALTH MONITORED HATCHERIES
ARCHER’S POULTRY FARM LTD.
15754 County Rd. 2, Brighton, ON K0K 1H0
Ph: (613) 475 0820
PO Box 185, RR 3, Newmarket, ON L4G 3H3 Ph: (905) 836 9461
LAKESIDE GAME FARM
RR 1, Lakeside, ON N0M 2G0 Ph: (519) 349 2552
LOHMANN BREEDERS CANADA LTD.
180 Garden Ave., Brantford, ON N3S 7W4
Ph: (519) 758 5909
MAPLE LEAF FOODS INC
70 Heritage Drive, PO Box 370, New Hamburg, ON N0B 2G0
Ph: (519) 662 1501
MAPLE LODGE HATCHERIES LTD (Fleming Chicks Division) 4412 Ontario St., PO Box 1000, Beamsville, ON L0R 1B0 Ph: (905) 563 4914
MAPLE LODGE HATCHERIES
LTD. (Stratford Chicks Division) 17 Pine St., Stratford, ON N5A 1W2 Ph: (519) 275 2240
McCULLY CENTURY FARM
RR 3, Chatham, ON N7M 5J3 Ph: (519) 358 1622
MCKINLEY FARMS (ST. MARYS) LTD.
772 Queen St. E., St. Mary’s, ON N4X 1C2
Ph: (519) 284 1790
MILL POND HATCHERY
555 Pipeline Rd., RR 1, Grafton, ON K0K 2G0
Ph: (905) 349 2875
RYCKMAN FARMS
19914 Duart Rd., Muirkirk, ON N0L 1X0
Ph: (519) 678 3481
SILVER MAPLE GAME BIRDS
2394 Manser Rd., RR 1, Millbank, ON N0K 1L0
Ph: (519) 656 3342
TRILLIUM HATCHERY INC.
620 Wright Blvd, Stratford, ON N4Z 1H3
Ph: (519) 263-2035
THAMES RIVER HATCHERY INC.
1107 Ridgeway Road, Woodstock, ON N4V 1E3 Ph: (519) 602 0740
UNIONDALE HATCHERY
RR 3, Lakeside, ON N0M 2G0
Ph: (519) 349 2670
UPLANDS PHEASANTRY
6286 Fleming Rd., RR 1, Camlachie, ON N0N 1E0
Ph: (519) 542 7089
VAN LI FARMS
4578 Nauvoo Rd., Watford, ON N0M 2S0
Ph: (519) 859 4849
WEBFOOT FARM AND HATCHERY
RR 2, Elora, ON N0B 1S0
Ph: (519) 846 9885
WILCOX FAMILY FARM INC.
224501 Ostrander Rd., Tillsonburg, ON N4G 4H1
Ph: (519) 842 5429
WILLOWCREEK HATCHERY
RR 1, Elora, ON N0B 1S0
Ph: (519) 846 5267
REGISTERED EGG GRADING STATIONS
Ashburn
Sunnyside Farm, (Douglas Ashton & Ronald Ashton)
625 Townline Rd. W., ON L0B 1A0
Ph: (905) 655 4240
Fax: (905) 655 4240
Aylmer
Edwin Wagler
RR 4, ON N5H 2R3
Aylmer
Harold & Lillian Stoll, (Green Meadow Eggs)
11168 Springerhill Rd., ON N5H 2R3
Ph: (519) 866 3610 ext. 1
Fax: (519) 765 1217
Blackstock
Sweda Farms Ltd., (Verified Eggs Canada)
3880 Edgerton Rd., PO Box 149, ON L0B 1B0
Ph: (905) 986 5747
Fax: (905) 986 5744
Brechin
John Appleby
RR 2, ON L0K 1B0
Ph: (705) 484 5918
Chatsworth
Robert McIntyre
RR 3, ON N0H 1G0
Ph: (519) 794 3710
Chesley
Wayne & Alta Weber
723 Bruce Rd. 11, RR 3, ON N0G 1L0
Ph: (519) 363 0028
Desbarats
Samual W. Hoover, (Barber Road Egg Grading Station)
23 Barber Side Rd., RR 2, ON P0R 1E0
Douglas
Isaac Hoover
(Hoover’s Egg Grading Station)
250 McLarty Rd., RR 1, ON K0J 1S0
Dunnville
Lyle M. Packham, (Packham Poultry Farm)
RR 1, ON N1A 2W1
Ph: (905) 774 4846


2020 BOARD OF DIRECTORS

Earlton
Gwen Koch
PO Box 787, ON P0J 1E0
Ph: (705) 563 8325
Elmira
O.K. Egg Farm
RR 1, ON N3B 2Z1
Ph: (519) 669 4880
Evansville
Morley Runnalls, (Morley & Cathie Runnalls)
16454 Hwy. 540, RR 1, ON P0P 1E0
Ph: (705) 282 2356
Exeter
Miller’s Country Store
215 Pickard Rd., ON N0M 1S3
Ph: (519) 235 5000
Fax: (519) 235 6200
Fort Francis
Mark Gerber
RR 1, RMB 56, ON P9A 3M2
Ph: (519) 376 9312
Guelph
The Harvey Poultry Farm Ltd.
RR 2, ON N1H 7H8
Ph: (519) 821 9535
Guelph
Cedarvale Farm
5142 Jones Baseline, ON N1H 6H8
Ph: (519) 824 8832


Egg Farmers of Ontario’s (EFO’s) Board of Directors represent the more than 500 egg farmers and pullet growers in Ontario.
For 55 years, EFO has worked to ensure that consumers have access to safe, high-quality and reasonably priced eggs with a fair return to farmers.


Highgate
Fenton Farms
14909 Hastings Line, RR 2, ON N0P 1T0
Ph: (519) 678 3302
Huntsville
Brian Currie, (Currie’s Corner Farm)
116 Bethune Rd. N., ON P1H 2J2
Ph: (705) 909-0080
Innisfil
Bee’s Universe, (Irina & Ionel Alecu) 1773 20th Sideroad, ON L9S 4H8
Ph: (705) 436 7659
Keene
John Millar Eggs
RR 3, ON K0L 2G0
Ph: (705) 295 6565
Kent Bridge
Roesch Meats & More
10910 Northwood Line, ON N0P 1V0
Ph: (519) 351 7711
Fax: (519) 351 5771
Kitchener
Ontario Pride Eggs Inc, 860 Trillium Drive, ON N2R 1K4
Ph: (519) 741-8763





Lorne Benedict, Zone 2
Dan Veldman, Vice Chair, Zone 3
Roger Pelissero, Zone 4
Brian Miller, Zone 5
Tonya Haverkamp, Zone 6
Scott Brookshaw, Zone 7
George Pilgrim, Zone 8
Craig Hunter, Zone 9
Marc Bourdon, Zone 10
Alvin Brunsveld, Pullet Director
Scott Helps, Chair, Zone 1
Lindsay Clare Scully
RR 5, ON K9V 4R5
Ph: (705) 799 5586
Listowel
Gray Ridge Eggs Inc.
955 Tremaine Ave. S., RR 4, ON N2W 3G9
Ph: (519) 291 5150
Fax: (519) 291 3369
Lyn
Burnbrae Farms Ltd.
Box 10, RR 1, ON K0E 1M0
Ph: (613) 345 5651
Fax: (613) 345 6946
Matheson
Alvin Martin
(Spring Hollow Packaging)
2414 Hwy 11 N, ON P0K 1N0
Ph: (705) 273 1747
Milverton
Orval Zehr Eggs
RR 1, ON N0K 1M0
Ph: (519) 595 4732
Fax: (519) 595 4378
Mississauga
Burnbrae Mississauga, (Division of Burnbrae Farms Ltd.)
5434 Tomken Rd., ON L4W 1P2
Ph: (905) 624 3600
Fax: (905) 624 5298
Monkland
Ontario Pride Eggs Inc.
17350 Hwy. 43, PO Box 53, ON K0C 1V0
Ph: (613) 346 2154
Fax: (613) 346 2427
Mount Albert
Ontario Egg Master Ltd.
RR 3, ON L0G 1M0
Ph: (905) 473 3001
Navan
Bearbrook Game Meats Inc.
5396 Dunning Rd., ON K4B 1J1
Ph: (613) 835 7575
Fax: (613) 835 3685
New Liskeard
Craig Haven Farm and Gardens
RR 1, ON P0J 1P0
Ph: (705) 647 4878
Newmarket 403834 Ontario Ltd., (Homestead Specialty Foods)
983 Graham Side Rd., ON L3Y 4V9
Ph: (905) 775 2106
Fax: (905) 775 9416
Orono
Terry Hollingsworth
RR 1, ON L0B 1M0
Ph: (905) 786 2425
Fax: (905) 786 3447
Oshawa
White Feather Farms Inc.
65 Raglan Rd. E., RR 1, ON L1H 7K4
Ph: (905) 655 7694
Fax: (905) 655 3898
Owen Sound
Allan Tobey
RR 6, ON N4K 5N8
Ph: (519) 371 1194
Oxford Station
John Beking, (Beking’s Poultry Farm)
RR 1, ON K0G 1T0
Ph: (613) 258 5396
Paisley
David Weber & Ellen Weber
1230 Bruce Road 11, ON N0G 2N0
Ph: (519) 353-4113
Perth
Robert Campbell
RR 6, ON K7H 3C8
Ph: (613) 267 6461
Fax: (613) 267 6461
Rockwood
Bluehaven Farm
6089 4th Line, RR 3, ON N0B 2K0
Ph: (519) 787 1973
Fax: (519) 245 1690
Rockwood
Mykolas Kamaitis
6089 Fourth Line, ON N0B 2K0
Ph: (519) 217 7689
St-Isidore
Ferme Avicole Laviolette Ltée
4503 chemin Bourgon, ON K0C 2B0
Ph: (613) 524 2847
Fax: (613) 524 2847
Stayner
A & D Bird Seed Inc.
1617 County Rd. 42, ON L0M 1S0
Ph: (705) 428 2465

Strathroy
Maple Lynn Foods Ltd.
PO Box 127, 301 Ellor St., ON N7G 3J1
Ph: (519) 245 1630
Fax: (519) 245 1690
Strathroy
Gray Ridge Eggs Inc.
644 Wright St., ON N7G 3H8
Ph: (519) 245 0480
Fax: (519) 245 5829
Strathroy
Norman & Gayle Frisa, (Frisa Farms)
30130 Centre Rd., RR 6, ON N7G 3H7
Ph: (519) 232 4478
Fax: (519) 679 1624
Tavistock
Fred & Merna Alexander Eggs
RR 2, ON N0B 2R0
Ph: (519) 462 2478
Thunder Bay
Vanderwees Poultry Farm
RR 11, 5221 Townline Rd., ON P7B 5E2
Ph: (807) 935 2507
Fax: (807) 935 2337
Walford Station
Abraham & Minerva Frey
100 Mailloux Rd., ON P0P 2E0
Ph: (705) 844 9974
Wallaceburg
Ross McCreary, (McCreary Farms)
7651 McCreary Line, ON N8A 4L1
Ph: (519) 627 6754
Fax: (519) 627 5141
Wallenstein
Cleason F. & Mildred W. Martin, (Sunrise Egg Farm)
7310 4th Line, RR 2, ON N0B 2S0
Ph: (519) 669 7648
Warkworth
Laver Farms Ltd
372 Concession Road 2 East, ON K0K 3K0
Ph: (705) 653 6035
Waterford
Wm. Kenny Alderson, (Kenny Alderson)
RR 1, ON N0E 1Y0
Ph: (519) 443 7756
Wellesley
Local Egg Limited
111 David St., ON N0B 2T0
Ph: (519) 465 0894
Wroxeter
Hoffnung
44212 Salem Rd., RR 1, ON N0G 2X0
Yarker
Hank-John Reinink
RR 3, ON K0K 3N0
Ph: (613) 378 2479
Fax: (613) 378 2479
Zurich
Don Gingerich
RR 2, ON N0M 2T0
Ph: (519) 236 4852
REGISTERED EGG PRODUCT STATIONS
Brampton
Country Queen Foods Inc.
205 Wilkinson Rd., ON L6T 4M2
Ph: (905) 456 2460
Fax: (905) 456 3640
Brockville
Burnbrae Farms Ltd.
260 Central Ave., ON K6V 4N8
Ph: (613) 342 3960
Fax: (613) 342 8083
Etobicoke
Global Egg Corporation, (Egg Solutions, A Division of Global Egg Corp.)
283 Horner Avenue, ON M8Z 4Y4
Ph: (416) 231-2409
Fax: (416) 231 8991
Etobicoke
Global Egg Corporation, (Egg Solutions, A Division of Global Egg Corp.)
17 Newbridge Rd., ON M8Z 2L6
Ph: (416) 237 1313
Fax: (416) 237 1316
Etobicoke
Global Egg Corporation, (Egg Solutions, A Division of Global Egg Corp.)
25 Newbridge Rd., ON M8Z 2L6
Ph: (416) 354 4176
Fax: (416) 231 8991
Etobicoke
2162889 Ontario Ltd., (Supreme Egg Products Inc.)
17 Newbridge Rd., ON M8Z 2L6
Ph: (416) 237 1313
Fax: (416) 237 1316
St. Marys
Perth County Ingredients Inc.
20 Thames Rd., ON N4X 1C4
Ph: (519) 284 3449
Toronto
Global Egg Corporation, (Egg Solutions, A Division of Global Egg Corp.)
283 Horner Ave., ON M8Z 4Y4
Ph: (416) 231 2409
Fax: (416) 231 8991
Toronto
Shelmac Brand Products Inc.
1289 Caledonia Rd., ON M6A 2X7
Ph: (416) 787 1825
Fax: (416) 787 6389
POULTRY CONSULTING, VETERINARIANS, RESEARCH
A&L Canada Laboratories Inc.
2136 Jetstream Rd., London, ON N5V 3P5
Ph: (519) 457 2575
Fax: (519) 457 2664
Toll Free: (855) 837 8347 alcanadalab@alcanada.com www.alcanada.com
Activation Laboratories Ltd.
41 Bittern St., Ancaster, ON L9G 4V5
Ph: (905) 648 9611
Fax: (905) 648 9613
Toll Free: (888) 228 5227 (ACTLABS) ancaster@actlabs.com www.actlabs.com
Elfrida Poultry Diagnostic Services
1354 Stoney Creek Rd., Caledonia, ON N3W 1R2
Ph: (905) 765 2177
Gateway Centre of Excellence In Rural Health
74 Kingston St., Upper Level, Goderich, ON N7A 3K4
Ph: (519) 612 1053 info@gatewayruralheatlh.ca www.gatewayruralhealth.ca
Intertek - Cargo Inspection & Testing
Hamilton – Unit 1, 710 South Service Road, ON L8E 5S7
Ph: (905) 529 0090
Sarnia – 269A St. Andrew St Unit 1, ON N7T 2L3
Ph: (519) 336 5112
Thunder Bay – 960C Alloy Dr., ON P7B 6A4
Ph: (807) 345 5392 www.intertek.com
Lakeside Poultry Veterinary Services Inc.
Unit A, 240 Graff Ave., Stratford N5A 6Y2
Ph: (519) 273 9090
Fax: (519) 273 2002
Toll-Free: 1-855-998-9090 www.lakesidepoultryveterinaryservices.com
Dr. Shahbaz Haq, M.Sc. (Vet Pathology), D.V.M., Dip ACPV
Lloyd Weber Consulting Services 519 Maltby Rd., Guelph, ON N1L 1G3 Ph: (519) 821 5963 Fax: (519) 821 2841
Dr. L.J. Weber, D.V.M., Poultry Health Consultant
Poultry Health Services
500 Wright Blvd, Stratford, ON N4Z 1H3
Ph: (888) 950 2252 phsinfo@poultryhealth.ca
SGS Canada Inc.
1 - 503 Imperial Rd. N., Guelph, ON N1H 6T9
Ph: (519) 837 1600 Fax: (519) 837 1242 www.sgs.ca
SGS Canada Inc. 6490 Vipond Dr., Mississauga, ON L5T 1W8 Ph: (905) 364 3757 www.sgs.com
Smith & Weisz Poultry Veterinary Services
237 Arnold St. Unit 4, Kitchener, ON N2H 6E8
Dr. Alex Weisz
Ph: (519) 741 5779
Fax: (519) 741 5682
Zorra Veterinary Services
RR 2, 235806 23rd Line
Thamesford, ON N0M 2M0
Ph: (519) 283 6081
PROVINCIAL GOVERNMENT UNIVERSITIES
AGRICULTURE AND AGRI-FOOD CANADA
Ontario regional office 174 Stone Rd., W., Guelph, ON N1G 4S9
Ph: (226) 217 8143
Fax: (226) 217 8187 aafc.atsbulletinon-bulletinseaon. aac@canada.ca
www.agr.gc.ca
AGRICULTURE, FOOD AND RURAL AFFAIRS APPEAL TRIBUNAL
1 Stone Rd. West, Guelph ON N1G 4Y2
Ph: (519) 826 3433
Fax: (519) 826 4232 www.omafra.gov.on.ca/english/ tribunal/index.html
CANADIAN FOOD INSPECTION AGENCY
Regional Office - Central 259 Woodlawn Rd. W., Suite A, Guelph, ON N1H 8J1
Ph: (226) 217 1200
Fax: (226) 217 1211
Regional Office - North East 500 Huronia Rd., Unit 103, Barrie, ON L4N 8X3
Ph: (705) 739 0008
Fax: (705) 739 0405
Regional Office - Ontario 174 Stone Rd. W., Guelph, ON N1G 4S9
Ph: (226) 217 8555
Fax: (226) 217 8495
Regional Office - South West 1200 Commissioners Rd. E., Unit 19, London, ON N5Z 4R3
Ph: (519) 691 1300
Fax: (519) 691 1314
Regional Office - Toronto 1124 Finch Ave. W., Unit 2, Toronto, ON M3J 2E2
Ph: (647) 790 1100
Fax: (647) 790 1104
ROSS DELIVERS
• Leading FCR
• Impressive Daily
• Strong Livability ROSS 708
• Highest Yield
• Excellent Breeder
Performance
• Exceptional Livability

ONTARIO FARM PRODUCTS MARKETING COMMISSION
Ministry of Agriculture, Food and Rural Affairs
1 Stone Rd. W., Guelph ON N1G 4Y2
Ph: (519) 826 3100 (General inquiry) Ph: (877) 424 1300 (AICC) ontariofarm.productsmarketing. omafra@ontario.ca www.omafra.gov.on.ca/english/ farmproducts
ONTARIO MINISTRY OF AGRICULTURE AND FOOD MINISTRY OF RURAL AFFAIRS
Ontario Veterinary College, University of Guelph, 50 Stone Road e., Guelph ON N1G 2W1
Ph: (519) 824 4120 Fax: (519) 837 3230 www.ovc.uoguelph.ca
Al Dam, Provincial Poultry Specialist, Dept of Pathobiology, OVC, Room 4841
Ph: (519) 824 4120 ext 54326 al.dam@ontario.ca; Csaba Varga, Lead Veterinarian, Disease Prevention - Poultry, Dept of Pathobiology, OVC, Room 4840. Ph: (519) 824 4120 ext. 54650 csaba.varga@ontario.ca.
ANIMAL HEALTH
LABORATORY, LABORATORY SERVICES DIVISION
University of Guelph, PO Box 3612, Guelph ON N1H 6R8
Ph: (519) 824 4120 ext 54530
Fax: (519) 827 0961 ahlinfo@uoguelph.ca www.uoguelph.ca/ahl/ Avian and Fur-Bearing Pathologists: Dr. Marina Brash, Dr. Emily Martin, Dr Margaret Stalker.
ONTARIO ANIMAL HEALTH NETWORK (OAHN)
Animal Health Laboratory, University of Guelph Building 89, 419 Gordon St., Guelph, ON N1G 2W1
Ph: (519) 824 4120 ext. 53364 oahn@uoguelph.ca www.oahn.ca
Poultry Network: Dr. Alison Moore, Co-lead OMAFRA; Dr. Marina Brash, Animal Health Laboratory; Dr. Mike Petrik, Private Practitioner; Dr. Cynthia Philippe, Private Practitioner; Dr. Fernando Salgado-Bierman, Private Practitioner; Dr. Alex Weisz, Private Practitioner; Dr. Michele Guerin, Ontario Veterinary College; Dr. Tim Pasma, Epidemiologist, OMAFRA; Dr. Kate Todd, OAHN Coordinator, Animal Health Laboratory.
ONTARIO VETERINARY COLLEGE
University of Guelph, 50 Stone Rd. E., Guelph ON N1G 2W1
Ph: (519) 824 4120 ext 54401
Fax: (519) 837 3230 ovc.uoguelph.ca
POULTRY HEALTH RESEARCH NETWORK
Dept. of Pathobiology, Ontario Veterinary College
University of Guelph, 50 Stone Rd. E., Guelph ON N1G 2W1
Ph: (519) 824 4120
Fax: (519) 824 5930 www.phrn.net
Advisory Board – Dr Shayan
Sharif, Dr John Lumsden, Dr Eva Nagy, Dr Michele Guerin, Dr Tina Widowski, Tim Nelson, Dr Bruce Roberts.
UNIVERSITY OF GUELPH, Department of Animal Biosciences (ABSc)
50 Stone Rd. E., Guelph ON N1G 2W1
Ph: (519) 824 4120 ext 56219
Department Chair: James Squires, Professor and Chair
Ph: 519-824-4120 ext 53928, jsquires@uoguelph.ca. animalbiosciences.uoguelph.ca
INDUSTRY ASSOCIATIONS
National Farm Business Management Resource Centre
100 Stone Rd. W., Unit 303, Guelph, ON N1G 5L3
Ph: (519) 822 6618
info@fmc.gac.com www.takeanewapproach.ca
Association of Ontario Chicken Processors
52 Royal Rd., Guelph, ON N1H 1G3
Ph: (519) 836 8383
Chicken Farmers of Ontario PO Box 5035, 3320 S. Service Rd., Burlington, ON L7R 3Y8
Ph: (905) 637 0025
Fax: (905) 637 3464
24/7 CFO Connects: (855) 800 4815
24/7 Emergency Hotline: (877) 767 2973
info@ontariochicken.ca www.ontariochicken.ca
Board Director: Adrian Rehorst, 2nd Vice Chair, District 1; Rick Kaptein, CFC Alternate Rep, CBC Rep, District 2; Brian Lewis, District 3; Tom Beischlag, District 4; Jordan Fois, FFC Ontario Rep, District 5; Murray Opsteen, 1st Vice-Chair, District 6; Ed Benjamins, Chair, District 7; Scott Buchan, PIC Rep, District 8; Tim Klompmaker, CFC Rep, District 9.
Egg Farmers of Ontario 7195 Millcreek Dr., Mississauga, ON L5N 4H1
Ph: (905) 858 9790
Fax: (905) 858 1589
general@getcracking.ca www.getcracking.ca
Scott Helps, Chair, Zone 1; Lorne Benedict, Zone 2; Dan Veldman, Vice Chair, Zone 3; Roger Pelissero, Zone 4; Brian Miller,
Zone 5; Tonya Haverkamp, Zone 6; Scott Brookshaw, Zone 7; George Pilgrim, Zone 8; Craig Hunter, Zone 9; Marc Bourdon, Zone 10; Alvin Brunsveld, Pullet Director. Bill Mitchell, Interim General Manager.
Farm & Food Care Ontario 660 Speedvale Ave. W., Unit 302, Guelph, ON N1G 5L3
Ph: (519) 837 1326 info@farmfoodcare.org www.farmfoodcare.org
Ontario Agri Business Association (OABA - Feed Section Committee - ANACOntario Division)
104 - 160 Research Lane, Guelph, ON N1G 5B2
Ph: (519) 822 3004
Fax: (519) 822 8862 info@oaba.on.ca www.oaba.on.ca
Board of Director: Nadine Schwandt, President; Richard Smibert, Past President; Claude Gauthier, Vice President; John Taylor, Treasurer. Director: Dave Bender, Andrew Coghlin, Matt Gardner, Kevin Weppler, John Taylor, Jim Campbell, Martin Kiefer, Cassandra Loomans, Justin Merner. Dave Buttenham, Chief Executive Officer.
Ontario Association of Poultry Veterinarians, OAPV
Animal Health Lab, University of Guelph, PO Box 3612, Guelph, ON N1H 1R8 Ph: (519) 824 4120 ext 54550
Ontario Broiler Chicken Hatching Egg Producers Association 483 Arkell Rd., Puslinch, ON N0B 2J0 Ph: (519) 821 0657 obchepa@golden.net www.obchepa.ca
John Kapteyn, Chair; Melissa Sinnige, Vice-All; Nick Daunt, Secretary-Treasurer; OBHECC Directors: Tim Hutten, John Kapteyn, Ed Mosterd, Mark Woods. OBCHEPA Director: Paul Groen. Farm and Food Care Rep: Keith Veenhof; Office Administrator: Annette Lewis-Copeland.
Ontario Broiler Hatching Egg & Chick Commission (OBHECC) 213 - 251 Woodlawn Rd. W., Guelph, ON N1H 8J1 Ph: (519) 837 0005 Fax: (519) 837 0464 info@obhecc.com www.obhecc.com
Ontario Federation of Agriculture
Ontario AgriCentre, 206 - 100 Stone Rd. West, Guelph, ON N1G 5L3
Ph: (519) 821 8883
Fax: (519) 821 8810
Toll Free: (800) 668 3276 www.ofa.on.ca
Keith Currie, President, Zone 13; Mark Reusser,Vice President, Zone 9; Peggy Brekveld, Vice President, Director at-Large; Drew Spoelstra, Executive Member, Zone 5. Directors: Louis Roesch, Zone 1; Paul Vickers, Zone 2; Larry Davis, Zone 3; Tracey Arts, Zone 4; Crispin Colvin, Zone 6; Brent Royce, Zone 7; Jennifer Doelman, Zone 8; Steve Brackenridge, Zone 10; Jackie Kelly-Pemberton, Zone 11; Bruce Buttar, Zone 12; Rejean Pommainville, Zone 14; Mark Kunkel, Zone 15. Directors at-Large: Teresa Van Raay, Hugh Simpson.
Ontario Hatcheries Association
39 William St., Elmira, ON N3B 1P3
Ph: (519) 669 3350
Fax: (519) 669 3826 info@ontariohatcheries.ca www.ontariohatcheries.ca
Paul Martindale, President; Directors: David Brock, Aden Frey, Devin Hanna, Camera Struth, Jeff Wilson. Susan Fitzgerald, Executive Director.
Ontario Institute of Agrologists PO Box 1100, 60 Elora St., S., Harriston, ON N0G 1Z0
Ph: (519) 510 4047 www.oia.on.ca
Mike Dougherty, President (Guelph); Robert Alton, Vice President; Andy Van Neikerk, Treasurer (Huronia Branch); Directors: Adolph Ng (Central), Dan Roberts (HamiltonNiagara), Bethany Davidson-Eng (At-large); Wes Kennedy (Ottawa-St. Lawrence); Gary Eagleson (Western). Ryan Koeslag, Executive Director
Ontario Livestock and Poultry Council
39 Williiam St., Elmira, ON N3B 1P3
Ph: (519) 669 3350
Fax: (519) 669 3826
Laura.tflo@bell.net www.ontlpc.ca
Ontario Soil and Crop Improvement Association 1 Stone Rd. W., Guelph, ON N1G 4Y2
Ph: (519) 826 4214
Fax: (519) 826 4224
Toll Free: (800) 265 9751 oscia@ontariosoilcrop.org www.ontariosoilcrop.org
Board of Directors: Harold Rudy (Honorary President), Stuart Wright, Chad Anderson, Warren Schneckenburger, Steve Sickle, Les Nichols, Phil Oegema, John Poel, Andy van Niekerk, Paul Hagey, Mark Burnham, Eleanor Renaud, Birgit Martin, Stefan Szeder. Andrew Brekveld, Executive Director.

Poultry Industry Council
483 Arkell Rd., Puslinch, ON NOB 2J0
Ph: (519) 837-0284
pic@poultryindustrycouncil.ca
www.poultryindustrycouncil.ca
Board Officers: Ed Verkley, Chair; Charlie Elliott, Vice Chair; Patricia Botter, Treasurer. Directors at Large: Laura Bowers, Scott Buchan, Caroline Gonano, Greg Lansink, Brian Miller, Marg Pritchard, Babak Sanei, Mike Terpstra, Bill Van Heeswyk. Staff: Ashley Honsberger, Executive Director
Turkey Farmers of Ontario
1120 - 100 Conestoga College Blvd., Kitchener, ON N2P 2N6
Ph: (519) 748 9636
Fax: (519) 748 2742
www.turkeyfarmers.on.ca
Ryan Brown, General Manager
PRINCE EDWARD ISLAND
REGISTERED EGG GRADING STATIONS
Freetown
Burns Poultry Farm & Chick Hatchery Ltd.
269 Freetown, RR 2, PE C0B 1L0
Ph: (902) 887 2156
Summerside
Maritime Pride Eggs Inc.
26172 Route 2, PE C1N 4J8
Ph: (902) 667 2015
POULTRY CONSULTING, VETERINARIANS, RESEARCH
Perennia
199 Dr. Bernie MacDonald Dr., Bible Hill, NS B6L 2H5
Ph: (902) 896 0277
Fax: (902) 896 7299 info@perennia.ca www.perennia.ca
PROVINCIAL GOVERNMENT UNIVERSITIES
AGRICULTURE AND AGRI-FOOD CANADA
Prince Edward Island regional office 440 University Ave., 3rd Floor, Charlottetown, PE C1A 4N6
Ph: (902) 370 1500
Fax: (902) 370 1511 aafc.atsbulletin-bulletinsea.aac@ canada.ca
www.agr.gc.ca
CANADIAN FOOD
INSPECTION AGENCY
Regional Office - Prince Edward Island 690 University Ave.,
Charlottetown, PE C1E 1E3
Ph: (902) 566 7290
Fax: (902) 566 7334
DEPARTMENT OF AGRICULTURE AND FISHERIES, GOVERNMENT OF PRINCE EDWARD ISLAND
Jones Building, 5th Floor, 11 Kent St., PO Box 2000, Charlottetown, PE C1A 7N8
Ph: (902) 368 4880
Fax: (902) 368 4857
Toll Free: (866) PEI-FARM (734-3276) DeptAgLand@gov.pe.ca www.princeedwardisland.ca
INDUSTRY ASSOCIATIONS
ANAC - Atlantic Division
Matthew Miller, Chairman; Neil Campbell, Vice-Chairman. Director: Anne Beaumont, Katelyn O’Connell (NS), Ed Doyle (NL), Jeff Dean (PEI). Director-at-Large: Ashley Gillcrist, Dave Seeley. Chicken Farmers of Prince Edward Island PO Box 40052, West Royalty Post Office, Charlottetown, PE C1E 0J2
Ph: (902) 838 4108
Kevin MacPhail, Chair; Janet Hilliard-Murphy, Manager
Egg Farmers of Prince Edward Island
420 University Ave., Charlottetown, PE C1A 7Z5
Ph: (902) 892 8401
Fax: (902) 566 2755 info@eggspei.ca www.eggspei.ca
John Dennis, Chair; Tim Churchill, Vice Chair; Nathan Burns, Secretary Treasurer; Ian Simmons, Egg Farmers of Canada Director, Peter Stavert. Michael Cummiskey, General Manager.
QUÉBEC
HEALTH MONITORED HATCHERIES
CANARDS DES MONTS INC.
145 Rang Des Dix Terres 410, Ville Rougemont, QC J0L 1M0
Ph: (450) 469 4362
CANARDS DU LAC BROME LTÉE
40, Centre Road, Knowlton, QC J0E 1V0
Ph: (450) 242 3825
COUVOIR BOIRE & FRÈRES INC. 532 Concession 9th, Wickham, QC J0C 1S0
Ph: (819) 398 6645
COUVOIR LES EMBRYONS DE LANAUDIERE
165, rue des Entreprises, Notre-Dame des Prairies, QC J6E 7Y8
Ph: (450) 755 1160
COUVOIR OVAC 2565, rue Thérèse-Casgrain, St-Nicéphore, QC J2A 4J5
Ph: (819) 398 6807
COUVOIR OVO
180 Noel Lecompte, Acton Vale QC J0H 1A0
Ph: (819) 314 7630
COUVOIR PINTABO INC.
410, chemin Yamaska, St-Germain de Grantham, QC J0C 1K0
Ph: (819) 395 5495
COUVOIR PROVINCIAL ARTHABASKA (COOP Fédéré de Québec)
165, rue Laurier Est., Victoriaville, QC G6P 6P8
Ph: (819) 357 8480
COUVOIR QUEBEC INC. 11605, boul. de la Colline, Loretteville, QC G2A 2E1
Ph: (418) 842 3687
COUVOIR SCOTT LTÉE 1798, rue Kennedy, Scott, QC G0S 3G0
Ph: (418) 387 2323
COUVOIR SÉLECT INC.
241, rue Principale, St-Adelphe, QC G0X 2G0
Ph: (418) 322 5927
COUVOIR UNIK INC.
222, Route 104, Mont St-Grégoire, QC J0T 1K0
Ph: (450) 347 0176
FERME D’ORLÉANS ENR.
2210, chemin Royale, Saint-Laurent-de-l’Île-d’Orléans, QC G0A 3Z0
Ph: (418) 828 2686
FERME KÉGO CAILLES ENR. 60 du Manoir St. W., Cap St-Ignace, Montmagny, QC G0R 1H0
Ph: (418) 246 5012
LA FERME DU PLATON 6930, rue Marie-Victorin, Ste-Croix-de-Lobinere, QC G0S 2H0
Ph: (418) 926 2444
RÉAL CÔTÉ INC.
329, rue St-Georges, Ange-Gardien, QC J0E 1E0
Ph: (450) 293 3191
REBÉ POIRIER LTEÉ (Section
Couvoir Ramsay)
390, rue Joliette, St-Félix de Valois, QC J0K 2M0
Ph: (450) 889 5824
REGISTERED EGG
GRADING STATIONS
Cité Charlevoix
Ferme du Paysan
41, rang St-Jean Baptiste St-Urbain, QC G0X 1R0
Ph: (418) 639 2587
Huntington
Les Fermes Valens Inc.
79 York St., QC J0S 1H0
Ph: (450) 264 4061
Fax: (450) 264 9319
Rivière-Héva
Les Oeufs Richard Eggs Inc. 728, route St-Paul sud, RR 1, QC J0Y 2H0
Ph: (819) 757 4419
Fax: (819) 757 3742
St-Bruno du Lac St-Jean 9392-9818 Québec Inc. 1097, 8e rang nord, QC G0W 2L0
Ph: (418) 695 9955
St-Eustache
Les Aliments Mise en Bouche Inc.
170, boul industriel, QC J7R 5C2
Ph: (514) 961 9322
St-Hyacinthe
Nutri-Oeuf St-Hyancinthe Inc. 6655, rue Picard, QC J2S 1H3
Ph: (450) 771 4627
Fax: (450) 773 9485
St-Lambert
Les Oeufs Ovale Inc, 205, rue Damase-Breton, QC G0S 2W0
Ph: (450) 771 4627
Fax: (450) 773 9485
St-Léonard
Geo. E. Vandelac Inc. 7860, rue Fleuricourt, QC H1R 2L3
Ph: (514) 327 4654
Fax: (514) 327 4655
St-Théodore D’Acton Clovis Gauthier et Fils Inc.
170, 6e rang, QC J0H 1Z0
Ph: (450) 546 7430
Fax: (450) 546 0278
St-Zotique
Ferme St-Zotique Ltée, (Bon-EE-Best) 200, 69e avenue, QC J0P 1Z0
Ph: (450) 267 3521
Fax: (450) 267 0636
Ville Dégelis
Ferme Hermel Dubé et Fils Inc. 1549, chemin de l’Arc-en-Ciel, QC G5T 1B7
Ph: (418) 853 9197
Fax: (418) 853 3807
REGISTERED EGG PRODUCT STATIONS
Lyn Burnbrae Farms Ltd
(Les Oeufs Bec-o Inc)
3356 County Road #27, QC K0E 1M0
Ph: (450) 549 4524
Fax: (450) 549-4675
Montreal Carrément Tarte Inc.
5563 rue fullum, #200, QC Ph : (514) 402 8607
St-Eustache
Akme Poultry, Butter & Eggs
Distributors Inc
65 rue Pépin QC J7R 6Z8
Ph : (450) 974-7767
St-Eustache
Les Aliments Mise en Bouche Inc
170, boul industriel, QC J7R 5C2
St-Hyacinthe
Vitoeuf Inc.
3475, rue Picard, QC J2S 1H3
Ph: (450) 778 1991
Fax: (450) 773 0776
PROVINCIAL GOVERNMENT UNIVERSITIES
AGRICULTURE AND AGRI-FOOD CANADA
Quebec regional office
2001 Robert-Bourassa Blvd., Room 671-M, Montréal, QC H3A 3N2
Ph: (514) 283 8888
Fax: (514) 496 3966 aafc.qdro-brmq.aac@canada.ca www.agr.gc.ca
CANADIAN FOOD INSPECTION AGENCY
Regional Office - Quebec
2001 Robert-Bourassa Blvd., Room 671, Montréal, QC H3A 3N2
Ph: (514) 283 8888
Fax: (514) 283 3143 www.inspection.gc.ca
CANADIAN FOOD INSPECTION AGENCY
Regional Office - Montreal
2001 Robert-Bourassa Blvd., Room 671, Montréal, QC H3A 3N2
Ph: (514) 283 8888
Fax: (514) 283 3143 www.inspection.gc.ca
CANADIAN FOOD INSPECTION AGENCY
Regional Office – Quebec City Place Iberville IV, 100 - 2954, Laurier Blvd., Ste-Foy, QC G1V 5C7
Ph: (418) 648 7373
Fax: (418) 648 4792
CANADIAN FOOD INSPECTION AGENCY
Regional Office - St-Hyacinthe 3225 Cusson Ave., Suite 4500, St-Hyacinthe, QC J2S 0H7
Ph: (450) 768 1500
Fax: (450) 768 1473
FACULTÉ DES SCIENCES DE L’AGRICULTURE ET DE L’ALIMENTATION, Pavillon Paul-Comtois 2425, rue de l’Agriculture, local 1122, Québec (Québec) G1V 0A6
Ph: (418) 656 3514
fsaa@fsaa.ulaval.ca www.fsaa.ulaval.ca
MINISTÈRE DE L’AGRICULTURE, DES PÊCHERIES ET DE L’ALIMENTATION DU QUÉBEC (MAPAQ)
200, chemin Sainte-Foy, Québec QC G1R 4X6
Ph: (418) 380 2110
Toll Free: (888) 222-MAPA (6272) info@mapaq.gouv.qc.ca
www.mapaq.gouv.qc.ca
RÉGIE DES MARCHÉS AGRICOLES ET ALIMENTAIRES DU QUÉBEC
201, boul. Crémazie Est., 5e étage, Montréal QC H2M 1L3
Ph: (514) 873 4024
Fax: (514) 873 3984
rmaaqc@rmaaq.gouv.qc.ca www.rmaaq.gouv.qc.ca



• Exacon’s brand name since 1987
• Available in sizes 12” to 60”
• White or Black polyethylene flush mount housings
• Designed to meet the rigorous demands of farm/agricultural ventilation
• Energy efficient Multifan, MFlex or North American motors
• Fiberglass housings available in 50” and 60” diameter
TPI WALL AND CEILING INLETS
• TPI is a well known manufacturer of high quality polyurethane inlets

• High quality and high insulation value results in precise manufacturing delivering high tolerance for better ventilation control
• Wall inlets, ceiling inlets and tunnel inlets
• TPI wind hoods and wind hoods with built-in light trap also available
PUR AG AIR FILTRATION SYSTEM

• High quality L7 Pathogen barrier filter with prefilter significantly reduces the chance of air transmitted diseases. (ie bird flu and other influenza viruses)
• Clarcor provides a complete system such as filter housing frame designed for eaves and side air inlets
• This system makes installation of filters easy and practical plus reduces the risk of non-filtered air from entering the building
GREENBREEZE BASKET FAN
• Designed for more air flow and consistent pattern
• Precise guard spacing reduces air restriction

• Easy to open front guard allows easy cleaning
• Includes hanging bracket to allow direction adjustment
• Variable speed, efficient motor 115/230v
GENIUS I-TOUCH VENTILATION CONTROL
The well known and proven Genius control line is now available as a Touchscreen interface
• Navigates like an I-Pad by simply touching, swiping or dragging on a 7” or 10” touch screen

• Available with up to 8 variable stages and between 15 to 30 on/off relays
A slave is available to expand to 50 on/off relays
• Many options including light control, bird scales, perch scales and bin scales
• Built-in wifi allows easy access to the internet for managing, viewing and recording history on FarmQuest website
LIGHT TRAP/DARK OUT
• High light reduction
• Low resistance to air flow
• Simple Installation
• Easy to clean
• Uses P.v.c. snap release spacers

DEPARTMENT OF ANIMAL SCIENCE,
McGill University, Macdonald Campus, 21111 Lakeshore Rd., Ste. Anne de Bellevue QC H9X 3V9
Ph: (514) 398 7773
Fax: (514) 398 7990 animal.science@mcgill.ca www.mcgill.ca/animal/ Professor Raj Duggavathi, Departmental Chair
UNIVERSITÉ DE MONTRÉAL, Faculté de médecine vétérinaire/ College of Veterinary Medicine 3200, rue Sicotte, St-Hyacinthe QC J2S 2M2 Ph: (450) 773 8521 Fmv.umontreal.ca/fmv/
INDUSTRY ASSOCIATIONS
AQINAC - Association Québécoise des Industries de Nutrition Animale et Céréalière 4790, rue Martineau, bureau 100, Saint-Hyacinthe, QC J2R 1V1 Ph : (450) 799 2440 info@aginac.com
Directeurs et administrateurs: Christian Breton, Président; Yvan Lacroix, Président-directeur général; Renald Mercier, 1er
vice-président; Claude Robitaille, 2e vice-président; Hélene Cliche, Trésoriere; Raymond Breton, Secrétaire. Administratrice/Administrateurs: Sylvain Vallée, Carl Boivin, Patrice Gagnon, Mario Coté, Patrice Gagnon, Maurice Hénault, Renée Henri, Sébastien Léveillé, Luc Ménard, Daniel Richard, Francois Bécotte, Carl Lessard.
Association des abattoirs avicoles du Québec (AAAQ)
216, rue Denison Est, Granby, QC J2H 2R6
Ph: (450) 349 1521
info@conseiltaq.com
https://conseiltaq.com/association/ cqtv
Les Membres du ca: Yvan Brodeur, Président ; Jean-Patrick Laflamme, 1er vice-président; Dominique Martel, 2e vice-président; Christian Bazinet, Secrétaire
Géneral Par Intérim; Administrateurs: Bruno Giannone, Tony Palladino, Vincent Vecchio.
Conseil de la transformation alimentaire du Québec (CTAQ)
216, Rue Denison Est, Granby, QC J2H 2R6
Ph: (450) 349 1521
info@conseiltaq.com www.conseiltaq.com
Fédération des producteurs d’oeufs du Québec
Maison de l’UPA
555, boul. Roland-Therrien, bureau 320, Longueuil, QC J4H 4E7
Ph: (450) 679 0530
Fax: (450) 679 0855 www.oeuf.ca
Paulin Bouchard, Président; Gislain Houle, 1er vice-président; Sylvain Lapierre, 2e vice-président; Le conseil d’administration: Nicholas Tremblay, Danny Guillemette, Emmanuel Destrijker, Jean-Philippe Désilets, Maryse Labbé, Maurice Richard. Les Éleveurs de volailles du Québec
555, boul. Roland-Therrien, bur. 250, Longueuil, QC J4H 4G1
Ph: (450) 679 0530
Fax: (450) 679 5375 www.volaillesduquebec.qc.ca
Comité exécutif : Président : Pierre-Luc Leblanc; 1er vice-président : Louis-Philippe Rouleau, 2e vice-président: Martin Lemieux. Membres: Stéphane Veilleux, Daniel Husereau.
Les Producteurs d’oeufs d’incubation du Québec
555 boul. Roland-Therrien, bureau 515, Longueuil, QC J4H 4E7
Ph: (450) 679 0530
Fax: (450) 679 3652 incobec@upa.qc.ca chep-poic.ca
Pierre Belleau, Directeur; Gyslain Loyer, Président; Gyslain Loyer, administrateur a POIC.
SASKATCHEWAN
HEALTH MONITORED HATCHERIES
KYLE HATCHERY
PO Box 250, Kyle, SK S0L 1T0
Ph: (306) 375 2910
LILYDALE-SOFINA FOODS, INC.
604 Greer St., Wynyard, SK S0A 4T0
Ph: (306) 554 2534
PRAIRIE PRIDE CHICK SALES
LTD.
PO Box 273, Grandora, SK S0K 1V0
Ph: (306) 956 3822
Canadian Hatching Egg Producers
21 Florence Street
Ottawa, Ontario
K2P 0W6
Telephone: (613) 232-3023 Fax: (613) 232-5241
Email: info@chep-poic.ca
Board of Directors 2020: Brian Bilkes, Chair; Gyslain Loyer, Vice-Chair, Quebec; Dean Penner, Second Vice-Chair, Manitoba; Calvin Breukelman, British Columbia; Kevin Tiemstra, Alberta; Mike Wurtz, Saskatchewan; Mark Woods, Ontario; Christian Trottier, Canadian Hatchery Federation; Sunny Mak, Canadian Hatchery Federation
REGISTERED EGG GRADING STATIONS
Brownlee
Hutterian Brethren of Huron Ltd., (Huron Poultry Farm)
PO Box 9, SK S0H 0M0
Ph: (306) 759 2685
Fax: (306) 759 2680
Hodgeville
Hutterian Brethren Church of Hodgeville Inc., (Hodgeville Poultry Farm)
PO Box 386, SK S0H 2B0
Ph: (306) 677 2870
Fax: (306) 677 2724
Humboldt
Arden Dust, (Dusty Inn Farm)
PO Box 2742, SK S0K 2A0
Ph: (306) 682 3466
Fax: (306) 682-3466
Leader
Hutterian Brethren Church of Estuary (Estuary Colony)
PO Box 220, SK S0N 1H0
Ph: (306) 628 4116
Fax: (306) 628 4406
Maple Creek
Cypress Hutterian Brethren Colony
PO Box 98, SK S0N 1N0
Ph: (306) 662 3456
McMahon
Wheatland Eggs
PO Box 115, SK S0N 1M0
Ph: (306) 773 9196
Moose Jaw
Baildon Hutterian Brethren Ltd., (Moose Jaw Poultry Farm)
PO Box 968, SK S6H 4P6
Ph: (306) 693 3013
Saskatoon
Star Egg Company Ltd.
1302 Quebec Ave., SK S7K 1V5
Ph: (306) 244 4041
Fax: (306) 664 6619
Star City
Star City Colony Ltd., (Star City Poultry)
PO Box 190, SK S0E 1P0
Ph: (306) 863 2343
Warman
Prairie Sunrise Eggs
Box 585, SK S0K 4S0
Ph: (306) 239 2051
POULTRY CONSULTING, VETERINARIANS, RESEARCH
Canadian Poultry Consultants Ltd.
Ph: (877) 449 3447 admin@canadianpoultry.ca www.canadianpoultry.ca
Verus Animal Nutrition
3220 Roblin Blvd., Winnipeg, MB R3R 0C3
Ph: (204) 414 9400
Fax: (204) 414 9405 www.verusalliance.com
PROVINCIAL GOVERNMENT UNIVERSITIES
AGRICULTURE AND AGRI-FOOD CANADA
Saskatchewan regional office
300 - 2010 12th Ave., Regina, SK S4P 0M3
Ph: (306) 523 6601
Fax: (306) 780 7360
aafc.atsbulletinsk-bulletinseask. aac@canada,ca
www.agr.gc.ca
AGRICULTURE KNOWLEDGE CENTRE, MINISTRY OF AGRICULTURE, GOVERNMENT OF SASKATCHEWAN
45 Thatcher Dr. E., Moose Jaw, SK S6J 1L8
Ph: (306) 694 3727
Toll Free: (866) 457 2377 www.saskatchewan.ca
CANADIAN FOOD INSPECTION AGENCY -
Regional Office - Saskatchewan 1800 11th Ave.,
Room 301, Regina, SK S4P 4E3
Ph: (306) 780 5180
Fax: (306) 780 5177
www.inspection.gc.ca
CANADIAN FOOD INSPECTION AGENCY -
Western Area Office 1115 57th Ave. NE,
Calgary, AB BC AB SK MB T2E 9B2
Ph: (587) 230 2200
Fax: (587) 230 2253
www.inspection.gc.ca
ANIMAL HEALTH UNIT
Saskatchewan Ministry of Agriculture,
Room 202, 3085 Albert St., Regina SK S4S 0B1
Ph (306) 787 5547
Dr. Betty Althouse, Director/Chief Veterinary Officer betty.althouse@gov.sk.ca
SASKATCHEWAN AGRI-FOOD COUNCIL
302 - 3085 Albert St., Regina SK S4S 0B1
Ph: (306) 787 5364
Ryan Mulatz, Industry Development Specialist ryan.mulatz@gov.sk.ca
CANADIAN FEED RESEARCH CENTRE, University of Saskatchewan 10029 Marquis Ave., North Battleford, SK S9A 3W2
Ph: (306) 966 4279
Rex Newkirk, Research Chair in Feed Processing Technology rex.newkirk@usask.ca www.usask.ca
IT’S ALWAYS THERE RAIN OR SHINE, INDOORS OR OUT GUARDING ITS TURF MOSQUITOES, TICKS, FLIES AND BEETLES STEP INTO ITS KILL ZONE AND MEET YOUR WORST NIGHTMARE

MOST PREMISE SPRAYS DON’T STAND UP TO ADVERSE WEATHER AND WASHING –LEAVING LIVESTOCK EXPOSED TO PAINFUL, ANNOYING PESTS. NEW ANNIHILATOR POLYZONE ® INSECTICIDE OFFERS 12 WEEKS 1 OF RESIDUAL CONTROL, EVEN WHEN EXPOSED TO WATER. WITH PROPRIETARY POLYZONE ® TECHNOLOGY, THE ACTIVE INGREDIENT, DELTAMETHRIN, REMAINS ADHERED TO SURFACES, RESULTING IN A CONTROLLED, SLOW RELEASE “KILL ZONE” THAT STANDS UP TO THE ELEMENTS. THAT MEANS FEWER APPLICATIONS, LESS WORK AND MORE SAVINGS.

DEPARTMENT OF ANIMAL AND POULTRY SCIENCE, College of Agriculture and Bioresources, University of Saskatchewan, Room 6D34 Agriculture Bldg., 51 Campus Dr., Saskatoon SK S7N 5A8
Ph: (306) 966 4128
Fax: (306) 966 4151 aps@usask.ca https://agbio.usask.ca/departments/ animaland-poultry-science.php
WESTERN COLLEGE OF VETERINARY MEDICINE, University of Saskatchewan 52 Campus Dr., Saskatoon SK S7N 5B4
Ph: (306) 966 7447
Fax: (306) 966 8747 www.usask.ca/wcvm
INDUSTRY ASSOCIATIONS
Chicken Farmers of Saskatchewan 224 Pacific Ave., Suite 201, Saskatoon, SK S7K 1N9
Ph: (306) 242 3611 info@saskatchewanchicken.ca www.saskatchewanchicken.ca
Henry Van EE, Chair Graham Snell, Executive Director
Saskatchewan Broiler Hatching Egg Producers 115 – 2nd Ave North, Suite 301, Saskatoon, SK, S7K 2B1
Ph: (306) 384 8050
Saskatchewan Egg Producers 1 – 123 Pinehouse Drive, Saskatoon, SK S7W 5W1
Ph: (306) 664 4131 info@saskegg.ca www.saskegg.ca
Board of Directors: Shawn Harman, Chair; Isaac Entz, Vice Chair; Directors: Regan Sloboshan, Danny Wollman, Shawn Colborn. Anstey Hatchery Ltd 2717 Cleveland Ave., Saskatoon, SK S7K 3R2
Ph: (306) 242 1033
Fax: (306) 242 6466
Turkey Farmers of Saskatchewan 3342 Millar Ave. #4, Saskatoon, SK S7K 7G9
Ph: (306) 931 1050
Fax: (306) 931 2825 www.saskturkey.com
Western Feed Industry Association (WFIA - ANAC - Alberta and Saskatchewan Division) #203, 4711 - 51 Ave, Red Deer, AB T4N 6H8
Ph: (403) 347 7877
Fax: (403) 309 1741 agrinet@telus.net www.anac-ab.ca
Krisjan Jones, Chair; Doug Durbano, Vice Chair; Jeff Nielsen, Past Chair; Darrell Kimmell, National Director; Directors: Nancy Fischer, Darryl Lewis, Tim Mugford, Tim Armstrong, Alin Friedt, Mike Robinson, John Stephen, Wilf Graf, Sharon Klinger. Brad Drechsler, Division Manager.
NATIONAL INDUSTRY ASSOCIATIONS
Agri-food Innovation Council
70 George Street, 3rd Floor, Ottawa, ON K1N 5V9
Ph: (613) 232-9459
Fax: (866) 851-5689 office@aic.ca www.aic.ca
Board of Directors: Julianne Curran, Chair. Directors: Tania Humphrey, Vice Chair; John M. Hyshka, Treasurer; Michael Trevan, Secretary; Directors: Rajasekaran Lada, Darcy Herauf, Karen Churchill.
Agriculture and Agri-Food Canada
1341 Baseline Rd., Ottawa, ON K1A 0C5
Ph: (613) 773-2600
Fax: (613) 773-1081
Toll Free: (855) 773-0241 aafc.info.aac@canada.ca
www.agr.gc.ca
Animal Nutrition Association of Canada (ANAC-Head Office)
150 Metcalfe St., Suite 1301, Ottawa, ON K2P 1P1
Ph: (613) 241-6421
Fax: (613) 241-7970 info@anacan.org www.anacan.org
Executive Director, Melissa Dumont; Director, Technical Services, My-Lien Bosch;
Canada-China Agriculture and Food Development Exchange Centre
150 Main St. W., Suite 1003, Hamilton, ON L8P 1H8
Ph: (416) 642-3890
www.ccagr.com
Canadian Animal Health Coalition
Ph: (519) 835-2233
info@animalhealth.ca www.animalhealth.ca
Canadian Animal Health Institute
160 Research Lane, Suite 102, Guelph, ON N1G 5B2
Ph: (519) 763-7777
Fax: (519) 763-7407
www.cahi-icsa.ca
Chair: Dr. Jair Garcia, Zoetis
Canada Inc; Vice-Chair: Dr. Rob Bell, Bio Agri Mix; Past Chair: Daniel Beauchamp, Merck Animal Health; Secretary-Treasurer; Katie Cook, Elanco Animal Health
Canadian Association of Poultry Veterinarians, CAPV-ACVA
www.capv-acva.ca
Executive Members: Dr. Neil Ambrose (West); Dr. Rachel Ouckama, (OAPP); Dr.Daniel Venne (AVIA).
Canadian Federation of Agriculture
21 Florence St., Ottawa, ON K2P
0W6
Ph: (613) 236-3633
Fax: (613) 236-5749
info@canadian-farmers.ca www.cfa-fca.ca
Mary Robinson, President; Keith Currie, Vice-President, CFA; Chris van den Heuvel, Second Vice-President, CFA. Kurt Siemens, Director, Egg Farmers of Canada; Nick Langelaar, Director, Chicken Farmers of Canada; Brian Ricker, Turkey Farmers of Canada; Gyslain Loyer, Canadian Hatching Egg Producers. Errol Halkai, Executive Director.
Canadian Food Inspection AgencyNational Headquarters 1400 Merivale Rd., Ottawa, ON K1A 0Y9
Ph: (613) 773-2342
Toll-Free: (800) 442-2342 www.inspection.gc.ca
Canadian Hatching Egg Producers 21 Florence St., Ottawa, ON K2P 0W6
Ph: (613) 232-3023
Fax: (613) 232-5241 info@chep-poic.ca www.chep-poic.ca
Brian Bilkes, Chair; Gyslain Loyer, Vice-Chair, Quebec; Dean Penner, Second Vice-Chair, Manitoba; Calvin Breukelman, British Columbia; Kevin Tiemstra, Alberta; Mike Wurtz, Saskatchewan; Mark Woods, Ontario; Christian Trottier, Canadian Hatchery Federation; Sunny Mak, Canadian Hatchery Federation
Canadian Poultry and Egg Processors Council 1545 Carling Ave., Suite 400, Ottawa, ON K1Z 8P9
Ph: (613) 724-6605 www.cpepc.ca
Jean-Michel Laurin, President/ CEO; Nicolas Paillat, Chicken/ Turkey/Hatchery; Erica Charlton, Plant Operations/Regulatory; Margo Ladouceur, Egg Sectors/ Events; Susan Mallet, Corporate Admin/Accounts; Nik Zylstra, Hatchies/Poultry FP
Canadian Poultry Research Council
225 Metcalfe St., Ottawa, ON K2P 1P9
Ph: (613) 714-4599
Fax: (613) 714-9885
Toll Free: (833) 888-1192 info@cp-rc.ca www.cp-rc.ca
Bruce Roberts, Executive Director. CPRC
Directors: Dr. Helen Anne Hudson, Chair (EFC); Rick Kaptein, Vice Chair (CFC); Erica Charlton (CPEPC); Vic Redekop (TFC); Jeff Notenbomer (CHEP)
Chicken Farmers of Canada 1610-50 O’Connor Street, Ottawa, ON K1P 6L2
Ph: (613) 241-2800
Fax: (613) 241-5999 www.chicken.ca/www.chickenfarmers.ca www.poulet.ca / www.producteursdepoulet.ca
Board of Directors: Benoît Fontaine, Chair (QC); Derek Janzen, 1st Vice-Chair (BC); Nick de Graaf, 2nd Vice-Chair (NS); Tim Klompmaker, Executive Member (ON). Directors: Ted Froese (MB), François Cloutier (QC), Marc Cormier (NB), Dennis Steinwand (AB), Nick Langelaar (SK), Barry Uyterlinde (PEI), Paul Dunphy (NL), Yvan Brodeur (CPEPC), Craig Evans (CPEPC), Don Kilimnik (FPPAC), Paolo DiManno (Restaurants Canada).
Egg Farmers of Canada
21 Florence St., Ottawa, ON K2P 0W6
Ph: (613) 238-2514
Fax: (613) 238-1967
info@eggs.ca
eggfarmers.ca / producteursdoeufs.ca
Board of Directors: Roger Pelissero, Chair; Glen Jennings, 1st Vice Chair (Atlantic); Emmanuel Destrijker, 2nd Vice Chair (Central); Walter Siemens, Executive Member (Western). Directors: Beatrice Visser (AB), Walter Siemens (BC), Kurt Siemens (MB), Hans Kristensen (NB), Joseph R. W. Smallwood III (NL), John Penner (NT), Glen Jennings (NS), Scott Brookshaw (ON), Ian Simmons (PE), Emmanuel Destrijker (QC), Regan Sloboshan (SK), Wayne Beggs (Consumers’ Association of Canada), Ted Hudson (CPEPC - Grading), Mike Vanderpol (CPEPC - Processing), Drew Corneil (CPEPC - Hatcheries). Tim Lambert, Chief Executive Officer. Farm Products Council of Canada Central Experimental Farm 960 Carling Ave., Building 59, Ottawa, ON K1A 0C6 Ph: (613) 759-1555
Fax: (613) 759-1566
Toll Free: (855) 611-1165 aafc.fpcc-cpac.aac@canada.ca www.fpcc-cpac.gc.ca
Turkey Farmers of Canada 7145 West Credit Ave., Bldg. 1, Suite 202 Mississauga, ON L5N 6J7 Ph: (905) 812-3140 Fax: (905) 812-9326 info@tfc-edc.ca www.turkeyfarmersofcanada.ca
Board of Directors: Darren Ference, Chair (AB); Calvin McBain, Vice Chair (QC); Brian Ricker, Executive Member (ON); Directors: Shawn Heppell (BC); Jelmer Wiersma (SK); Rachelle Brown (MB); Bertin Cyr (NB); Steven Eadie (NS); Doug Hart (CPEPC), Michel Pépin (CPEPC); Adam Power (FPPAC).
Egg Farmers of Canada
Egg Farmers of Canada (EFC) oversees the national egg supply, promotes egg consumption and develops standards for egg farming in Canada. This national organization represents more than 1,100 egg farmers in all ten provinces and the Northwest Territories, and works closely with egg boards, industry partners and government to ensure a strong and sustainable egg industry.
The Canadian egg industry operates under the system of supply management. By matching egg production with demand, Canadians have a constant supply of fresh, local, high-quality eggs and farmers receive a fair return.
For almost 50 years, supply management has helped egg farmers contribute to the Canadian economy through job creation and by supporting local businesses. In fact, Canada’s egg industry is responsible for over 18,500 jobs across the country and contributes $1.3 billion dollars to Canada’s GDP.
Over the past 15 years, Canadian egg production has witnessed impressive growth. In fact, egg production on Canadian farms has increased by 62% since 2004. A successful egg farming industry allows farmers to invest in Canadian communities and in innovation through on-farm programs and research and development.
EQA™ certification program
The Egg Quality Assurance™ certification program (EQA™) is the culmination of decades of work to implement and strengthen quality
assurance standards through the national Animal Care Program and Start Clean-Stay Clean® program. The first egg cartons carrying the certification mark are already available in stores, and dozens of restaurants, retail stores and industry partners have added their support to the program. Visit eggquality.ca to learn more.
Encouraging Canadians to eat eggs, anytime
The new Eggs Anytime campaign targets a segment of consumers known as light buyers of eggs, who enjoy fewer than a dozen eggs per month and represent close to 40% of Canadian households. The bold and funny ads are already captivating Canadians with their witty ‘It’s not weird’ tagline, and has reached millions of consumers with the message that eggs are a great choice for any meal, at any time.
Strengthening practices through evidence-based research
EFC’s robust research program sup -
ports innovation in the egg farming sector. Through the Research Grant Program, more than 39 research projects are currently underway at universities across Canada, covering priority areas ranging from animal care science to environmental sustainability and nutrition. EFC also supports a unique multidisciplinary Research Chair Network focused on economics, poultry welfare, sustainability and public policy, in addition to a broad range of research partnerships.
Supporting communities from coast to coast
EFC’s mission is to position the Canadian egg industry as a leader in Canada’s agricultural future through sustainable growth, continuous improvement and social responsibility. Their philanthropic work is driven by a vision of a world where everyone can enjoy the immeasurable benefits of the humble egg. Millions of eggs are donated every year in Canada and in other regions of the world through longstanding partnerships with Food Banks Canada, Breakfast Club of Canada, Heart for Africa (Canada) and Canadian Food For Children. These partnerships are a testament to the power of the humble egg and the strong commitment of Canadian egg farmers to give back. Under the leadership of Chair Roger Pelissero and with the dedication of a 16-member Board of Directors, EFC is known for its leadership and innovation. To learn more visit eggfarmers.ca and sign up for their newsletter, follow @eggsoeufs on Twitter or on LinkedIn and visit Facebook.com/eggsoeufs.



Together at the table
For decades, Egg Farmers of Canada has been proud to be part of a strong Canadian egg industry, representing the more than 1,100 egg farmers and farm families in all provinces and the Northwest Territories who produce fresh, local, high-quality eggs every day.
We may be apart, but we’re together at the table.


Board of Directors
Beatrice Visser AB
Walter Siemens BC
Kurt Siemens MB
Hans Kristensen NB
Joseph R. W. Smallwood III NL
John Penner NT
Glen Jennings NS
Scott Brookshaw ON
Ian Simmons PE
Emmanuel Destrijker QC
Regan Sloboshan SK
Wayne Beggs CAC
Ted Hudson CPEPC (Grading)
Mike Vanderpol CPEPC (Processing)
Drew Corneil CPEPC (Hatcheries)
Tim Lambert Chief Executive Officer
Roger Pelissero Chair
Chicken Farmers of Canada
Our Mandate
Chicken Farmers of Canada has two primary mandates. Our main responsibility is to ensure that our 2,800 farmers produce the right amount of fresh, safe, high-quality chicken to meet Canada’s needs. To do so, farmers, processors, further processors and members of the restaurant trade from across the country meet every eight weeks to decide, based on market demand, just how much chicken to raise. This evolving risk management system we operate under is commonly known as “supply management”. As part of the system, Chicken Farmers of Canada also monitors compliance with provincial quota allocations –making sure each province raises as much chicken as they agreed to – and the inter-provincial or market development trade of chicken. Established in 1978, Chicken Farmers of Canada was established under the provisions of, and receives its legal authority from, the Farm Products Agencies Act
Our second responsibility is to represent the interests of chicken farmers and the Canadian chicken industry. Chicken Farmers of Canada plays a key role in developing, partnering or managing programs for Canada’s chicken farmers that prove they continue to grow the fresh, high-quality chicken that Canadians trust. Through programs such as Raised by a Canadian Farmer On-Farm Food Safety, Animal Care, and Sustainability, and other biosecurity initiatives, Chicken Farmers of Canada works closely with govern-
Industry Snapshot
Sources: CFC, AAFC, CFIA, provincial boards, provincial ministries of Agriculture
2019 Quota Periods
ment partners and industry stakeholders to keep the industry innovative and responsive.
Through our government relations program, Chicken Farmers of Canada strives to ensure that key decision makers in government fully understand the views of Canada’s
farmers and that these are taken into account when important agriculture and trade policy decisions are made.
Our Board
Our directions and policies are determined by a 15-member Board of Directors comprised of farmers appointed by the provincial chicken marketing boards. Non-farmer directors – one from the restaurant industry, another from the further processing industry, and two representing the processing industry – are appointed by their respective national associations.
This way, Chicken Farmers of Canada and its stakeholders work together on behalf of Canada’s chicken industry, from farmer to consumer.
OUR VISION – (To be) Consumers’ preferred and trusted protein
OUR MISSION – To lead and grow a sustainable Canadian chicken industry, while strengthening trust and enhanching value for Canadians
Canadians want Canadian chicken, so we deliver them fresh, locally-raised food, just the way they like it. Our farmers are a stabilizing force in rural Canada, where they can – and do – reinvest with confidence in their communities, but their contribution is much wider. In sum, we are part of Canada’s economic solution, and do so without subsidies, and are very proud of both.
A driving force in the Canadian economy, the chicken sector’s 2,877 chicken farmers and 185 processors generate employment, wealth, and help sustain agricultural communities in every province across the country. Specifically, the sector:
• sustains 101,900 jobs
• contributes $8 billion to Canada’s Gross Domestic Product
• pays $1.9 billion in taxes (instead of seeking taxpayer money through subsidies)
• purchases 3 million tons of feed, supporting other farmers in turn People care deeply about their food, about knowing where it comes from and that what they’re serving to their family and friends is of the highest quality; our farmers and their families are no different. So when we say that the Canadian chicken industry is good for Canadians, it’s because we know that we’re raising our chickens to the highest standards: yours.
Turkey Farmers of Canada
Turkey Farmers of Canada (TFC) represents Canada’s 500+ turkey farmers. Created in 1974 under the federal Farm Products Agencies Act (FPAA), the Agency encourages cooperation throughout the Canadian turkey industry, promotes the consumption of turkey meat, and oversees the supply management system for turkey in Canada. Mandated by Federal Proclamation, TFC’s Board sets national turkey production levels in response to market activity and market forecasts, as well as expectations regarding imports and competing protein and input markets, to ensure that consumers have access to a secure supply of high-quality Canadian turkey products, and that farmers earn a fair return on their investments.
The Board provides direction to a national office staff and also makes decisions on matters such as research, on-farm food safety, flock care and the promotion of Canadian turkey, all in order to further promote a strong, efficient and competitive turkey production and marketing industry (as per S.21 of the FPAA)
The Canadian turkey industry generates $4.0 billion in economic activity annually, supporting over 16,000 jobs across rural and urban centres. TFC is underway in the second year, of a fully integrated five-year campaign called THINK TURKEY to raise awareness of the benefits of turkey and to increase turkey consumption across Canada. Learn more at www. turkeyfarmersofcanada.ca and www. canadianturkey.ca.
Turkey Farmers of Canada Stats 2020

Brian Bilkes, Chair
CANADIAN HATCHING EGG PRODUCERS
Founded in 1986, the Canadian Hatching Egg Producers (CHEP) represents 240 farmers from British Columbia, Alberta, Saskatchewan, Manitoba, Ontario and Quebec. CHEP is a national organization funded through farmer levies based on the broiler hatching eggs produced. Our Mission: Together with our partners and producers, CHEP ensures a dependable supply of quality broiler hatching eggs to Canadian hatcheries. Our Vision: A prosperous Canadian poultry sector, enabled by a strong and profitable broiler hatching egg industry. Our commitment extends to providing hatching eggs that meet the need of the Canadian marketplace while ensuring fair returns to our members and supporting stable, consistent and profitable growth for all stakeholders. CHEP is dedicated to animal welfare, is a leader in food safety initiatives and provides research grants to support continuous improvement in the industry. Canadian farmers produced more than 820 million hatching eggs in 2019.
Luc St-Hilaire, CEO CCT INC. For more than 30 years, CCT developed and produced all paper products needed by the poultry industry across Canada. (chick box, waffled pads, feeder roll, chick guard, chick tray) All of our products should be customized for your own application and they are 100 % biodegradable. We ship as required and in a timely manner directly to your doorstep. Also CCT is a converter who manufactured rolls, embossed paper and chipboard for your commercial and industrial packaging. Outstanding products for unique customer like you. Call us at 1-855-724-3846.
CHARISONS TURKEY HATCHERY LTD. has been supplying Western Canada with poults for over 65 years. We continue to work closely with producers to provide the quality poultry they are looking for. For more information, please call Jamie or Shane at 204-886-2922.
Benoît Fontaine, Chair CHICKEN FARMERS OF CANADA. Hailing from Stanbridge Station, Quebec, Benoît Fontaine, Chair of Chicken Farmers of Canada, first joined the Board of Directors in 2013 as an alternate and became the Quebec Director in 2014. He farms In the Lac Champlain area and raises chickens and turkeys. A former high school Canadian history teacher, and 2nd generation chicken farmer, Benoît has also been heavily Involved in the Union des producteurs agricoles since 1999. Benoît became Chair in 2016.
CHORE-TIME Chore-Time continues its tradition established in 1952 of leadership in the design, manufacture and marketing of equipment for poultry and egg production. With complete end-to-end systems for feeding, feed handling, drinking, egg handling, climate control and house management, Chore-Time is a market leader known for product performance, tailored solutions and a proven independent distribution network. Part of the CTB, Inc. family of companies, Chore-Time now offers a complete line of nests and aviaries for cage-free production. Chore-Time

operates globally from facilities in Indiana, Alabama, the Netherlands and Poland. For more information or to find your local distributor, see www.choretime.com. Find us on Facebook, Twitter, YouTube and LinkedIn.
CLARK AG SYSTEMS LTD. Clark Ag Systems Ltd. has been providing customers with high quality equipment for poultry and egg production for 70 years. Since then, the company has become a trusted supplier to farmers across Canada operating out of Caledonia, Ontario. Clark Ag Systems offers a complete line of production equipment that includes Tecno Poultry Equipment housing options; as well as feeding, watering, heating, ventilation, lighting, electronic monitoring and control systems. The professional and experienced staff at Clark Ag Systems constantly strives to achieve the highest standard for sales, installation and service including their partners across Canada and 24/7 emergency support. For more information please call 1.800.263.6410 or visit www.clarkagsystems.com



CORE CALCIUM AND SHELL PRODUCTS has been the leader in supplying Quality Shell Products to the Poultry and Feed industry for many years. Still located in Mobile, Alabama, the Sales and Management is headed by Ronnie McDonough. Ronnie has over 30 years’ experience in the business with the former Oyster Shell Products Company who owned plants in Baltimore, Maryland and Houston, Texas as well as Mobile. Core Calcium and Shell Products has carried on the process of production closely following the popular Pilot Brand Shell. Our current Coastal Brand Shell is also known as the Organic Choice. With the price of eggs today, Coastal Brand Shell as your Calcium source is more important than ever as any breakage at all can be very expensive. We have new facilities, which opened several years ago, and are looking for suppliers in areas including Western Canada. We have warehouse space, bagging, barge and ship loading and offloading capabilities. For more information contact us toll free at 1-877-679-1399.
COUNTY LINE EQUIPMENT LTD. We are a leading supplier for all aspects of poultry production equipment. Founded in 1998 Countyline has steadily grown based on a foundation of excellent products & service. We are located in Listowel, Ontario where we house over 30,000 sq. ft. of parts as well as components for new systems including feeding, watering, housing (cages & nests) lighting, heating, ventilation, and the latest in controller technology. Our experienced staff can assist with design & consultation of new projects as well as renovations. We take pride in our service department, which is fully staffed with licensed electricians & gasfitters and we offer 24hr service. Contact us today to learn more about our product lines or for help on your next project. Visit www.county-line.ca or by phone 1-800-4637622.



CUMBERLAND Cumberland is a world-class poultry equipment manufacturer offering a full line of proven and dependable solutions to maximize production returns for broiler, breeder and turkey producers around the world. Cumberland’s product offering includes feeding and watering systems, feed storage and delivery systems, ventilation equipment, heaters, cooling systems, controls and alarms, nesting equipment and more. Able to accommodate the needs of poultry production operations large and small, Cumberland delivers products engineered to outlast and outperform, service that doesn’t punch a clock, expertise that understands the industry inside and out and the vision to see what’s coming next. For more information visit cumberlandpoultry.com Cumberland is a part of GSI, a worldwide brand of AGCO.
EGG FARMERS OF ALBERTA Established in 1968, Egg Farmers of Alberta (EFA) represents Alberta’s 170+ registered egg farmers and works in close partnership with the Egg Famers of Canada (EFC), to provide Albertans with a stable supply of fresh, high quality, locally produced eggs and egg products.
Roger Pelissero, Chair EGG FARMERS OF CANADA Roger Pelissero is a third generation egg farmer from St. Ann’s, Ontario and Chair of the Egg Farmers of Canada Board of Directors. Prior to his appointment as Chair in 2017, Roger represented Ontario on the Egg Farmers of Canada Board of Directors. He has also served on numerous Board appointed committees including Executive, Cost of Production, Marketing and Nutrition, Service Fee and Production Management. He currently serves on the Egg Farmers of Ontario Board of Directors representing Zone 4 and has also served as a member of Egg Farmers of Ontario’s Executive Committee. As Director for Ontario’s Zone 4, Roger represents Ontario’s Counties of Brant and Haldimand and the regional municipalities of Hamilton-Wentworth and Niagara.
As a representative of Egg Farmers of Canada, Roger has appeared before the House of Commons Standing on Agriculture and Agri-Food and the Standing Senate Committee on Agriculture and Forestry to brief MPs and Senators on the egg industry’s activities and objectives. He is an advocate for evidence-based research that supports progress and innovation, and a member of the Egg Industry Center Board of Advisors of Iowa State University.
Roger has been farming with his family and wife Lorrie since 1984.
Roger Pelissero Président des Producteurs d’œufs du Canada
LES
PRODUCTEURS D’ŒUFS DU CANADA
Roger Pelissero est un producteur d’œufs de troisième génération de St Ann’s (Ontario) et président du Conseil d’administration Roger Pelissero est un producteur d’œufs de troisième génération de St Ann’s (Ontario) et président du Conseil d’administration des Producteurs d’œufs du Canada. Avant sa nomination à titre de président en 2017, Roger a représenté l’Ontario au
Conseil d’administration des Producteurs d’œufs du Canada. Il a également été membre de nombreux comités constitués par le Conseil d’administration notamment le comité exécutif ainsi que ceux du coût de production, du marketing et de nutrition, des frais de service et de la gestion de la production.
Il représente à l’heure actuelle au Conseil d’administration des Egg Farmers of Ontario la zone 4 et a également fait partie du comité exécutif des Egg Farmers of Ontario. À titre d’administrateur de la zone 4 de l’Ontario, Roger représente les comtés de Brant et Haldimand et les municipalités régionales de Hamilton-Wentworth et Niagara en Ontario.


À titre de représentant des Producteurs d’œufs du Canada, Roger a comparu devant le Comité permanent de l’agriculture et de l’agroalimentaire de la Chambre des communes et le Comité sénatorial permanent de l’agriculture et des forêts pour informer les députés et les sénateurs à propos des activités et des objectifs de l’industrie ovocole. Il préconise la recherche fondée sur des données probantes permettant d’appuyer le progrès et l’innovation, et est membre du comité consultatif de l’Egg Industry Center de l’Iowa State University. Roger travaille dans le secteur agricole avec sa famille et sa femme Lorrie depuis 1984.
Jeff Clarke, Chair
EGG FARMERS OF NOVA SCOTIA Jeff Clarke is Chair of Egg Farmers of Nova Scotia (EFNS) the organization that represents the province’s licensed egg and pullet farmers. Jeff was elected to the Board of Directors in 2017. In 2018, he was elected as Vice-Chair and as Chair in 2019. He serves on several committees within EFNS. Jeff is the fifth generation of Southview Farms, a family farm located in the Annapolis Valley, owned and operated by Jeff and his wife Kelly, their three children; Nicholas, Sophia, and Thomas. They raise 200,000 pullets and have 38,500 layers per year.
Scott Helps
EGG FARMERS OF ONTARIO Scott Helps is Chair of Egg Farmers of Ontario (EFO), an independent, self-governing association funded entirely by egg and pullet farmers. Newly elected as Chair of the Board in April 2020, Scott served as Vice-Chair from 2015-2020 and as a Board Director 2012 to present. As the Director for zone 1, he represents farmers in the Counties of Essex, Kent and Lambton. The Chair of EFO serves as the ex Officio on all Board Committees, including Executive, Egg Industry Advisory, Production Management, Finance, Pullet and Public Affairs. Scott also served as EFO’s representative to Egg Farmers of Canada.
EXACON INC. Exacon manufactures and distributes ventilation, heating, cooling, feeding, lighting and air filtering products across Canada. We provide a unique, single source, convenient one stop shopping approach. Brand Names offered include: MULTIFAN exhaust fans (vertical or horizontal mount), AGRIFAN exhaust fans (series “M” and “LP”), VARIFAN electronic controls, GENIUS electronic controls and the NEW ITOUCH control models with touch screen.



Exacon offers a full line of ventilation for the Agricultural, Commercial, Industrial and Horticultural markets consisting of exhaust fans, cooling products, circulation fans (including VOSTERMANS Greenhouse Fan and the NEW V-FloFan designed in Holland), MULTIFAN and J&D basket fans, inflation fans, electronic controls and LB WHITE heaters (Recov-aire and Avi-Air heat recovery ventilators). Exacon is constantly working to add and develop innovative products to maintain our leading edge. For more information call our office at 1-866-335-1431 or email: info@exacon.ca
FDI
POULTRY
EQUIPMENT
(FORD DICKISON 2000 INC.) For more than 50 years, FDI has offered a full line of Canadian manufactured poultry equipment ranging from enriched layer and pullet batteries and aviaries, manure and egg conveyance, to specialty systems for quail, rabbits, research farms, colleges and universities. As Canada’s only full line poultry equipment manufacturer, we have a continued devotion to meet the requirements of our customers around the world. We are committed to the constant improvement of our equipment and in charge of the quality of our products from start to finish.
G.MCFEETERS Premium Wood Shavings. Since 1959 Mcfeeters Enterprises has been supplying the highest quality wood shavings to the animal bedding markets. We formulate our shavings with the optimal ratio of fines and flakes. As a fully integrated company, we source all raw materials, transport, package, and arrange for delivery to end markets of all our products. This allows us to provide premium products on a consistent and timely year-round basis.
GLASS-PAC Glass-Pac designs and manufactures fibreglass exhaust fans and air inlet systems and also represents a quality line of poultry products from ROXELL - feeding systems, LUBINGdrinking systems, FANCOM - ventilation controls, feed weighing/blending systems, live bird weighing systems, HIRED-HAND - super saver heaters, BRANT RADIANT tube heaters and DELTA TUBE hot water heating. Glass-Pac also offers various breeder nesting systems and more. Our products are sold direct with full design, installation, training and support made available.
GRAND
VALLEY FORTIFIERS Grand Valley Fortifiers specializes in the formulation, manufacturing and sale of high-quality animal nutrition products and has established itself as a significant force in the Canadian premix industry. GVF is also a leader in niche market research and product development to improve animal health and production while reducing producers’ costs. We’re committed to providing on-farm support and expertise aimed at improving production and the producer’s bottom line. To learn more about unique GVF Poultry Feeds, Premixes and opportunities, connect with Ryan Snyder, GVF Poultry Production Improvement Specialist, 519-7785377.

HELLMANN offers a diversified range of products for all layer and pullet producers, including traditional, enrichable and fully enriched systems, as well as alternative free run, free range and bio systems for both layers and pullets. Each system can be designed with a choice of multiple tier heights and depths. Additionally, Hellmann layer systems can be equipped with a choice of egg elevator or egg lift collection systems. Hellmann has nationwide sales, parts and services to support over 300 customers. The company continues to innovate to world-class layer, pullet and alternative housing. For more information on Hellmann GmbH, please visit www.hellmannpoultry.com or call our toll free number 1-800-894-4082.



HOG SLAT For more than 50 years, Hog Slat has been North America’s leader in providing producers with cost-effective production equipment. From our location in Mitchell, ON, we stock and service a full line of poultry products, including LB White heaters, Cumberland drinkers, Dosatron medicators, and Hellmann nesting equipment as well as Hog Slat’s exclusive GrowerSELECT ventilation and feeding equipment. Hog Slat engineers, manufacturers, and distributes GrowerSELECT products directly to farmers to ensure the best possible price to the end user. The GrowerSELECT ventilation lineup consists of AirStorm fiberglass fans, Windstorm circulation fans, curtain and inlet controllers, tunnel doors, and ceiling inlets. Hog Slat bulk bins and flexible augers complete the feed system highlighted by our Classic Flood, Classic Pullet, and Adult Turkey pan feeders. Give us a call today at 519/348-8483 for a quote on your next new or remodeling project.
JANSEN POULTRY EQUIPMENT established in 1984 and present in Canada since 1989, manufacturers of mechanical nests for broiler breeders, commercial layers, layer breeders, egg conveyors and elevators. Hatching packers for any type of incubator are also available from JANSEN POULTRY EQUIPMENT. Slatted floor housing, cage-free rearing systems, aviaries for commercial layers and manure dryers are also manufactured by JANSEN POULTRY EQUIPMENT. For more information: call (646) 931 1987 or mail: canada@jpe.org
JENI MOBILE WASH since 1986 we have been serving the poultry community, our commitment and dedication to “OUR” industry continues. We provide an honest, top quality, reliable, barn washing and disinfecting service to S.W. Ontario. Barn washing is our SPECIALTY. We are safety conscious and WSIB compliant. Well-trained crews to match any size operation. We have 8 trucks to serve you better, so you can always count on our reliability. We carry effective, quality disinfectants to complement your biosecurity requirements. We continue to focus on biosecurity as an integral part of our service to you. We at JENI MOBILE WASH know that quality and service do make the difference. Head office: 1-800-361-3637 or 519843-2672, jmw@wightman.ca, www.jenimobile. com

KAISER AG SOLUTIONS LTD. Kaiser Poultry Systems is a Canadian based full service poultry equipment manufacturing, designing and servicing company. We offer equipment for all styles of systems; free-run, free-range, organic, enriched and pullet. We are excited to announce that all of our poultry housing systems are Canadian based, and now offer custom design and manufacturing services! KPS also sells and services associated poultry equipment such as egg packers, farm controls, ventilation inlets and fans. For more information please see our website www.kaiserpoultry. com
LUBING With more than 70 years of experience developing innovative products for poultry producers worldwide, Lubing has established a reputation as one of the most technologically advanced companies in the poultry industry. Our concentrated efforts in developing new technologies for nipple drinking systems, egg conveying systems and high pressure fogging systems have allowed us to specialize our knowledge and produce the most innovative products in the marketplace. Got Lubing? For information on our cutting-edge poultry products, please call 423-709-1000, use our toll-free fax line 1-866-289-3237, write to info@lubingusa.com or visit www.lubingusa.com
RUBY360 LTD. “With roots dating back to 1947, Ruby360 is a provider of integrated agricultural solutions across Canada and the USA. We have strong relationships with the manufacturers we represent from North America and Europe to offer highly efficient, durable products. Ruby360 is dedicated as your partner to provide innovative solutions specific to your needs. Ruby360 manufactures control panels in-house, as well as a distributor of Salmet poultry equipment, Once lighting, Munters ventilation, Opticon Agri-Systems agri-controls and renewable energy solutions. For more information or to find your local Ruby360 representative visit our website ruby360.ca or call us at 1-888- 218-7829.”
Martin Kanehl
SPECHT-CANADA sells German-manufactured Specht laying, pullet, breeder, aviary cages and floor nest systems. Our cages are of high quality and animal-welfare friendly. We can customize to suit our client’s needs, with options available for egg gathering, manure drying and ventilation. Specht-Canada supplies equipment for broiler, breeders, turkey and duck barns. Installation and ongoing service by trained personnel. Contact us at martin@spechtcanada.com
SUNRISE HATCHERY Family owned layer hatchery supplying Western Canada with Shaver White, Bovans, Dekalb and ISA from breeders in secure Alberta locations. Our bio-secure hatchery is designed to supply all the western provinces from Manitoba to British Columbia. Sunrise Hatchery offers combined experience in breeders, layers and hatching that total over 68 years. We help producers achieve better margins! 1-877-534-4676

SUREFOOT SLAT SYSTEMS Importing exotic hardwood from Asian countries, Surefoot continues to excel as the most popular slat for the Canadian Broiler Breeder farm, and now becoming the most popular choice for the “Cage Free Layer.” Top quality and service remain the priority of Surefoot since 1990 and we are still going strong after 25 years. We provide farmers a flooring system that is strong, clean and easy to install. Our product is sold direct and designed specifically to meet the needs of each individual producer. More and more farmers across this country are realizing full satisfaction because of Surefoot Slat Systems. Call Surefoot toll free in Canada and USA at 1-877-57-FARM (3276), email: dennis@ surefootslats.com.
TPI-POLYTECHNIEK TPI-Polytechniek is supplier of polyurethane components for agricultural ventilation systems. Our complete program is produced in our own production facilities in Poland. The used polyurethane is a strong and durable material which assures optimum insulation. Our product line is constantly in development and adjusted to follow the market developments and meet customer needs. A pro-active and experienced sales team assures fast and adequate sales support and a market conform stock management guarantees short delivery-times.



VAL-CO is a leading manufacturer of production equipment for poultry and egg Industries, creating new and exciting products based on innovative thinking, technical research, and field experience. By controlling the manufacture of all the components, VAL-CO engineers its products to work together as complete systems, where compatibility is not only preferred but essential. In addition to its North American facilities and extensive dealer network, VAL-Co maintains manufacturing, sales, and support operations in Europe, Asia, India, and South America. VAL-CO practices its corporate commitment - Performance You Can Count On - through a relentless pursuit of knowledge, continuous improvement, excellent field representation, and the production and distribution of the highest quality products in the industry. VAL-CO prides itself in driving Innovation through product development, providing its customers with premier next generation products and systems that help to ensure success in poultry and egg production operations. Over 255 combined years of industry knowledge and corporate history, a worldwide presence, and a commitment to providing leading products and technical support make VAL-CO a key business partner, whose performance you can count on.
WEBER’S FABRICATING
LTD. Weber’s Fabricating is a family owned business, which started manufacturing Live Turkey Loaders in 1970. Clare grew up on a turkey farm and he has first hand knowledge of the turkey business. Today we offer the traditional slider model as well as a telescoping model in either a single or 2 storey. We are a custom job shop and can probably build it if you can think of it. We would be pleased to quote on your needs. Contact us at (519) 6643711 or email Scott Weber, sweber@webersfab.ca















Barn Spotlight
Brenelm Farms
Sector: Broilers
Location: Tavistock, Ont.
The business
Brenelm Farms is a mixed operation based in Tavistock in southwestern Ontario. Run by the Wilhelm family, the business includes broilers, cash crops and, until recently, a hog operation.
The need
Last September, the Wilhelms had a sow barn fire. They took that moment to reflect on the future of their farm. “We decided the next generation didn’t like the hog business as much as me,” says Jim Wilhelm. The sow barn site wasn’t salvageable as land to grow crops on. Thus, they decided to build their fifth broiler barn there instead.
The
barn
The Wilhelms worked with Weeden Environments on a 128 ft. by 268 ft. double wide, tunnel ventilated barn with cool cells. The producers already had two barns with tunnel ventilation and cool cells and found it worked well. “We will get anywhere from a seven to 10°C temperature drop on them,” says Wilhelm about cool cells, which use evaporation to naturally cool barns and reduce heat stress. To ensure the openings were sealed as tightly as possible, they installed hydraulic doors. They’ve also seen other producers with double wide buildings and figured they could reduce energy costs by brooding in half the barn. What’s more, with a new Maximus system they’re able to monitor important metrics like voltage to ground to proactively prevent problems like another barn fire from occurring.
Barn Spotlight highlights new and renovated barns and hatcheries. Do you know of a good candidate to be featured? Let us know at poultry@annexweb.com.





Maximus Controls allow for complete, independent control of both sides of the barn.
The barn includes Valco 14” Fuze feeders and Valco drinkers with cups.
Valco Cool Cells with sufficient air speed from 72” fans will keep birds comfortable during extreme heat stress. Hydraulic covers are being installed for winter protection of the Cool Cells




